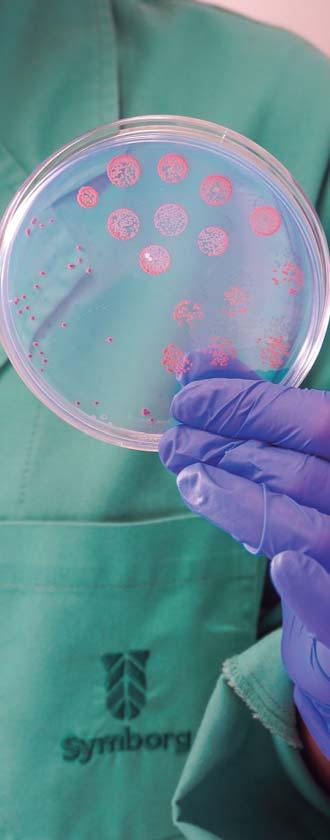

THE POWER OF GREAT TASTE




EDITA:
Laméyer S.L.
DIRECCIÓN:
Amalia del Río Laméyer
REDACCIÓN:
Alicia Lozano, Isabel Fernández y Fernando Perea
PRODUCCIÓN EMPRESAS:
Alicia Lozano, Isabel Fernández y Fernando Perea
ADMINISTRACIÓN:
Jorge Cobos
FOTOGRAFÍA DE PORTADA: ORRI RUNNING COMMITTEE (ORC)
FOTOGRAFÍAS INTERIORES:
Laméyer S.L. y otros
TRADUCCIÓN:
Álvaro Rubio
DISEÑO PROYECTO:
Jordi Villafranca Baldrich typorvila.com
MAQUETACIÓN:
Jordi Villafranca Baldrich
Sergi Mañà Alvarez
REDACCIÓN Y ADMINISTRACIÓN: Presidente Cárdenas, Nº 10. Local H. 41013 Sevilla.
Teléfono: 954 25 88 51
Fax: 954 25 19 94
E-mail: redaccion@revistamercados.com www.revistamercados.com
FILMACIÓN E IMPRESIÓN:
Dep. Legal: SE - 917 - 1994.
La editora no se hace responsable de los tiene porqué compartirlos. Se prohíbe la reproducción total o parcial de los artículos publicados.

Iniciamos este 2023, en el que la incertidumbre y crisis que ha dejado atrás 2022 le auguran un tiempo aún más complicado y con muchos frentes abiertos, pero, sobre todo, cambios constantes a los que enfrentarse.
Desde Mercados comenzamos el año con nuestro anuario y especial de Fruit Logística, donde hemos querido recoger todas las tendencias y retos que no pueden quedar relegados ante la situación que vivimos, de manos de grandes líderes, investigadores, economistas y profesionales del sector. Hablamos del cambio climático, la transformación digital y tecnológica o la sostenibilidad, cuestiones que van a marcar el futuro del sector en los próximos años.
Con todo ello, pretendemos que este sea consciente de su gran potencial y dinamismo, que le servirán para poder hacer frente a estos retos del día a día.
Las soluciones a estos desafíos pueden estructurarse en tres ejes, según la Asociación Española de Economía Agroalimentaria: la innovación y la digitación, el marketing y, por último, la cooperación, que nos llevarán a tener herramientas para ser más competitivos en los mercados y diferenciarnos de nuestros competidores.
We begin this 2023, to which the uncertainty and crisis that 2022 has left behind, augurs an even more complicated year and with many open fronts, but, above all, constant changes to be faced.
At Mercados we are starting the year with our yearbook and Fruit Logística special, in which we wanted to collect all the trends and challenges that cannot be left behind in the current situation, from the hands of great leaders, researchers, economists and professionals in the sector. We are talking about climate change, digital and technological transformation or sustainability, issues that will mark the future of the sector in the coming years.
With all of this, we want the sector to be aware of its great potential and dynamism, which will help it to face these day-to-day challenges.
The solutions to these challenges that we face can be structured around three axes, according to the Spanish Agri-Food Economy Association: innovation and digitaliwhich will lead us to have tools to be more competitive in the markets and differentiate ourselves from our competitors.
RevistaMercados (Facebook)
@AmaliadelRiol/@RevistaMercados (Twitter)
No dejen de leer los más de 30 artículos que plasmamos en este número y que le otorgan un valor importante, pues pueden ayudarles a encontrar soluciones en un año que se vaticina complicado y, como hemos dicho al principio, con mucha incertidumbre. Un 2023 en el que el consumidor tendrá un papel muy importante, ya que no ha podido evitar ser víctima de este escenario inflacionista y, por ello, no podemos dejarlo de lado, ya que es nuestro con precios justos a la población. ¡Nos vemos en Fruit Logistica!
Be sure to read the more than 30 articles in this issue and that give it significant value, as it can help you find solutions in a year that is predicted to be complicated and, as we said at the beginning, full of uncertainty. A 2023 in which the consumer will play a very important role, since it has not been able to avoid being a victim of this inflationary scenario and, therefore, we cannot leave it aside, since it is our ultimate goal to feed the population in a healthy way with fair prices. See you at Fruit Logística!









MIRANDO AL FUTURO VÍCTOR JOSÉ AYLLÓN AGUILERA, DIRECTOR COMERCIAL DE FRUTA Y VERDURA DE CARREFOUR ESPAÑA
La necesidad de reinventarse
The need to reinvent the business


8. ACTUALIDAD ORRI ORRI, la mandarina de récord





76. ANÁLISIS DEL SECTOR
El reto de producir en tiempos convulsos
81. TOP 15 EMPRESAS DEL SECTOR MELÓN Y SANDIA
TOP 15 Melon and watermelon producers
86. ANÁLISIS CÍTRICOS
Menos puede ser más
91. TOP 15 EMPRESAS DEL SECTOR CÍTRICOS
TOP 15 Citrus producers
95. TOP 15 EMPRESAS DEL SECTOR BERRIES
TOP 15 Berries producers
97. TOP 15 EMPRESAS DEL SECTOR TROPICALES


TOP 15 Tropical fruit producers
PERSONALIDADES
JANUSZ WOJCIECHOWSKI, COMISARIO DE AGRICULTURA DE LA UNIÓN EUROPEA.


“No dejaremos solos a los productores de frutas y hortalizas”

“We will not leave the fresh producers alone”
MIRANDO AL FUTURO RAÚL CALLEJA, DIRECTOR DEL ÁREA DE DIGITALIZACIÓN Y DIVERSIFICACIÓN DE NEGOCIO DE IFEMA
¿Metaverso e industria alimentaria? Metaverse and food industry?



104. ANÁLISIS PIMIENTO
El futuro del pimiento pasa por las resistencias
109. TOP 15 EMPRESAS DEL SECTOR TOMATE
TOP 15 Tomato producers
112. ANÁLISIS PATATA
Viento de cola para la patata española
114. ANÁLISIS IV Y V GAMA

Mientras haya valor añadido, habrá consumo
MIRANDO AL FUTURO EDUARDO BAAMONDE, PRESIDENTE DE CAJAMAR
Los retos ineludibles de las frutas y hortalizas españolas
The inescapable challenges of the spanish fruit and vegetables
MIRANDO AL FUTURO ENRIQUE DE LOS RÍOS PORRAS, DIRECTOR GENERAL DE UNICA. Nos hace falta más cooperación We need more cooperation 117
QUIÉN ES QUIÉN 2023. WHO IS WHO 2023

Directorio de empresas hortofrutícolas

Fruit & Veg Business Directory















RANKING DE EMPRESAS Business Ranking

Orri da el pistoletazo de salida a la temporada 2022-23 con una gran expectación, fruto del apoyo a agricultores y a fruteros que desde la asociación de productores de esta mandarina (Orri Running Committee, ORC) se viene realizando mediante las campañas de promoción dirigidas a los consumidores. Campañas que destacan por su imagen fresca y actual, y porque permiten dar a conocer entre los consumidores el original sabor de esta mandarina.
Tras un 2022 en el que Orri logró una producción récord, un 25% mayor que en la campaña anterior, para la presente 202223, se espera que vuelva a ser, un año más, la mandarina más cotizada del mercado.
inconfundible, completamente diferente al resto de mandarinas y que hace que el que la prueba repita; como entre los fruteros, que valoran muy positivamente las campañas de apoyo que realizan desde la asociación de productores ORC, puesto que les ayudan a mejorar sus ventas.

La mandarina Orri levanta una gran expectación ante el comienzo de la nueva temporada 2022-23, un año en que se espera una alta demanda gracias a las espectaculares campañas de promoción y su excepcional sabor.
hecho uso de su OrriApp, una innovadora tecnología informática aplicada al control de variedades vegetales protegidas que permite
en tiempo real, así como también de drones de última generación.
En los últimos años, The Enforcement Organization, S.L. (TEO), licenciatario máster de
Otro aspecto que convierte a Orri en una mandarina de récord es su extraordinaria capacidad de conservación de manera natural, que se pudo comprobar el año pasado, en el que coincidió una gran producción de cítricos con lluvias en marzo que alteraron la recolección habitual y que ralentizaron su comercialización, de modo que la temporada de Orri se alargó de enero hasta junio con fruta de una excepcional calidad.
LA MIRADA SOBRE 2023
Fruto de ello, recientemente, ha localizado más de 10.000 plantas ilegales de Orri en una explotación de Murcia. Para ello, ha
Por tercera temporada consecutiva, deporte como patrocinador del Valencia Basket Club tras haber prologando su relación gracias al fruto del trabajo conjunto. El presidente de ORC, Álvaro Peyró, ha manifestado que valores compartidos como la cultura del esfuerzo y un mismo color mantienen unidos a Orri y al Valencia Basket.
Gracias a esta alianza, las mandarinas Orri cuentan con espacio publicitario en los partidos tanto masculinos como femeninos del equipo (en publicidad estática, las pantallas
parte, las plantillas profesionales y el alumnado de las escuelas del Valencia Basket podrán saborear y complementar su nutrición con estas buenísimas mandarinas.
la variedad en España y Portugal, ha iniciado un total de 148 acciones legales por explotación ilegal de la mandarina Orri. En total, alrededor de 200 hectáreas (más de 90.000 árboles) se han visto afectadas.
Asimismo, las tareas de supervisión también se han implementado en los puntos de venta
visitaron más de 500 tiendas en toda España, con especial presencia en Madrid, Barcelona, Bilbao y Zaragoza, donde se comprobaron más de 1.000 muestras de fruta Orri.




Si por algo destaca ORC es, sin duda, por su plena dedicación a cada uno de los integrantes de la cadena de valor: agricultores, comercializadores y consumidores. ORC se muestra satisfecho ante el mantenimiento de los fuertes retornos a los productores, así como por el gran éxito de penetración en los lineales de los supermercados y en los comercios minoristas, en aumento con respecto a campañas anteriores.
En este sentido, la temporada 2022-23 pondrá el foco sobre el consumidor
través de sus campañas de marketing. Para ello, la mandarina Orri aumentará su visibilidad en el mercado minorista, dando apoyo, a su vez, a fruterías y
esta temporada es superar su presen-
cia en más de 8.000 puntos de venta por todo el territorio español a través de una campaña informativa basada en la asistencia directa y personal en los establecimientos que comercialicen la fruta, para que el consumidor pueda conocer de primera mano la frescura y sabor de la mandarina Orri.



Pero esta no será la única manera de llegar al público. Como novedad este año, todos aquellos fruteros que den visibilidad en su local a los materiales
de Orri podrán participar en un concurso en el que podrán ganar sorprendentes premios. En paralelo, los consumidores que compren Orri en estos puntos de venta optarán a otro premio. Toda la información estará a disposición de los consumidores en los puntos de venta adheridos a la campaña.
El arándano Royal Blu Aroma® de la empresa sevillana Royal ha sido reconocido por su sabor extraordinario con la distinción Sabor del Año 2023 en España y Francia, un galardón concedido a aquellos productos que cuentan con las mejores propiedades gustativas del mercado.
Royal Blu Aroma® es el resultado del intenso trabajo de investigación desarrollado por la empresa sevillana a lo largo de los últimos
quince años, en el que su objetivo siempre ha sido conseguir el mejor producto para los consumidores. Ha sido un proceso que toma el aroma y el sabor como elementos distintivos de unas variedades únicas, que se han convertido en el producto estrella de Royal.

En la actualidad, la producción de arándanos de la premiada variedad representa el 85% del total del volumen de distribución de la empresa. Su campaña transcurre de octubre a junio y Royal obtiene un volumen propio de alrededor de 13 millones de kilos.
Sabor del Año es un reconocimiento que pone premiado por las cualidades gustativas que Royal Blu Aroma® ofrece al mercado. Cualidades basadas en el sabor, aroma, aspecto, olor, textura y satisfacción, probadas y aprobadas por los consumidores. Distinción que impulsa el incremento en el consumo de arándanos
y frutos rojos, no solo en los países nórdicos, sino en todo el territorio europeo.
La variedad Royal Blu Aroma® de Royal es un producto con reconocido sabor y aroma que puede encontrarse en el mercado de manera continuada durante más de ocho meses, que parte del extraordinario trabajo llevado a cabo por Royal para llegar a diferentes hogares en más de 27 países distintos.


Este es el objetivo de Koppert, que acaba de lanzar sus ‘Packs de Biodiversidad’, lotes de distintas especies de plantas idóneas para crear zonas reservorios dentro y fuera del invernadero que contribuyen al control del pulgón, entre otras plagas.
Koppert ha iniciado la comercialización de varios lotes con diferentes especies de plantas idóneas tanto para la creación de zonas reservorio en invernaderos y cultivos de interior como para desarrollar setos vegetales en exteriores. Para la confección de estos lotes se han seleccionado las especies de plantas que mejor se adaptan en cada caso, con el objetivo de poder combinarlas en función de las necesidades de cada cultivo y asegurar que haya floración durante todo el año.
Con este lanzamiento comercial, Koppert facilita a los productores la creación en sus cultivos de zonas de biodiversidad capaces de mantener poblaciones permanentes de enemigos naturales. De este modo, se fomenta el control biológico de plagas por conservación, gracias a la existencia de estos ecosistemas en miniatura donde los
reproducirse durante todo el ciclo del cultivo comercial.
ESPECIES SELECCIONADAS
Para los lotes de plantas reservorio de interior, Koppert ha seleccionado 11 especies: milenrama, eneldo, cilantro, hinojo, aliso de mar, ruda de bola, ruda, salvia, hierba de Santa Luisa, tagete y estátice. Para los lotes de exterior, se han seleccionado diferentes plantas aromáticas de porte bajo, medio y alto: cuernecillo de mar, tomillo, romero, lavanda, ruda y adelfa.
Estos lotes, comercialmente denominados ‘Packs de Biodiversidad’, contienen bandejas de diferentes medidas (140 o 108 alveolos) con las especies vegetales listas para plantar. El Departamento Técnico de Koppert ofrece asesoramiento previo para
determinar las especies más adecuadas que debe contener cada lote, así como la colocación, fecha de siembra y el número total de plantas por hectárea (si es reservorio interior) o de metros lineales (si es un seto vegetal en exterior).
Además de estos ‘Packs de Biodiversidad’, Koppert también comercializa una bandeja de 104 alveolos con Tagete tenuifolia, una bandeja de 54 alveolos de Lobularia marítima y una caja con 15 macetas también de Lobularia marítima.

AUSENCIA DE SETOS VEGETALES Y RESERVORIOS REDUCE LAS POSIBILIDADES DE SUPERVIVENCIA DE LOS DEPREDADORES NATURALES DEL PULGÓN
La escasez de setos vegetales y reservorios es una de las causas que está impulsando el crecimiento del pulgón en zonas como Almería y la costa de Granada. “Los depredadores naturales del pulgón necesitan polen para ser fértiles y poder reproducirse, a la vez que néctar para moverse y ser activos. Por otra parte, las avispas parasitoides necesitan néctar de las flores para volar”, explica Julián Giner, director técnico de Koppert en Almería, quien recuerda que “ningún depredador come pulgón en estado adulto, salvo los coccinélidos (mariquitas) y el Orius majusculus”.
La ausencia de setos vegetales y reservorios reduce enormemente las posibilidades de supervivencia de los depredadores naturales del pulgón, especialmente cuando el cultivo comercial no les ofrece ni el polen ni el néctar que necesitan para reproducirse. “Si no pueden reproducirse no aparecen larvas, que son las que depredan, y el pulgón campa a sus anchas”, aclara Giner. Los lotes de plantas que comercializa Koppert sirven para fomentar las islas de biodiversidad y aumentar la protección biológica de los cultivos.
La cooperativa granadina, especialista en espárrago verde y vegetales de calidad, Cosafra, se promocionará en la cita internacional del sector hortofrutícola, Fruit Logistica, con importantes novedades para sus clientes y consumidores europeos.

En constante evolución, las expectativas de Cosafra para esta próxima campaña de espárrago verde apuntan a un crecimiento del 15% en producción, siempre que la climatología acompañe, con una previsión de cosecha de 2 millones de kilos. Más de seis décadas de experiencia, la profesionalidad de sus agricultores y los continuos esfuerzos por ofrecer el mejor espárrago verde a los consumidores permiten a esta cooperativa ofrecer un producto con sabor diferencial, frescura, abundantes propiedades nutricionales y carácter sostenible.
La otra gran novedad de la empresa para este año se ha conseguido tras muchos meses de trabajo, la optimización de procesos agronómicos, además de la renovación en sus instalaciones para dotarlas de máxima
a sus clientes, Cosafra ha adaptado su estructura corporativa para conseguir el máxi-
conocimientos que reforzarán su presencia en el mercado internacional.
“En un mercado tan competitivo, decidimos apostar por la diferenciación y por conseguir
cadena de producción de nuestros vegetales”, señala Javier Trujillo, presidente de esta cooperativa compuesta por 500 agricultores, cuyas explotaciones se encuentran en el término municipal de Huétor-Tájar, zona de referencia en la producción de espárrago verde.
Además de esta hortaliza, Cosafra produce y comercializa otros vegetales durante todo el año como exquisitas alcachofas, carnosas y con un sabor potente, además de patatas con una textura crujiente muy diferencial y sandías en temporada de verano. La empresa comercializa sus vegetales con marca propia en el

durante la campaña y adaptando sus formatos a las preferencias de los consumidores.
En Fruit Logistica, el equipo comercial, encabezado por su presidente, Javier Trujillo, se reunirá con clientes internacionales del 8 al 10 de febrero en el Hall 10 de Messe Berlín, stand A06. Un encuentro de negocios apasionante
ción para la campaña de primavera y buscará nuevas oportunidades de negocio, siempre pensando en la rentabilidad y el desarrollo de sus agricultores.
La compañía participa en una nueva edición de Fruit Logistica, donde mostrará sus novedades y realizará el lanzamiento de Citrashine N Pyr, el primer y único recubrimiento del mercado con autorización para incluir el pirimetanil en su matriz.

Decco, como empresa líder mundial en servicio postcosecha para frutas y verduras, estará presente en el stand A-80, Hall 8.2. de Fruit Logistica con el objetivo de dar a conocer sus últimas novedades y su renovada imagen corporativa. Para la compañía, esta feria es el mejor fórum para exponer su nuevo propósito ‘Más y Mejor Fruta Fresca para el mundo’, aportando la experiencia que le dan los casi 90 años al servicio del sector hortofrutícola a nivel mundial.
 Francisco Rodríguez, President and CEO
Francisco Rodríguez, President and CEO
“como empresa líder mundial en postcosecha, nos presentamos en Fruit Logistica junto a UPL para reforzar nuestra misión para con el sector agroalimentario de reducir el desperdicio alimentario y construir una agricultura más sostenible”. En este sentido, explica que “nuestros equipos presentes en más de 40 países trabajan en estrecha colaboración con productores locales y exportadores, aportando las mejores soluciones para cada cultivo y necesidad del mercado desde hace casi 90 años, y lo seguiremos haciendo muchos años más”.
Decco, reconocida por sus soluciones postcosecha para cítricos a nivel mundial, presenta en Fruit Logistica sus novedades en una diversidad de cultivos. Desde soluciones biológicas para la conservación en cámara de manzana, a su amplio porfolio para la exportación de frutas tropicales, o el lanzamiento de la Citrashine N Pyr, el primer y único recubrimiento del mercado con autorización para incluir el pirimetanil en su matriz… Y muchas otras innovaciones.
LLEGAMOS A LA FERIA JUNTO A
UPL PARA REFORZAR NUESTRA
MISIÓN DE REDUCIR EL
DESPERDICIO ALIMENTARIO Y CONSTRUIR UNA AGRICULTURA MÁS SOSTENIBLE
Los representantes de Decco mostrarán su gama completa de soluciones para proteger la frescura, preservar la calidad y dar la garantía de seguridad alimentaria a lo largo de la cadena de valor de productos frescos.
En palabras de Miguel Sanchis, General Manager de Decco Ibérica, “la visión holística de toda la cadena agroalimentaria que aporta Decco hace que las soluciones repercutan mucho más allá del almacén, afectando positivamente a todos los puntos de la cadena agroalimentaria, desde el campo hasta la mesa del consumidor”.
Para Claudio Torrisi, General Manager de Decco AMEA, “Fruit Logistica, en Berlín, consolidada como un punto de encuentro de los más importantes del sector hortofrutícola, supone una gran oportunidad para conectar con nuestros colegas y clientes de todo el mundo, así como poner en común descubrimientos y avances que redundan en poder proveer de un mejor servicio postcosecha”.

Los objetivos del Green Deal se establecieron antes de la situación derivada de la guerra en Ucrania. ¿No cree que el desarrollo de los productores va a dificultarse aún más teniendo en cuenta el contexto? ¿Es posible un retraso?
Me gustaría comenzar elogiando a los agricultores europeos y su trabajo. Antes de que Rusia comenzara su guerra en Ucrania, tuvieron que capear la pandemia del COVID y sus interrupciones de suministro a las cadenas de supermercados. Sin embargo, mostraron una gran resiliencia y la Unión Europea nunca sufrió desabastecimiento alimenticio. No debemos dar por sentada la disponibilidad de alimentos, pero gracias al apoyo de la PAC y al trabajo de los agricultores, no está en riesgo en la UE.
El 23 de marzo, menos de un mes después del inicio de la guerra, presenté un comunicado sobre seguridad alimentaria. Actuamos rápido. Está claro que la sostenibilidad y la seguridad alimentaria no son opuestas, van de la mano. La guerra puso de manifiesto una serie de vulnerabilidades del sistema alimentario de la UE, como su dependencia de la energía y los insumos importados, que debían abordarse. En términos prácticos, adoptamos un plan de apoyo de emergencia
Janusz Wojciechowski, comisario de Agricultura de la Unión Europea, analiza cómo el Viejo Continente afronta un contexto inflacionista post- COVID marcado por la sostenibilidad que quiere impulsar Bruselas y unos productos básicos cada vez menos accesibles para la población.

para la mayoría de los agricultores afectados. Pedimos a los Estados miembros que revisaran sus planes iniciales con medidas adicionales que fortaleciesen la resiliencia, mejorasen la producción y el uso de energía renovable y redujesen su dependencia. A corto plazo, mientras nos enfrentamos a la inflación en la UE y a la inseguridad alimentaria en el mundo provocada por la militarización de los cereales y el combustible por parte de Rusia, la CE ha permitido excepcionalmente plantar este año y el próximo en tierras que normalmente están en barbecho. La excepción ayudará a mantener el potencial de producción en 2023
Las consecuencias actuales a corto plazo de la invasión rusa de Ucrania han tenido efectos disruptivos inmediatos en la producción de alimentos, las cadenas de suministro, los mercados y el comercio. Eso, a su vez, tiene un impacto en la disponibi-
SE DEBE FOMENTAR EL CONSUMO EUROPEO, PERO NUESTROS PRODUCTORES TAMBIÉN EXPORTAN A TERCEROS PAÍSES
lidad y asequibilidad de los alimentos, lo que provoca una inseguridad alimentaria aguda en algunos terceros países. Pero no se debe ignorar la creciente presión sobre la producción de recursos naturales a largo plazo: los impactos multisectoriales del cambio climático, incluida la escasez de agua, la contaminación, la disminución de la fertilidad del suelo, la disminución de los polinizadores, las plagas y enfermedades, la reducción de la biodiversidad... Si no se aborda debidamente con urgencia, limitará la producción necesaria para proporcionar alimentos a una población mundial en aumento. Hay una urgencia inherente para actuar. En un contexto incierto y volátil, la transición a un sistema alimentario sostenible debe seguir guiando la acción política, normativa y programática de la UE. Pero incluso en esta situación, no dejaremos que los productores de frutas y hortalizas se enfrenten solos a estos cambios.
Dado que los objetivos del Green Deal parecen ya establecidos, ¿cómo va a ayudar la UE a los productores y operadores de frutas y hortalizas a adaptarse a la nueva situación?
Abordar los desafíos de recursos naturales a largo plazo requiere soluciones integrales. Necesitamos que todos los ac-
“NO DEJAREMOS QUE LOS
PRODUCTORES DE FRUTAS Y HORTALIZAS SE ENFRENTEN SOLOS A LOS CAMBIOS”JANUSZ WOJCIECHOWSKI, COMISARIO DE AGRICULTURA DE LA UNIÓN EUROPEA.
tores de la cadena de valor avancen juntos hacia sistemas alimentarios sostenibles. Esto creará desafíos y oportunidades. A nivel de producción primaria, esto siginnovación para contribuir al crecimiento del rendimiento, como la agricultura de precisión, pero también más conocimiento para mejorar la gestión de nutrientes, un impulso en la producción integrada de plagas y una mayor adopción de alternativas biológicas frente a las químicas. Los comercializadores tienen un papel importante que desempeñar, contribuyendo a la remuneración justa de los agricultores y recompensando sus esfuerzos hacia la sostenibilidad, informando a los consumidores para fomentar un cambio hacia dietas más sostenibles y saludables y reduciendo el desperdicio de alimentos. Para lograr estos objetivos, la estrategia ‘Farm to Fork’ busca acciones en todas las etapas de la cadena de valor alimentaria a través de varios instrumentos regulatorios y no regulatorios. La PAC es clara para la producción primaria, pero también para
la promoción del consumo sostenible a través del etiquetado y del Código de Conducta para la Industria Alimentaria y Prácticas Comerciales Responsables.
Anteponer la producción europea a la de terceros países es fundamental en momentos como el actual. ¿Cree que es necesario concienciar a la población a través de campañas de promoción y tomar medidas al respecto?
Es loable subrayar que se debe fomentar el consumo de la producción europea. Pero al hablar de las frutas y hortalizas
que producimos en Europa, no olvidemos que nuestros productores también exportan bastante producción a terceros países y ese mercado es muy importante en muchos de los casos, si no vital, para su sustento. Por el contrario, no producimos en Europa todas las frutas y hortalizas que los consumidores esperan ver en los estantes, como mangos y otras frutas tropicales, por ejemplo. Además, el consumo de frutas y verduras en la UE sigue estando por debajo de los 400 gramos diarios per cápita recomendados por la Organización Mundial de la Salud. Si bien no nos corresponde a nosotros en la Comisión Europea decirles a los europeos qué comer, mantendremos nuestros esfuerzos para promover dietas saludables y sostenibles, y garantizar que, en el entorno alimentario ofrecido a los consumidores, la opción saludable sea la más fácil. Para ello, contamos con herramientas como nuestro Programa de Promoción, nuestro programa de frutas, verduras y leche escolar de la UE, y el Plan de Acción Orgánico.

El sector de las frutas y hortalizas atravesó en 2022 un año de turbulencias, marcado por una creciente sucesión de crisis que le están afectando. Además, tiene que responder a dos grandes desafíos: aumentar el consumo de frutas y hortalizas frescas en el marco del Pacto Verde Europeo, la estrategia ‘De la Granja a la Mesa’ y el Plan Europeo de Lucha contra el Cáncer, mientras hace frente al aumento de los costes de los insumos de producción, la crisis energética, la guerra en
amenazan las oportunidades que habían aparecido tras la crisis del COVID.
Al lidiar con éxito con las sucesivas crisis, el sector ha demostrado su capacidad de adaptación y perseveración. También, desde hace más de 20 años, se ha embarcado en un ‘viaje’ para abordar las preocupaciones sociales y medioambientales actuales.
Por lo tanto, cuenta con un buen posicionamiento para cumplir con la mayoría de los objetivos de la estrategia ‘De la Granja a la Mesa’, a pesar de que todavía se necesitan algunas inversiones adicionales ante los cambiantes retos medioambientales y climáticos. Desgraciadamente, el aumento de los costes, unido a la presión sobre el poder adquisitivo de los consumidores, están cuestionando que el sector pueda alcanzar los objetivos del Pacto Verde, ya que su rentabilidad se ve amenazada.
La crisis del COVID ha demostrado que las frutas y hortalizas constituyen un sector esencial. La estrategia ‘De la granja a la mesa’ recomienda a los consumidores que adopten una dieta basada en productos ve-
getales. Por sus activos medioambientales, el sector también debe considerarse parte de las soluciones del Pacto Verde, ya que contribuye a la captura de carbono que, en última instancia, permitirá a Europa alcanzar la neutralidad en 2050.
Según la Fundación Barilla, las frutas y hortalizas frescas tienen el menor impacto -
ra la salud. Es necesario valorizar mejor estos activos y se debe hacer más hincapié en la reputación de su posición dentro de la cadena alimenticia y el mayor valor para los consumidores, gracias al gran sabor, diversidad y el valor nutritivo único de consumirlas a diario.
PRODUCIR 15 MILLONES DE TN ADICIONALES
El sector ha de tener capacidad de crecimiento para hacer frente a las oportunidades que surgen. Puesto que, a día de hoy, el consumidor medio en la UE consume solo unos 350 gramos per cápita al día de frutas u hortalizas frescas, debería tomar al menos una pieza adicional para llegar a las cantidades mínimas recomendadas. Eso supondría un suministro de 15 millones de toneladas adicionales.
El sector necesita coherencia en las políticas europeas para tener acceso a las herramientas de producción adecuadas y hacer frente a los nuevos obstáculos climáticos y a las nuevas plagas y enfermedades, produciendo en un entorno competitivo y rentable para garantizar una diversidad de frutas y hortalizas que ofrezca a los consumidores precios asequibles. Debe seguir reforzándose para desarrollar todo
sumidores, los productores y otros actores.
Este año Freshfel no cesará en su labor de representar al sector. Continuará abordando sin descanso, con el apoyo profesional de sus miembros, los diversos retos: el sistema alimentario sostenible, la nueva norma europea sobre envasado, el uso sostenible de plaguicidas, las consecuencias del cambio climático, la inflación, los obstáculos logísticos, el acceso a mercados de terceros países, la reforma de la política de promoción, la aplicación de la nueva PAC y, por último, pero no por ello menos importante, el seguimiento y la estimulación del consumo. La agenda está repleta de temas importantes.
PHILIPPE BINARD, GENERAL DELEGATE OF FRESHFEL EUROPE.

By successfully dealing with consecutive crises, the sector has demonstrated its ability to adapt and persevere. Also, for more than 20 years, it has embarked on a ‘journey’ to address current social and environmental concerns.
The sector needs coherence in European policies to have access to the appropriate production tools and face new climatic obstacles and new pests and diseases, producingronment to guarantee a diversity of fruit and vegetables that offer consumers affordable prices. It must continue to be strengthened to deof the planet, consumers, producers and other stakeholders.

La exportación española de frutas y hortalizas frescas mantiene su evolución positiva superando los 16.000 millones de euros en 2022, según las estimaciones de FEPEX, ba-
bajo esa cifra global, el sector se enfrenta a un escenario cada vez más complejo y contradictorio, con una Comisión Europea (CE) liderada por las doctrinas medioambientalistas, un crecimiento de las importaciones continuo y un escenario de inflación que afecta fuertemente a la actividad productiva.
En este escenario, hay una preocupación creciente por la alimentación y la seguridad alimentaria, entendida como la disponibili-
el conjunto de la población, lo que podría suponer que hay un mayor apoyo institucional a los sectores productivos, al menos una corriente positiva, pero no es así.
Por un lado, las importaciones siguen creciendo fuertemente, impulsadas por una política comercial comunitaria que prioriza la globalización del mercado de la UE mientras que es muy poco combativa en la defensa de su sector productor primario. El desequilibrio existente en el mercado de la UE-27 es evidente, con unas importaciones hortofrutícolas procedentes de países terceros de 15 millones de toneladas en 2021, frente a unas exportaciones de 5,5 millones. Este desequilibrio se agudiza cada vez más porque la importación no está sometida a los mismos requisitos productivos y comerciales que las producciones comunitarias, haciendo el modelo de la UE cada vez menos competitivo frente al de países terceros.
Por otro lado, la CE está dirigida actualmente por las doctrinas medioambientalistas. Y aunque todos estemos a favor de producir cada vez más y mejor, teniendo en cuenta las necesidades de una población creciente, y con el menor impacto medioambiental posible, se prioriza un ideario medioambiental, muchas veces aje-
productiva, social y económica.
En la UE, hemos transitado de un objetivo inicial, que compartimos plenamente, de alcanzar una sostenibilidad competitiva, a una orientación política centrada casi exclusivamente en el componente medioambiental, obviando el social y el económico. En este ámbito, la Estrategia de la Granja a la Mesa plantea un gran desafío a la producción hortofrutícola porque prevé una reducción del uso de plaguicidas de un 50% hasta 2030 y del uso de fertilizantes de un 20%. Aunque compartimos la necesidad de avanzar en producciones lo más sostenibles posibles, es necesario reivindicar reiteradamente la sostenibilidad competitiva. No se puede producir ni tener seguridad alimentaria sin que se garantice la disponibilidad de herramientas
con calidad, de forma segura y con elevados volúmenes, como requiere el mercado. Sobre todo, teniendo en cuenta que, en relación a las producciones de países terceros, no hay reciprocidad en el cumplimiento de los estándares exigidos a los productores europeos.
En este entorno complicado habrá que recurrir a las fortalezas del sector, que le han hecho resiliente a lo largo de los años, y entre las que destacaría la diversidad de la oferta. La producción española se caracteriza por ofrecer una gran diversidad de productos, y dentro de cada uno de ellos, hay múltiples variedades, formatos, etc. Diversidad que permite diferenciarnos de otros exportadores. Destacaría también la amplitud de calendarios o la capacidad de comercializar grandes volúmenes para abastecer a todo
tipo de clientes y mercados. El sector hormedio rural por estar presente en múltiples regiones. Además, por el carácter intensivo en mano de obra y el valor añadido que generan sus producciones, contribuye signidel medio rural.
Por último, frente a la dependencia que Europa tiene de destacados alimentos de mercados muy lejanos, con el consiguiente coste de transporte, huella de carbono, tiempo… España ofrece, además, la cadena de valor más corta para proveer al continente de frutas y hortalizas todo el año.

PRIORIZA UN IDEARIO
Spanish fruit and vegetable exports maintain their positive evolution, exceeding 16,000 million euros in 2022. But the sector faces an increasingly complex and contradictory scenario, with a European Commission (EC) led by environmentalist doctrines, a continuous growth in imports and a scenario of inflation. Imports continue to grow driven by a community policy that prioritizes the globalization of the EU market. On the other hand, the EC is led by doctrines that prioritize an environmental ideology over productive and economic reality. In this context, it will be necessary to resort to the strengths of the sector.

En el mes de diciembre se hizo oficial lo que llevaba el sector barruntando hace semanas, un nuevo movimiento de The Natural Fruit Company antes del cierre del año 2022. En este caso ha sido probablemente el golpe con más repercusión en el sector hortofrutícola nacional y europeo al incorporar a su portfolio al gigante Bollo International Fruits.
Hablamos con José Vercher, presidente de Bollo International Fruits, para conocer en profundidad los detalles de la operación y el futuro de la centenaria empresa valenciana.
Llevamos varios años de inversiones en el sector hortofrutícola, en un principio vistas como rara avis y con el paso del tiempo han ido consolidándose. No es fácil invertir en un mercado con tanta variabilidad e incertidumbre, aunque a largo plazo la rentabilidad del sector, como atestiguan el aumento del valor de las exportaciones, hace de este negocio un nicho interesante.
Así llegó Fremman Capital, quien tras apenas 2 años se ha convertido en uno de los jugadores claves del escenario hortofrutícola. Vercher, consciente de todos estos movimientos y la tendencia del mercado, ha considerado necesaria esta integración para no perder su competitividad. “Nos va a permitir ampliar línea de productos, más de 7.000 ha de cultivos propios y controlados, que abastecerán a 12 plantas de envasado especializa-

la combinación de calidad de las empresas,
ANUAL COMERCIALIZADO DE 480.000 TN
equipos humanos y gama de productos que ofrece. “Sin ninguna duda, el mejor socio que hubiéramos podido tener”, concluye.
Lejos de suponer un paso atrás de Vercher, este cree que es el momento de aportar y compartir todo el conocimiento de todos estos años, y esta operación le permitirá centrarse en la estrategia y el largo plazo de la compañía, luchando para desarrollar su visión de ser la marca de la fruta.
Las 180.000 Tn de fruta comercializadas anualmente por Bollo se suman a la producción gestionada por TNFC, alcanzando un volumen anual comercializado de 480.000 Tn, lo que supone una oportunidad para Vercher de ampliar su gama de productos y llegar a más mercados.
un mensaje a sus clientes en esta nueva etapa en la que la cercanía no van a perderla: “Los clientes son nuestros amigos y nuestro potente equipo humano mantiene los valores de Bollo para una relación estrecha y, tras esta unión, más potente que nunca”.
“THE NATURAL FRUIT COMPANY IS THE BEST PARTNER WE COULD HAVE HAD”
In the month of December, a new movement of The Natural Fruit Company was made official before the end of the year 2022. In this case, it has been the incorporation of the giant Bollo International Fruits into its portfolio.
We spoke with José Vercher, about the details of the operation and the future.
Fremman Capital has become one of the key players in the fruit and vegetable scene after just 2 years. Vercher, aware of all these movements and the market trend, has considered this integration necessary in order not to lose competitivechoice of TNFC for the combination of quality of the companies, human teams and range of products that it offers, “without any doubt, the best partner we could have had”.
The 180,000 tonnes of fruit marketed annually by Bollo are added to the production managed by TNFC, reaching an annual marketed volume of 480,000 tonnes.

Vivimos momentos de incertidumbre y cambios constantes a consecuencia de las importantes perturbaciones de los últimos años. Hemos sufrido una pandemia mundial, la interrupción de la cadena de suministro a nivel global, la inestabilidad económica y política, la guerra… El cambio es la única constante y la forma de responder a esta situación será lo que nos lleve a tener éxito y seguir adelante con nuestras empresas.

El sector de frutas y hortalizas, como los demás, no es ajeno a esta coyuntura y, para saber cómo la está gestionando o debe gestionarla, hemos querido traer a nuestras páginas la reflexión de más de 30 gerentes, directores y expertos de las distintas disciplinas para que aporten su mirada hacia el futuro. El sector ha experimentado grandes transformaciones para llegar a lo que es hoy y seguro que tiene la capacidad de volver hacerlo.
We live in moments of uncertainty and constant changes as have suffered a global pandemic, supply chain disruption, economic and political instability, war… Change is the only constant and the way we respond to this situation will be what leads us to succeed.
The fruit and vegetable sector is no stranger to this situation the reflections of more than 30 managers who contribute their vision towards the future.
Las frutas y hortalizas son productos de alto valor añadido, con una demanda mundial que crece por encima de la agroalimentaria, ligada a la mejora del poder adquisitivo de los consumidores y a las macrotendencias alimentarias y de salud. Las exigencias de frescura y calidad marcan la frecuencia de visitas de los consumidores a los puntos de venta, lo que las hace importantes para la distribución como factor de atracción y diferenciación.
Las cadenas de valor de producción, transformación y comercialización de frutas y hortalizas mantienen una tendencia clara hacia la integración desde el campo a los mercados. Se trata de cadenas de valor donde no se puede separar entre la producción primaria y la posterior transformación y comercialización, como sí se hace en otro tipo de productos agroalimentarios almacenables y de calidad más estandarizada.
Para lograr una integración efectiva, es fundamental la digitalización de todos los procesos de esta cadena, persiguiendo -
neamiento de la oferta y demanda. Para ello, la digitalización se va a abordar no como la suma de herramientas diferentes, sino como un proceso con visión de integración de cadena de valor, donde el dato debe nacer digital y viajar digitalmente entre agricultores, agrónomos, empresas/cooperativas en origen, logística, distribuidores y llegar hasta el consumidor, con soluciones verticales y socios tecnológicos enfocados en frutas y hortalizas. Datos procedentes de sensores, automatismos, maquinaria, apps móviles, imágenes de satélite, datos abiertos o introducción directa de datos en soluciones de gestión. A partir de ahí, tendremos un crecimiento exponencial en el uso de la analítica Big Data, IA o automatización de procesos.
Como resultado, el sector hortofrutícola
(agua, fertilizantes, energía, agroquímicos, personal, maquinaria, logística, envases, etc.), reducirá la pérdida alimentaria a lo largo de la cadena, con un menor impacto ambiental, mejora de la trazabilidad y seguridad alimentaria, así como cadenas de valor con más rentabilidad económica. Todo ello incrementando la frescura, calidad, suministro, seguridad alimentaria, calendarios o transparencia sobre el origen de los productos.
La digitalización agrícola en España dará un Sistema de Información de Explotaciones Agrícolas y Ganaderas (SIEX), una de las novedades de la reforma de la Política Agraria Común (PAC), creando un registro interconectado de datos sobre las explotaciones agrarias. Estas necesitarán implantar el control digital de tareas e insumos en campo, conectado con el SIEX, que mejorará la trazabilidad de alimentos, asegurando el cumplimiento agricultores con la Administración.
A lo largo de esta década, habrá además importantes avances en tecnologías de gran impacto en el sector de frutas y hortalizas, como la genética, nutrientes, sanidad vegetal, maquinaria, robótica, riego, envases/embalajes, logística y energía. Y con tecnología horizontal y con fuerte capacidad de integración y transformación del sector, la digitalización tendrá un papel clave en su evolución. Se trata de capturar datos en todos los procesos de la cadena, para ser compartidos en tiempo real, analizarlos y proporcionar un soporte a la toma de mejores decisiones. Haciendo una gestión más digital y analítica, basada en datos y en su análisis, y logrando un vínculo digital que permita compartir todo tipo de datos desde el campo hasta el consumo.
El proceso de transformación digital de frutas y hortalizas debe ser abordado cuanto antes, pues es un camino inequívoco a
futuro y se requiere ir logrando niveles de madurez creciente para obtener todos susmación, los profesionales del sector son claves y debemos profundizar en la formación y el cambio cultural.
DIGITAL TRANSFORMATION IS THE WAY
Fruit and vegetables are products with high added value, with a growing global demand. Its production, transformation and commercialization value chains maintain a clear tendency towards the integration of the it, the digitization of all processes is essential, pursuing improvements in
ment of supply and demand.
For this, digitalization will be a process with a vision of integration, where the data must be born digital and travel digitally between farmers, agronomists, companies/cooperatives, logistics, distributors and reach the consumer with vertical solutions and technological partners focused on fruits and vegetables.
As a result, the sector will achieve a reduce food loss, improve traceabilchains. This digital transformation process must be addressed as soon as possible, as it is an unequivocal path to the future.


Siempre ha habido cambios climáticos. Los más recientes son las glaciaciones que se han desarrollado durante el último millón de años de la historia de la Tierra. El clima actual debería ser el que corresponde a una etapa de deglaciación tras el último óptimo climático de hace unos 8.000 años y que dio lugar a la primera revolución energética, que fue la agricultura. Pero desde hace unos 200 años estamos generando un cambio climático adicional muchísimo más rápido y, por tanto, más potente que los anteriores. En en la atmósfera es la misma que tenía la Tierra hace 3 millones de años.
No es casualidad que la Temperatura Media Global esté subiendo rápidamente. Esta es la temperatura media del planeta, pero hay una región que se está calentando mucho más y a mayor velocidad que el resto de la Tierra: la zona del Ártico, que incluye el hielo marino, los glaciares de Groenlandia y las tundras canadiense y siberiana. La razón es una realimentación positiva. Cada metro cuadrado que se funde un verano calienta 4 metros cuadrados adyacentes en el siguiente verano, de manera que el calentamiento es exponencial.
Ahora bien, la meteorología en las zonas templadas, entre los paralelos 30ºN y 60ºN está dominada por el ‘Chorro Polar’, la corriente atmosférica de unos 200 km de anchura y 2 km de profundidad que circula alrededor del Polo Norte a unos 11 km de altura. Esta corriente de aire está generada por la diferencia de temperaturas (que se traduce en diferencia de presiones debido a la ley de los gases) entre el ecuador y el Polo, siendo más intensa en el punto de máximo gradiente de aquellas. Cuando el gradiente es fuerte, el ‘Chorro Polar’ avanza sin casi meandros y sobre la latitud de 45ºN. Cuando es débil, hace grandes meandros y se desplaza hacia el norte. En una situación de un Polo más caliente, con un ecuador que mantiene su temperatura, el ‘Chorro’ se debilita y sus meandros son muy intensos.
La consecuencia sobre España es una amplificación de los extremos meteorológicos, con descargas muy intensas de agua cada pocas semanas y cambios bruscos de temperatura; según el ‘Chorro’, fuerza el aire sahariano o el procedente de Groenlandia sobre la Península. Adicionalmente, su desplazamiento hacia el norte implica que en España la estación de lluvias se ha reducido de la habitual de noviembre a abril, a una nueva, de diciembre a marzo. Tenemos dos meses menos de precipitación, con la consecuente reducción del agua caída sobre la Península.
El calentamiento global, y el de la región boreal más aún, va a continuar durante este siglo, pues no existe voluntad alguna para limitar la emisión de gases poliató-
que esperar en la zona templada un cli-
ma cada vez más extremo y con menos precipitación suave, pero con grandes inundaciones.

CURRENT CLIMATE CHANGE: IMPACTS ON AGRICULTURE
There have always been climatic changes, but over the last 200 years we have been generating an additional one that is much faster and more powerful. Right now, thephere is the same as it was on Earth 3 million years ago.
The consequence for Spain is an extremes, with very intense discharges of water every few weeks and sudden changes in temperature. Additionally, the rainy season has been reduced from the usual one from November to April, to a new one, from December to March. We have two months less precipitation, with the consequent reduction in the amount of water falling on the Peninsula.
Global warming will continue during this century, since there is no will to limit the emission of polyatomic gases such as CO2 and methane. We will have an increasingly extreme climate with less precipitation, but with great flooding.
El cambio climático actual: impactos en la agricultura de las zonas templadas
TENEMOS UN CLIMA CADA VEZ MÁS EXTREMO Y CON MENOS PRECIPITACIÓN SUAVE, PERO CON GRANDES INUNDACIONES



Dado que se espera que la población mundial alcance los 8.600 millones para 2030, la producción agrícola debe aumentar drásticamente si se quiere satisfacer la creciente demanda de alimentos y bioenergía.
Un tema importante para los productores de árboles frutales es el manejo y la recolección del cultivo, cuya optimización les ayudará a maximizar el rendimiento, así como mejorar la calidad futura del producto. Sin embargo, debido a las regulaciones cada vez más estrictas de la UE, y a una presión dramática para aumentar la producción de alimentos, las técnicas actuales para el manejo y recolección de cultivos presentan varios problemas:
1. Impacto ambiental.nitarios a ciegas sobre todo el árbol y no en la flor provoca el desperdicio de hasta el 90% de la solución en lugares no deseados. Además, normalmente, se estima la cantidad de químico necesaria solo partiendo de unos pocos árboles muestreados y se aplica a todos de la misma manera, ignorando las diferencias cruciales entre árboles.
2. Ineficiencia. La tarea de aclareo requiere de mucho tiempo y, por lo tanto, es costosa. En este ámbito, a veces las soluciones químicas sufren una gran variación en su efectividad de un año a otro, causando más o menos merma en el árbol e influyendo, por tanto, en las tareas de aclareo.
3. La mayor parte de la fruta del mundo se cosecha a mano. La recolección de manzanas, en la actualidad, requiere que los trabajadores llenen cestos durante todo el día. Debido al esfuerzo físico de muchas horas, así como al carácter repetitivo de los movimientos realizados por el recolector, la cosecha de manzanas puede contribuir al desarrollo de enfermedades en su sistema musculoesquelético.
Como respuesta a estos problemas, hay empresas que fomentan la innovación tecnológica a través de la producción de robots para la automatización de las actividades agrícolas. Es el caso de Aigritec, una start-up italiana establecida en Bolzano en 2019. Mediante el uso de sistemas de inteligencia
robóticos de alta velocidad, precisión y resistencia, ofrecemos robots de aclareo y cosecha, capaces de acompañar o sustituir a los temporeros, especialmente en actividades agrícolas intensivas.
An important issue for fruit tree producers is the management and harvesting of the crop, the optimization of which will help them maximize yield, as well as improve the quality of the product. However, current techniques present several problems:
1. Environmental impact. Blindly spraying phytosanitary products over the entire tree causes the waste of up to 90% of the solution.
Sin ir más lejos, hemos desarrollado ADAM, un robot basado en una tecnología revolucionaria que es capaz de aumentar la productiuso de productos químicos (costo e impacto ambiental), reducir las necesidades de mano de obra y liberar a los trabajadores de actividades repetitivas y agotadoras.
Para lograr estos objetivos, hemos combi-
ración, que detecta y monitorea las flores de los manzanos, junto a robótica de vanguardia, destinada a realizar tareas precisas y automatizadas de aclareo y cosecha en el
tendencias y defectos potenciales en el ciclo de crecimiento del árbol, mejorando las técnicas de manejo del cultivo.
2.suming and therefore expensive.
3. Most of the world’s fruit is harvested by hand. Apple picking can contribute to the development of diseases in your musculoskeletal system.
In response, there are companies that promote technological innovation. This is the case of Aigritec, an Italian start-up that, through the
offers thinning and harvesting robots, capable of accompanying or replacing seasonal workers.
Without going any further, we have developed ADAM, a robot based on revolutionary technology capable of increasing productivity, reducing the use of chemical products (cost and environmental impact), reducing labour needs and freeing workers from repetitive and exhausting activities.

Vivimos tiempos de una total incertidumbre, en los que el sector hortofrutícola tendrá que hacer lo que viene haciendo desde hace años, adaptarse y ser resiliente. Pero debemos ser realistas y conscientes de hasta dónde llegamos, porque no todo depende de nosotros mismos.
Tenemos que mirar al futuro con una perspectiva muy amplia. El tema energético, que está limitando en parte las producciones centroeuropeas, es solo algo pasajero. Debemos ir más allá. Geopolíticamente, nuestra posición en el mapa, al sur de Europa, supone una debilidad brutal. Hasta cierto punto, debemos entonar el mea culpa, no hemos sido capaces de dar un golpe sobre mesa de las instituciones europeas para que nos valoren. Pero, aún así, ningún gobierno, independientemente de su color político, puede hacer mucho.
Si echamos un ojo más al sur, nos encontramos con Marruecos, que abre y cierra el grifo de la inmigración ilegal cada vez que algún político europeo lanza un mensaje que no le cuadra. Pero es que, si miramos al norte, nos encontramos con Francia, que históricamente nos ha tenido cierta animadversión. Este país cuenta con mucho poder en la Unión Europea (UE), hasta el punto de presionar en el comercio exterior para favorecer a países terceros, y ya no hablo solo de Marruecos, sino de todo el Magreb. Pero como decía, estas son cuestiones que, como agricultores, se nos escapan.
A pesar de todo, hoy tenemos una posición muy buena en el mercado comunitario. Hace más de 20 años que en Almería superamos el tema de los químicos y llevamos mucho tiempo sin alertas sanitarias. Eso no impide que Europa continúe importando producto de países terceros a diario, de orígenes en los que no es extraño que sí se produzcan esas alertas. Aún así, Europa nos necesita, este invierno y el que viene. Y es este el momento que debemos aprovechar para atajar problemas que aún no han saltado a
la palestra, pero que podrían hacerlo, luego, debemos actuar con previsión.
No podemos dejar de pensar, por ejemplo, en la contaminación por nitratos de nuestros acuíferos. Estoy convencida de que otra forma de fertilizar los cultivos es posible, en Clisol llevamos haciéndolo más de 20 años. Reutilizamos el 100% del agua de los drenajes gracias a nuestros cultivos sin suelo. Esta forma de producción es una alternativa, aunque no tan de moda como el ecológico. Y precisamente porque no cultivamos en suelo -
tamos ahorrando y reutilizando agua.
Por otro lado, debemos dar un nuevo enfoque a la desalación. No es de recibo que cojamos del mar solo lo que necesitamos y le devolvamos todo lo demás en forma de salmuera. Hay que buscar fórmulas para revalorizar ese subproducto y, de hecho, ya se está haciendo.
Soy consciente de que, a nivel mediático, veny nuevas tecnologías -que llegarán, por supuesto-, pero creo que existen problemas mucho más sencillos y que son fáciles de abordar para cualquier pequeño agricultor. Y hablando de medios, no puedo pasar por alto nuestra gran asignatura pendiente: la comunicación. No es de recibo que se mire a la agricultura intensiva de hoy como si fuese la misma que hace 60 años. Esto no ocurre con ninguna otra actividad, nadie mira a los polos industriales de Madrid, Barcelona o el País Vasco y ve un sector contaminante. Sin embargo, miran a nuestra agricultura y ven el mismo modelo que abusaba de los químicos o quemaba los plásticos del invernadero. Algo estamos haciendo mal. La agricultura de Almería es sumidero de CO2 gracias al efecto albedo, contribuye a bajar la temperatura de nuestra zona mientras el resto del planeta se calienta… Y esto debemos comunicarlo, y enseñar a todos los agricultores a hacerlo de la forma adecuada.
We live in times of total uncertainty, in which the fruit and vegetable sector will have to adapt again and be resilient. But we must be aware of how far we go, it doesn’t all depend on ourselves.

We have to look to the future with a very broad perspective. The energy issue is just a phase. We must go further. Geopolitically, our position on the map, in southern Europe, is a huge weakness. If we look further look north, we do so with France, which historically has had a certain hostility towards us.
Despite everything, we have a very good position on the Community market. Europe needs us, and this is the moment we must take advantage of to tackle problems that have not yet come to the fore.
I am referring, for instance, to the contamination by nitrates of our aquifers. We must also give a new approach to desalination and,
pending subject: communication. Agriculture in Almería is a CO2 sink, the bleaching of our farms, thanks to the albedo effect, contributes to lowering the temperature in our area while the rest of the planet warms up... And we must communicate this.

Director comercial de Fruta y Verdura de Carrefour España.

En un momento de incertidumbre sobre los retos que nos deparará el futuro, bajo mi punto de vista, son dos los temas que deberá afrontar la cadena de valor de la que formamos parte. Por un lado, la contención de costes para conseguir el mejor precio para nuestros clientes manteniendo la mayor calidad; y por otro, la visión estratégica a medio y largo plazo.
Para alcanzarlos, son cinco los ejes sobre los que debe articularse nuestro trabajo diario:
1. Conocimiento y control de la cadena. Es muy importante saber tanto lo que está sucediendo en la empresa donde trabajamos como en los demás eslabones involucrados. Tener información veraz y actualizada nos permitirá discernir, por ejemplo, si una subida de costes es coherente con la situación general o está fuera de mercado.
2. Revisión de procesos y productividad. No hay mejor momento que este, si no se ha hecho recientemente, para revisar por qué y cómo hacemos las cosas desde base 0, recuperando minutos en todos aquellos procesos mejorables o que no aportan valor perceptible para el cliente. Desde los procesos de cultivo, envadesarrollar formatos ahorro, por ejemplo.
5 EJES DE FUTURO
1. Conocimiento y control de la cadena.
2. Revisión de procesos y productividad.
3. Inversión.
4. Ampliar las campañas y el volumen de productos nacionales/ regionales/locales.
5. agentes de la cadena.
3. Inversión. Es muy importante que cada agente de la cadena de valor nunca pierda la visión a largo plazo, pues inversiones, o en recursos de energía renovable harán posible seguir controlando el gasto a futuro manteniendo la competitividad.
4. Apostar por la ampliación y mayor volumen de las campañas de productos nacionales/regionales/locales. En un escenario donde se ha incrementado tanto el coste del transporte, electricidad, etc., existe una gran oportunidad para el producto nacional/ regional/local aprovechando su cercanía a nuestros clientes, junto a una muy buena cay captación de nuevos consumidores.
5.
tes de la cadena. Enfrentar los retos de forma conjunta es la mejor manera de tener éxito ante los mayores desafíos; por tanto, aprovechar las fortalezas entre diferentes agentes de la cadena de valor, hacer converger estrategias de futuro y trabajar con transparencia y objetivos alineados es otra forma de afrontar este desafío con mayor garantía de éxito.
tual, considero necesaria una reinvención
constante, así como apostar por el producto nacional/regional/local y sumar alianzas provechosas. Todo ello alineado con una estrategia empresarial que nos permitirá seguir siendo competitivos y aportar el valor que la cadena requerirá de aquí a futuro para continuar satisfaciendo las necesidades diarias de nuestros clientes.
NEED TO REINVENT YOURSELF
At a time of uncertainty about future challenges, there are two issues that the value chain will have to face. On the one hand, cost containment to achieve the best price for our clients while maintaining quality; and on the other, the strategic vision in the medium and long term. To achieve them, there are 5 axes on which our work must be articulated:
1. Knowledge and control of the chain.
2. Review of processes and productivity.
3. Investment.
4. Bet on the expansion and greater volume of national/regional/local product campaigns.
5. Planning and agreements between the agents of the chain.
A constant reinvention is necessary, betting on the national/regional/ alliances. All of this aligned with a business strategy that will allow us to remain competitive and add value.

 International Consultant and Speaker.
International Consultant and Speaker.
La noticia más importante para el futuro de la Humanidad es repetida por múltiples instituciones a nivel mundial. Según las estimaciones de diversos estudios, en los próximos 40-50 años, será necesario producir más alimentos que en el acumulado de los últimos 10.000 años, y no parece que sepamos cómo hacerlo. Y esto es así porque la población mundial aumentará en un 60% de aquí a 2050.
Hasta ahora, habíamos evitado el desastre amparándonos en el modelo de la ‘Revolución Verde’. Los avances biotecnológicos que nos proporcionó, reforzados por la mecanización agraria, los agroquímicos, el comercio
la utilización del agua nos han llevado a una reducción histórica de la pobreza extrema.
Hay una oleada de inversiones e investigación que persiguen repetir el milagroso esquema de esa revolución. Sin embargo, otras muchas cosas están sucediendo: acaparamiento de tierras de cultivo, control de inputs agrícolas esenciales, creación de fondos de inversión multimillonarios para el negocio agrícola…
Durante las últimas décadas, se ha producido un importante cambio en la agricultura, que ha pasado de un crecimiento basado en los recursos a otro basado en la productividad. Es decir, que, en lugar de aumentar la producción agrícola mediante el incremento de la cantidad de tierra, agua y el uso de insumos, la mayor parte del crecimiento actual proviene del aumento de la productividad
total de los factores de producción. Dicho de otro modo, los avances son el fruto de insumos para producir mediante el uso de tecnologías y prácticas mejoradas.
Pero el ritmo de este crecimiento, basado no parece ser capaz de contener las necesidades derivadas del aumento previsto de
de los recursos no es la solución, ya que son
Mientras tanto, las autoridades europeas están diseñando la nueva PAC (Política Agraria Común) con un gran nuevo condicionante: su supeditación al Pacto Verde Europeo (European Green Deal). Es decir, que los objetivos tradicionales de la PAC (alimentos sanos, abundantes y baratos, y mantenimiento de la renta agraria) se han de conseguir mediante unos requisitos previos: los objetivos medioambientales de Europa.
la hoja de ruta de la Comisión Europea (CE) para este profundo cambio estratégico mediante lo que han dado en llamar estrategia ‘From Farm to Fork’, que incluye objetivos a cumplir hasta 2030 como la reducción del uso de pesticidas del 50% o del uso de fertilizantes en un 20%. Si, tal y como veíamos, la ha limitado su aporte al incremento de prova a conseguir la agricultura europea subsistir restringiendo el uso, en porcentajes enormes,
Honestamente, no tengo una respuesta satisfactoria para la pregunta anterior. Parece maravillosa inventiva humana permita crear ese capital de conocimiento que nos lleve a nuevas ideas y tecnologías. Pero aún en este acto de fe en el futuro, Europa se ha quedado voluntariamente fuera del desarrollo legal de soluciones biotecnológicas basadas en los OGM (Organismos Genéticamente ModiCRISPR o similar). Europa afronta el futuro de su sector hortofrutícola con importantes y autoinfligidas restricciones estratégicas. El posible camino de desarrollo y evolución del sector europeo es tan radicalmente diferente al resto del mundo que pone en cuestión su propia supervivencia. En nuestro aumentar productividad está comprometida por los condicionantes medioambientales de la PAC, y la solución biotecnológica, por el principio de prudencia del legislador.
Nos queda aferrarnos a un dinámico sector con una capacidad enorme de adopción de innovaciones y a la posibilidad de colaborar en la cadena de valor para buscar la multipli-

los fondos europeos que, eso sí, deben cumplir los dos primeros condicionantes.
Estas son las reglas del juego que parece que tenemos que afrontar en los años venideros y deberemos analizar sus consecuencias en base a las posibilidades de supervivencia de la empresa hortofrutícola, es decir, desde su rentabilidad. También quedará apelar al compromiso de los consumidores europeos con sus agricultores y al valor de las soluciones locales, flexibles y rápidas en un entorno de apertura a la globalización. En cualquier caso, nos tocará, hoy más que nunca, saber diagnosticar y adoptar soluciones para sobrevivir en este choque de realidades.
DAVID DEL PINO, INTERNATIONAL CONSULTANT AND SPEAKER. EUROPE AND HORTICULTURE IN THE FUTUREThe most important news for the future of Humanity is repeated by multiple institutions worldwide. In the next 4050 years, it will be necessary to produce more food than in the cumulative of the last 10,000, and we don’t seem to know how to do it.
Until now, we have avoided disaster by relying on the ‘Green Revolution’ model, however, in recent decades, there has been a major shift in agriculture from resource-based growth to productivity-based growth. But its growth rate does not seem to be able to contain the needs derived from the expected increase in population.
Meanwhile, the European authorities
are designing the new CAP with one major condition: its subordination to the European Green Deal and the ‘From Farm to Fork’ strategy, which includes targets to be met by 2030, such as reducing the use of pesticides and fertilizers. How will European agriculture manage to survive by restricting the use
Honestly, I don’t have an answer. Europe faces the future of its fruit and vegetable sector with important and self-inflicted strategic restrictions. We have to hold on to a dynamic sector with a great capacity to adopt innovations, the possibility of collaborating in the leverage provided by European funds.

Presidente de Cajamar.
Si bien el sector hortofrutícola siempre ha sido importante para la agricultura española, el gran paso adelante tuvo lugar a mediados de la década de los 80 del siglo pasado, impulsado por la incorporación de nuestro país a la Unión Europea. Y no se debió a las ayudas europeas, sino a que se abrieron las puertas de un inmenso mercado.
El camino recorrido desde entonces no ha sido fácil, y en muchas ocasiones el sector ha tenido la sensación de haber sido utilizado como moneda de cambio en las negociaciones comerciales con terceros países, lo que ha conllevado a la progresiva apertura del mercado europeo. Aun así, ha experimentado una fuerte transformación para adaptarse al nuevo escenario global: se han mejorado las tecnologías, desde las infraestructuras de producción hasta los manejos, pasando por la calidad de las
do la producción, con el aumento de las especies cultivadas y el continuo incremento del abanico varietal, ampliando el calendario de oferta y generando nuevas características organolépticas y físicas; se ha incrementado progresivamente la dimensión de las explotaciones agrarias y de las empresas de comercialización, con la procesos y la capacidad para abordar nue-
do la profesionalización de las empresas de comercialización, situándose cada vez más cerca de los mercados de destino.
Pero el pasado nunca garantiza el futuro, es sólo la base sobre la que se construye. En este sentido, es preciso afrontar algunos retos ineludibles. El primero es el del agua, en el que es necesario actuar en varios frentes simultáneamente, de forma integrada. Por un lado, ser capaces de establecer planes hidrológicos lo más amplios posibles, tanto desde el punto de vista temporal como espacial. Nuestra estrategia de gestión del agua debería diseñarse como si estuviésemos en periodo de sequía permanente, con
sola gota. Por otro lado, inevitablemente, tenemos que optimizar el consumo a nivel de explotación, para lo que necesariamente debemos implantar las nuevas y potentes tecnologías existentes en la actualidad.
En parte vinculado con la gestión del agua, está el reto de la sostenibilidad, que debemos contemplar no desde la óptica del imperativo legal, sino como una necesidad para
también al uso de los fertilizantes y a la lucha contra las plagas y enfermedades, al manejo del suelo y al desarrollo de bioproductos.
Y, asimismo, el sector tiene que cerrar sus circuitos de energía y materiales y aplicar
EL SECTOR TIENE QUE CERRAR SUS CIRCUITOS DE ENERGÍA Y MATERIALES Y APLICAR ESTRATEGIAS DE ECONOMÍA CIRCULAR Y BIOECONOMÍA
estrategias de economía circular y bioeconomía para aprovechar hasta el último gramo de nuestras producciones, convirtiendo los subproductos en oportunidades de negocio.
Pero cada día es más difícil conseguir recursos humanos competentes y capacitados para sacar adelante nuestras producciones. Por eso, otro de los grandes retos es mejorar el atractivo del sector entre los profesionales
necesario que sigamos avanzando en la mecanización y robotización de las tareas más repetitivas y pesadas, para las cuales cada día es más difícil encontrar mano de obra dispuesta a realizarlas.
Por supuesto, hay que continuar afrontando el eterno reto de la rentabilidad. De nada sirve superar los demás desafíos si no logra-
Los retos ineludibles de las frutas y hortalizas españolas
mos que nuestras empresas tengan un buen posicionamiento en el mercado, porque donde se pueden obtener los mejores márgenes es en las últimas fases de la comercialización. Nuestro objetivo no debe limitarse a vender lo que hemos producido, sino ser capaces de gestionar íntegramente las diferentes categorías de frutas y hortalizas en las principales cadenas de distribución europeas, mejorando nuestro posicionamiento para nuestros clientes, con productos más
Estrechamente vinculado a lo anterior está la integración de todas las fases de la cadena hortofrutícola. El dinamismo, la capacidad de innovación y el efecto imitación que genera nuestro sector se extienden más allá del mismo, contribuyendo a mejorar el conjunto de la agricultura española. Así, en la medida en que continuemos avanzando en innovación, conseguiremos seguir manteniéndonos como un sector estratégico de la economía nacional y una referencia mundial en este sector.
THE UNAVOIDABLE CHALLENGES OF SPANISH FRUIT AND VEGETABLES
Although the fruit and vegetable sector has always been important for Spanish agriculture, the great step forward took place in the mid-80s of the last century, driven by the incorporation of our country into the European Union.

The road travelled since then has not been easy. Even so, the sector has undergone a strong transformation to adapt to the new global scenario: technologies have improved; production has been di-
the professionalization of the latter has been improved.
But the past never guarantees the future, it is only the foundation on which it is built. In this sense, it is necessary to face
water and, linked to its management, the challenge of sustainability. Another is to improve the attractiveness of the sector
course, we must continue to face the eter-
the integration of all phases of the chain.
As long as we continue to advance in innovation, we will manage to maintain ourselves as a strategic sector of the national economy and a world reference.
Mientras llega eso que llamamos metaverso, que no es otra cosa que la evolución natural de la forma en la que consumimos y nos relacionamos en y con internet, son muchas las tecnologías que hoy ya existen y que muchas marcas están incorporando a su forma de relacionarse con sus clientes, empleados, audiencias y comunidades. Bien por motivos de posicionamiento, de notoriedad, de moda, de estar a la última, de explorar, de innovar o de aprender… muchas empresas del sector alimentario se han lanzado ya a estamamos publicidad tradicional no es cuestión de branding
Es probable que te preguntes “¿qué es el metaverso? Ni entiendo, ni quiero entender. Lo mío es presencial, es físico, es alimentación, es tocar, esto de los videojuegos no va conmigo...”. Por muchas noticias que leas sobre que Facebook-Meta estaba equivocado, porque están echándose atrás en el planteamiento de su meta de hace un año, no te dejes engañar. No hay vuelta atrás. Hay tantísimas inversiones, y tantísimas empresas de primer nivel mundial, tanto músculo
todo esto, que no hay regreso al pasado. Si piensas que esto va de videojuegos… bienlos modelos de negocio.
Mi opinión es que el metaverso es un camino, más que un destino. Y que probablemente si en lugar de metaverso hablásemos de o “economía meta-tecnológica” o “Web 3.0”, te resulte más fácil comprender que estamos, solamente, en un proceso de transformación y de evolución natural de la usabilidad de internet, del umbral de conectividad y de disruptivas propuestas de valor que suponen una auténtica revolución económi-
ca y un nuevo renacimiento para el mundo del marketing, la comunicación y las ventas. Igual que hoy, la web 2.0 que conocemos nada tiene que ver con la web 1.0 de hace 10 años, donde el e-commerce, las comunidades, la participación… forman parte de una relación única entre marcas, productos y audiencias. La web 3.0 nos permitirá hacer cosas inimaginables dentro de solo 10 años gracias a la convergencia de un sinfín de nuevas tecnologías, softwares, hardwares e hiperconectividad. Ya hoy lo está haciendo.
Sí, por supuesto que podemos seguir hacien-
con menos de 18 años tiene unos códigos de comunicación, de narrativa y de interrelación muy distintos a los tuyos, propios y auténticos, que incorporan muchos de estos nuevos elementos tecnológicos. Mi recomendación personal es que incorpores en tus plantillas y
dos… y déjales hacer. Déjales pintar un nuevo modelo de negocio basado en la fusión de nuevas tecnologías y tu modelo de negocio actual. Un MVP, una versión beta de lo que puede ser el futuro de tu empresa. Imaginación aplicada, tecno-creatividad… y sí, para eso hace falta saber de qué tecnologías
estamos hablando. Cada día están saliendo nuevas plataformas que nos permiten seguir abriendo caminos.
Realidad virtual, aumentada o extendida; blockchain; assets digitales; NFTs; intelide pago; gemelos digitales; plataformas de mundos virtuales; avatares; procesamiento de lenguaje natural; robótica y automatización; nuevos sistemas e-commerce

Hay varias razones por las que una empresa de alimentación podría considerar entrar en el metaverso, o mejor dicho, en el uso de estas nuevas tecnologías:
1. Llegar a nuevos públicos. El uso de estas nuevas tecnologías permite a las empresas llegar a públicos que pueden no estar interesados en la publicidad tradicional. Que están y se mueven en otros entornos, plataformas y espacio de consumo de contenidos muy distintos. Por ejemplo, ya existen muchas marcas de alimentación o cadenas de distribución que están promocionando sus productos y sus marcas a través de plataformas virtuales, buscando a ese público más joven y tecnológicamente avanzado. Carrefour ya ha dado el paso a comprar espacios en Decentraland y generar contenidos. Independientemente de que haya más o menos audiencia, se posicionan como un retail in-
2. Mejorar la experiencia del consumidor. Hay muchas empresas de alimentación utilizando experiencias inmersivas y únicas para sus clientes. Aunque parezca mentira, hay empresas haciendo catas, degustaciones virtuales, experiencias y formaciones nutricionales, o viajes a campos buscando mostrar el origen. Showrooms virtuales,
formación y evangelización nutricional, recomendación y personalización de tu dieta
3. Publicidad innovadora. Las empresas de alimentación ya están utilizando la realidad aumentada para crear anuncios publicitarios que aparezcan en el mundo real cuando se utiliza la cámara del teléfono móvil. Esto es una forma efectiva de llamar la atención de los consumidores y promocionar sus productos de manera innovadora. El packaging y los lineales de los supermercados son canales perfectos para esta interactuación.
4. Fomentar la interacción con los clientes. Las empresas de alimentación también pueden crear sus propios mundos virtuales para fomentar la interacción con los clientes y promocionar sus productos. Por ejemplo, pueden crear un mundo virtual donde los consumidores aprendan sobre los ingredientes y la producción de sus productos, y probar diferentes recetas y combinaciones de alimentos. Hay plataformas como Nubii quetuales donde tener tus reuniones, convocar a clientes y proveedores, donde la experiencia de la reunión nada tiene que ver.
5. Formación interna o externa gracias a la VR.
6. Optimizar procesos.
En realidad, la tecnología no entiende de sectores, sino de personas y de sus relaciones y experiencias. Lo digital complementa y enriquece lo presencial para generar una que ver con la omnicanalidad. Todo esto va
Pero vamos a hacer un pequeño repaso de las tecnologías de última generación, y qué uso les están dando algunas empresas de la industria de la alimentación:
1.
10 de tecnologías que han explosionado en 2022 y antes se van a democratizar. Aunque te parezca mentira, el 50% de este artículo está automáticamente escrito por Chat-OpenAI. Pruébalo, es gratis. Ojo con Google, que está temblando para ver cómo seguir monetizando, si su modelo publicitario, SEO, SEM, cookies, se acaba. ¡Ojo a lo que viene! Se acabó eso de luchar por el posicionamiento en la primera página. O tu content tiene IA detrás o puedes no aparecer en el futuro cercano. Los creadores de contenido, el mercado de los medios de comunicación,
de los creativos, agencias y diseñadores (espacios como Dall-e, Namelix, Phrasee, Cortex, Node,…).
2. Procesamiento de Lenguaje Natural. Siri, Alexa, Cortana… Un poquito de IA y se acabó teclear. Hablaremos con los aparatos.
3. Realidad Virtual, Aumentada y Expandida. Cadenas de distribución como Walmart marcan el camino. Su experiencia de realidad inmersiva que sustituye al e-commerce tradicional incorpora NFTs, explorando el tener su propia cripto. El mundo publicitario en este aspecto es el que más está creciendo. QRs, content publicitario por el propio consumidor, experiencias inmersivas on y off site…
4. Gemelos digitales. El diseño en 3D y la generación de content tridimensional y foto realista tendrán una importancia enorme. Sustituye las fotos de tus frutas y verduras por archivos 3D.
5. Blockchain Smart Contracts, trazabilidad, logística, transparencia... todos los ingredientes para que la tecnología blockchain gane adeptos en el sector.
6. Criptomoneda. Criptoponqué (seis porciones de pastel y una de bitcoin) fue una campaña de la empresa colombiana más importante de ponqués, que lanzaron una colección de venta de productos exclusivos online. Vendieron sus 1.000 unidades en solo 2 minutos. Posicionamiento entre un nuevo público y la mayor campaña de PR gracias a la acción.
7. NFTs. Colecciones, variedades, identidades,
presas del sector alimentación que están utilizando los NFT como mecanismos para crear
propuestas tienen las NFT de alimentos como un planteamiento de sensación de singularidad y exclusividad. Esto se debe a que los titulares/ propietarios de las NFT obtienen acceso a algo
la culminación de muchas aplicaciones en la industria alimentaria. Se trata de una oportunidad para que las experiencias gastronómicas, los cafés y los restaurantes sean irresistibles. La comida siempre ha tenido un gran sentido de comunidad. Las OAD de alimentos se convertirán en la próxima gran disrupción en la economía del negocio alimentario.
8. Web 3.0. Imagínate todo esto integrado en la web de tu empresa.
Desde Ifema Madrid estamos explorando, investigando, probando… un nuevo journey tecnológico que enriquecerá la experiencia ferial de nuestros usuarios. Helixa es la marca que pretende acompañar a todas nuestras comunidades empresariales y profesionales en este camino hacia la meta-economía tecnológica. Bienvenidos al metaverso. #yosicreo
While the metaverse is coming, which is nothing more than the natural evolution of the way we consume and relate to and with the internet, there are many technologies that already exist and that many brands are incorporating into the way they relate to their customers, employees, audiences and communities.
The metaverse is a path, rather than a destination. We are in a process of transformation and natural evolution of the usability of the Internet, the connectivity threshold and disruptive value propositions that represent an economic revolution and a new renaissance for the world of marketing, communication and sales. We are talking about virtual reality, blockchain, digital assets,
There are several reasons why a food company could enter the metaverse: reaching new audiences; improving the consumer experience; innovative advertising; encourage interaction with customers; internal or external training thanks to VR; and optimize processes.
From Ifema Madrid we are exploring a new technological journey that will enrich the trade fair experience of our users, and Helixa is the brand that will accompany them on the path towards the technological meta-economy. Welcome to the metaverse.

Gerente de Onubafruit.
Parece cierto que este año están disminuyendo de algún modo los costes de producción, como ha sucedido con la bajada del precio de la energía, sin embargo, no creo que sea “el año de la recuperación”, como se comenta. Sigue habiendo mucha incertidumbre en los mercados y, ante tanto desconcierto, en Onubafruit hemos decidido evitar conjeturas y apostar por ‘menos aventura y más seguridad’.
quedemos parados, nuestro compromiso en proyectos de innovación sigue adelante, ya que representa para nosotros la base del futuro. En la actividad agrícola, cinco años es prehistoria, por lo que hay que estar continuamente buscando nuevas fórmulas y variedades optimizadas. Así es el caso de nuestros arándanos; disponemos de cinco variedades que van a ser mucho más competitivas que todo lo que hay en el mercado. Más productivas, con un derecho de uso más económico para nuestros socios y con menor coste de recolección, lo que
arándano, cuya oferta ha aumentado de forma importante a nivel mundial en los últimos años, no va a subir de precio, pero nosotros sí podemos reducir su coste para aumentar el margen
En cualquier caso, actualmente, la sociedad debe ser consciente de que la inflación incide en todos los sectores, incluida la alimentación. Hay una lucha descarnada por evitar que se repercuta en estos productos, pero es imposible. Además, hay que dejar de castigar al agricultor por todo lo que dicen que hace mal y ser coherentes. La solución a esto exige un profundo análisis sobre las relaciones que hoy existen y las que deberían existir entre la industria, la sociedad y la política.
De hecho, que, en 2050, 10.000 millones de personas se puedan alimentar, depende de nuestro trabajo. Por ello, es esencial apoyar al pequeño agricultor de cooperativa frente a los
grandes fondos de capital riesgo que se están haciendo con las tierras porque ellos hoy están aquí, pero mañana estarán especulando con otro negocio y abandonarán la agricultura. Es una realidad y hay que decirlo, alto y claro. No hay nada más sostenible de cara al futuro que un agricultor de cooperativa. Reivindiquemos la cooperativa como un modelo sostenible en el tiempo.
La apuesta de la sociedad por el producto local es una realidad, pero, bajo mi punto de vista, esta debe ser entendida a nivel europeo, como comunidad que somos. Hay que dar preferencia al producto europeo frente al de terceros países, que no guardan la misma seguridad alimentaria ni condiciones productivas que las nuestras, además del riesgo de contagio de plagas que conllevan.
Los agricultores españoles, ahogados por los elevados costes de producción, la falta de rentabilidad y la mala prensa, abandonan los cultivos a favor de lo que llaman el agribusiness, transformando sustancialmente el paisaje agrario. Hoy hay menos explotaciones agrarias, pero son cada vez más grandes, menos familiares y donde la inversión tecnológica desplaza la mano de obra humana. El control de los recursos de las zonas de explotación deja de estar en manos de las comunidades para estar en manos de personas que viven en
otras partes del mundo y a las que lo único que les preocupa es su rentabilidad.
El mundo se inclina hacia la destrucción de la agricultura tradicional, privándole de competitividad, agua y reputación, pese a ser el único modelo que garantiza la sostenibilidad de la alimentación mundial del futuro.
O se legisla de manera equilibrada todo esto o tanto los pequeños agricultores como los consumidores y el propio planeta tendrán que asumir las consecuencias. Todavía estamos a tiempo.
FRANCISCO SÁNCHEZ, MANAGER OF ONUBAFRUIT. THERE IS NOTHING MORE SUSTAINABLE THAN A COOPERATIVE FARMER
Farmers, suffocated by high proand bad press, abandon crops in favour of agribusiness. Today there are fewer farms, but they are getting bigger, less familiar, and where technological investment displaces human labour. The control of resources is no longer in the hands of the communities to be in other parts of the world where the only thing that concerns them is
The world is moving towards the destruction of traditional agriculture, despite being the only model that guarantees the sustainability of world food. Either legislate in a balanced way, or small farmers, consumers and the planet itself will have to bear the consequences.

CEO de Patatas Meléndez.
La agricultura ha sido uno de los principales motores de la economía española durante siglos y, a día de hoy, continúa generando riqueza y empleo. Teniendo ambos aspectos en cuenta, y con el profundo conocimiento que he obtenido tras más de 23 años trabajando en este sector, siete de ellos como
que confío plenamente en que la agricultura continuará teniendo un papel estratégico en la economía nacional, siempre y cuando sepamos adaptarnos a todos los cambios que se están produciendo.
El relevo generacional y la digitalización del cultivo son dos de los principales retos del sector agrario. Pese a que la demanda de alimentos continuará aumentando en los próximos años, el relevo generacional no está asegurado, por lo que la tecnología tiene un papel crucial y es una vía para acercar a los jóvenes al campo y luchar contra la despoblación rural.
No puedo ocultar el respeto que siento hacia el campo y hacia la importancia de cuidar la tierra. Precisamente para dar continuidad al cultivo y, al mismo tiempo, implantar por completo la Industria 4.0 para controlar la trazabilidad de nuestra materia prima y
Meléndez va a inaugurar en 2023 una fábrica automatizada que actualmente es el proyecto más destacado del sector agroalimentario en Castilla y León. Esta nueva planta es una nuestra región y por la innovación, un requisito imprescindible para mejorar la calidad de nuestras patatas y atraer empleo joven y, por tanto, rejuvenecer el campo.
Por otra parte, considero que la agricultura y la sostenibilidad deben caminar de la mano, más todavía en una época en la que el cambio climático se ha acelerado y debemos ser
más sostenibles que nunca. Esta es la razón por la que, desde Patatas Meléndez, nos hemos adherido al Pacto Mundial, adquiriendo un fuerte compromiso con 11 de los 17 Objetivos de Desarrollo Sostenible (ODS). Somos conscientes de que la agricultura ha sufrido cambios en los últimos tiempos que se han visto agravados por la pandemia y la guerra entre Ucrania y Rusia. Por ello, y entre otras muchas acciones, nuestra nueva planta de Medina del Campo reducirá la huella hídrica, utilizará energía de origen verde como paneles solares y vehículos de empresa híbridos y, además, eliminaremos los residuos que van a vertedero.
Por último, pienso que la diferenciación y una sólida propuesta de valor son esenciales en este sector. Por ejemplo, me siento orgulloso de que Patatas Meléndez fuera la primera empresa que decidió comercializar las patatas lavadas. Además, otros de los aspectos por los que nos diferenciamos son la gran cantidad de variedades que cultivamos y las distintas líneas de producto que lanzamos con frecuencia al mercado teniendo en cuenta los gustos del consumidor y las exigencias de nuestros clientes.
Con todo, mi conclusión es que la industria agroalimentaria continuará en auge dentro de la economía española, siempre que potenciemos la innovación y la sostenibilidad.

THE AGRI-FOOD SECTOR WILL CONTINUE TO BE A KEY DRIVING FORCE
Agriculture has been one of the main drivers of the Spanish economy for centuries and, to this day, continues to generate wealth and employment. Taking both aspects into account, and with the knowledge that I have obtained after more than 23 years working in this
it will continue to play a strategic role in the national economy, as long as we know how to adapt to the changes that are taking place.
The generational change and the digitization of the crop are two of the main challenges of the sector. Even though the demand for food will continue to increase, the generational change is not guaranteed, so technology has a crucial role and is a way to bring young people closer to the countryside -
tion. On the other hand, agriculture and sustainability must go hand in hand, even more so when climate change has accelerated. In addition, differentiation and a solid value proposition are essential in this sector.
For all these reasons, I believe that the agri-food industry will continue to grow, as long as we promote innovation and sustainability.
EL RELEVO GENERACIONAL Y LA DIGITALIZACIÓN DEL CULTIVO SON DOS DE LOS PRINCIPALES RETOS DEL SECTOR AGRARIO
El sector agroalimentario seguirá siendo un motor clave

Responsable del sector de Frutas y Hortalizas en AECOC.
De la pandemia a la guerra; de la escasez de materias primas a la crisis energética; de la inflación a una economía en desaceleración; de la globalización a una mayor regionalización; de un contexto normativo claro a nuevos posibles requerimientos legales que implicarán cambios sustanciales para las empresas: cada vez son más las variables que amplían el espectro de caminos posibles que podría tomar el sector de frutas y hortalizas.
Ante esta nueva era de incertidumbre radipueden las empresas de frutas y hortalizas
El valor empresarial fundamental para competir hacia el futuro es la resiliencia. Ya no se trata de predecir escenarios y prepararse para ellos; las empresas aprendieron con la pandemia que la clave hoy es adaptarse a los acontecimientos inesperados, hacerlo con rapidez y crecer ante las adversidades.
2023 seguirá siendo un año muy marcado por la subida de costes y la inflación. El nuevo impuesto al plástico no reutilizable, que entró en vigor el 1 de enero, contribuirá a este incremento y restará competitividad a las empresas españolas, que quedarán en situación de desigualdad frente a los demás países, siendo España la única de Europa en aplicarlo.
Por tanto, en 2023, el factor precio seguirá teniendo un peso muy fuerte, tanto en las mesas de negociación, tensionando la relación entre los distintos eslabones de la cadena de valor, como en la elección de compra del consumidor. En este sentido, es positiva la medida recientemente aprobada por el Gobierno de rebajar el IVA en frutas y hortalizas durante los primeros 6 meses del año, que ayudará a no estancar los consumos.
Aun así, el sector hortofrutícola tendrá que ir adaptándose a un consumidor cuya
LA TRANSPARENCIA, LA INNOVACIÓN Y LA CONSTRUCCIÓN DE VALOR SERÁN LOS INGREDIENTES PARA EL FUTURO DE NUESTRO SECTOR
capacidad de gasto se está viendo comprometida, sin dejar de buscar estrategias para movilizar las ventas y hacer crecer la demanda. Las empresas del sector necesitan hoy, más que nunca, escuchar atentamente al mercado y las tendencias del consumidor para aportar valor más allá del precio. Salud y sostenibilidad se han consolidado como los atributos diferenciales. En esta línea, para el 43% de consumidores es importante comprar y consumir productos hortícolas de proximidad, mientras que 1 de cada 4 valora las frutas y hortalizas producidas de manera respetuosa con el medio ambiente. Y aunque salud y sostenibilidad están ínsitos en el ADN de la categoría, queda mucho camino por recorrer por parte de las empresas en cuanto a transparencia, comunicación y creación de valor.

También el convenience es otra línea diferencial, con soluciones de 4ª y 5ª gama que, en otros mercados como, por ejemplo, el de EE.UU., cuenta con un despliegue excepcional; o los formatos facilitadores y adaptados a diferentes ocasiones de consumo, como el snacking, que representa un momento en auge a nivel mundial y una tendencia que ha vuelto con fuerza para responder a las necesidades de una sociedad frenética. Las empresas que no dejen de innovar y se sepan diferenciar tienen grandes oportunidades a su alcance.
Y cuando hablo de innovación también me
vidad de todos los eslabones de la cadena de valor de un sector tan complejo como es el de frutas y hortalizas pasa por mejorar desde el origen.
vertientes: la transparencia en toda la cadena de valor; la innovación de producto y en origen; y la comunicación y la construcción de valor diferencial, serán los ingredientes imprescindibles para el futuro de nuestro sector.
HEAD OF THE FRUIT AND VEGETABLE SECTOR AT AECOC.
RESILIENCE: THE VALUE OF THE FUTURE FOR FRUITS AND VEGETABLES
From the pandemic to war, from the scarcity of raw materials to the energy crisis... There are more and more variables that broaden the spectrum of possible paths that the fruit and vegetable sector could take. In this new era of radical uncertainty, how
The fundamental business value for competing is resilience, adapting to unexpected events quickly.
2023 will continue to be a year marked by rising costs and inflation, and the price factor will have a very strong weight. Transparency throughout the chain, product and source innovation, and communication and value construction will be essential for the future.
Resiliencia: el valor
Agua, cambio climático, plástico, guerra, Brexit, subida de costes, sostenibilidad, ultraprocesados, gobernanza, etc… Todos los días un susto. Raro es el día que no hay situaciones como las descritas para el sector agroalimentario y, en especial, para las frutas y las verduras. Y es que el futuro ya no es lo que era, pero tampoco sabemos lo que es; lo que sí sabemos es que es imposible de -


cialmente en bajar los costes como única ac-
nuclear han de estar todo lo bajos que se pueda, pero más importante es hacer lo que sea necesario en cada momento, repito, en cada momento.
El futuro te lanza un penalti tras otro que has de intentar parar y no tienes tiempo ni para adaptarte, lo tienes que parar como puedas y reponerte para el siguiente. En esta situación, lo único que vale a título individual es: ser grande, ser fuerte, ser ágil, reaccionar rápido, cambiar rápido y lo más barato
a nivel europeo o nacional, a cambios climáticos, a cambios de hábitos en el consumidor, a subidas de costes de insumos, etc., no cabe otra cosa que la unidad de acción coordinada de grandes grupos de empreúltima frontera del sector agroalimentario español. Ya sabemos hacer muy bien calidad, servicio y precio a título individual, lo que no sabemos hacer es lobby y marketing en equipo. Estamos diseñados para lograr pero no en grupo. Esta capacidad de actuar en común, de cazar el mamut mediante acciones coordinadas, es lo que nos sacó de las cavernas y lo que nos puede volver a ayudar a afrontar los grandes retos de nuestro tiempo. Estamos diseñados desde la escuela primaria y desde la escuela de negocios para ser egoístas individualistas. El que levanta la mano para activar la acción común es tonto, sospechoso o tiene mucho tiempo libre. Lo damos todo en la empresa y muy poco o nada en la acción común entre empresas. Tenemos a nuestras asociaciones y organizaciones al límite de la subsistencia presupuestaria y, lo que es peor, en algunos casos nuestras asociaciones son parasitadas por interesados individuales que se limitan

ción, tiempo y recursos al lobby y marketing colaborativo en asociaciones, organización o directamente con otras empresas. Aquí no hay competencia, solo bien común.
PORRAS, GENERAL MANAGER OF UNICA. WE NEED MORE COOPERATION
Climate change, plastic, war, Brexit, rising costs, etc... Every day a scare. The future is no longer what it was, but we do not know what it is either, only that it is impossible to foresee. In this situation, the only thing that counts as an individual is to be big, agile, change quickly and as cheaply as possible. Is this enough to ensure unity
ra, y no es la sacrosanta competitividad, es la cooperación en la unidad de acción.
Por muy grande que cualquiera piense que es como empresa, frente a retos legislativos
Sin embargo, cuando llegan los problemas de verdad, todos queremos una OTAN a nuestro servicio. Por favor, si eres un responsable de cualquier empresa, dedícale aten-
In the face of national and European legislative challenges, there is no other option than unity of action. This is emerging as the last frontier of the sector, we have to lobby and market as a team. This ability to act together brought us out of the caves and will help us face the great challenges of our time.

Coordinador del Centro de Agroingeniería del IVIA.
Coordinadora del Centro para el Desarrollo de la Agricultura Sostenible del IVIA.
En la actualidad, problemas asociados al aumento de la población mundial o relacionados con el cambio climático, junto con la falta de relevo y mano de obra en la agricultura, están originando grandes cambios en la forma en la que producimos alimentos. Necesitamos producir más con menos y hacerlo de una forma medioambiental, social y económicamente sostenible. En este sentido, la Comisión Europea presentó en 2020 la Estrategia ‘De la Granja a la Mesa’ como una de las iniciativas del Pacto Verde Europeo. Esta Estrategia pretende alcanzar un modelo productivo sostenible para alimentar a una población cada vez más numerosa en un escenario de cambio climático. Entre los objetivos establecidos destaca la reducción en el uso de desperdicio alimentario o la lucha contra el fraude en la cadena de suministro. Para lograr estos objetivos, es imprescindible adoptar tecnología inteligente que impulse un manejo óptimo de todos los procesos productivos y garantice la seguridad y la calidad de los alimentos, mejorando la sosen la cadena de producción y suministro de alimentos, desde la granja o el campo hasta el consumidor.
En este momento, disponemos de sensores capaces de recoger datos e imágenes del campo relacionados con las características, el estado y las necesidades del cultivo. Estos sensores se pueden embarcar en diferentes plataformas como satélites, drones, vehículos o robots agrícolas y ofrecen información sobre problemas relacionados con el riego, la fertilización, el estado de la planta o la presencia de plagas o enfermedades, o realizan predicciones sobre cantidad y calidad de la producción, posibilitando la toma de decisiones óptimas y tempranas sobre el
manejo de la parcela. Además, tras la reco-
parámetros comerciales como el tamaño, el color, la forma o la presencia de defectos, logurando la calidad del producto y su envío al mercado más adecuado.
La próxima década habrá un gran avance marcado por el uso de los datos y la digitalización, el internet de las cosas y, en especial, el uso de algoritmos deción de datos provenientes de distintas fuentes, pre y postcosecha, incluyendo datos productivos, meteorológicos, sociales, logísticos o económicos, a lo largo de todo el ciclo productivo. En el campo, veremos la consolidación de los robots agrícolas, capaces de tomar decisiones y realizar operaciones de forma autónoma. Por ejemplo, fertilizar de forma precisa en función del diagnóstico nutricional de cada planta, la calidad del suelo y la evolución del precio de los productos, o cosechar en el momento óptimo y de forma selectiva según el estado de madurez y calidad de cada fruta, el precio que puede alcanzar en destino y las necesidades puntuales del mercado. En postcosecha, se están desarrollando sensores capaces de de-
fruta como textura o acidez, contenido en agua, azúcares o grasa, o estimar el índice de madurez. Estos sensores van a facilitar el desarrollo de sistemas automáticos de selección capaces de predecir desde el sabor hasta la vida útil del producto. La integración de los datos generados antes y después de la cosecha, junto con el uso de máquinas inteligentes, permitirá una producción sostenible y a demanda que
contribuirá a la consecución del objetivo de producir más, de forma más segura y con mayor calidad, mejorando la vida del agricultor, ajustándose a las demandas del consumidor y utilizando menos recursos.
JOSÉ BLASCO IVARS, COORDINATOR OF THE IVIA AGROENGINEERING CENTER.

ANA QUIÑONES, COORDINATOR OF THE IVIA CENTER FOR THE DEVELOPMENT OF SUSTAINABLE AGRICULTURE. THE NEXT DECADE WILL SEE A BREAKTHROUGH IN THE USE OF DATA AND AI

The increase in world population, climate change, the lack of relief and labour in agriculture are causing great changes in the way of producing food. The next decade will see a breakthrough marked by the use of intelligence.
Digitalisation, the Internet of Things intelligence algorithms, will facilitate the integration of data from different consolidation of agricultural robots and, in post-harvest, sensors are being developed to determine the physicochemical properties of the fruit. The integration of all this data, together with the use of intelligent machines, will allow a greater production, more sustainable, safer and with higher quality.

Delegado comercial de Yara en Almería y Murcia, y Product Manager de la gama YaraVita.
En lo que a nutrición vegetal respecta, el mercado de frutas y hortalizas avanza hacia la fertirrigación 100%, práctica que sin duda se ve favorecida por la estrategia ‘De la granja a la mesa’ de la Comisión Europea (CE) o por otras iniciativas legislativas nacionales como el proyecto de Real Decreto de Nutrición Sostenible, que pretenden -
ductos fertilizantes. No obstante, no debe dejar de contemplarse un abonado orgánico y un NPK de seguridad que complemente la fertirrigación y que aseguren una fertilización completa.
Además, conviene recordar que disponemos de otros insumos además de los fertilizantes “clásicos”, ya sean orgánicos, organominerales o minerales. Las unidades fertilizantes aplicables de estos productos en un área determinada van a verse cada vez más acotadas, por lo que es importante contemplar la ayuda de aplicaciones foliares y radiculares de bioestimulantes, como microorganismos, sustancias húmicas y extractos de algas que aseguren el desarrollo óptimo de los cultivos, maximicen la producción y proporcionen la mayor calidad de las cosechas; y que, en el caso de las aplicaciones vía riego, contribuyan a mejorar las características físicas, químicas y biológicas del suelo, hecho que está siendo promovido igualmente por la Administración, por ejemplo, a través de determinados ecorregímenes del Plan Estratégico Nacional de la Política Agraria Común.
Desde los inicios de Yara hace 120 años, hemos apostado por aportar cada nutriente en el momento y la cantidad justamente necesaria, así como en la que sea asimilable
para la planta. Por esto, hemos desarrollado Nitrato de Calcio como nutriente esencial desde la germinación y fósforos de máxima disponibilidad como son los polifosfatos, incluidos, por ejemplo, en nuestros NPK YaraMila y en YaraVita STARPHOS, formude nutrientes.
Además de la aportación de nutrientes, serán otros los aspectos que nos permitirán
tipo de suelo y con cualquier meteorología, gracias a la digitalización de las explotaciones agrícolas. Es el caso del empleo de sensores de riego y la incorporación de datos de suelo y del estado nutricional del cultivo a plataformas de seguimiento de parcelas agrícolas, lo que permite la división de la misma en diferentes áreas de manejo. Así -
lación de la fertilización por parte del cultivo con una mínima lixiviación de nutrientes.
guro no basta con fertilizar, sino que hay que desarrollar una nutrición integrada de
incorporando las mejores técnicas disponibles y aportando al suelo y a la planta lo que necesita.
JAVIER DÍAZ, COMMERCIAL REPRESENTATIVE OF YARA IN ALMERÍA AND MURCIA, AND PRODUCT MANAGER OF THE YARAVITA RANGE. INTEGRATED NUTRITION FOR CROPS

The fruit and vegetable market is moving towards 100% fertigation, a practice that is undoubtedly favoured by the European ‘Farm to fork’ strategy and other national legislative initiatives. However, an organic fertilizer and a safety NPK that complements fertigation should not be overlooked, ensuring complete fertilization.
Since Yara’s beginnings 120 years ago, we have opted to provide each nutrient at the right time and amount. In addition, there will be other aspects that will allow us to adjust the fertilization in each farm and type of soil thanks to the digitalization of the farms. This is the case of irrigation sensors and the incorporation of soil data and the nutritional status of the crop to plot monitoring platforms.
To face a secure future, it is not enough to fertilize, but integrated crop nutrition must be developedrating the best available techniques and providing the soil and the plant with what it needs.
EL MERCADO DE FRUTAS Y HORTALIZAS AVANZA HACIA LA FERTIRRIGACIÓN 100%

Socio de EY, responsable de política tributaria.
Finalmente, y pese a los esfuerzos del mundo de la empresa para conseguir una demora, el pasado 1 de enero entró en vigor el impuesto especial sobre los envases de plástico no reutilizables, convirtiendo a España en el primer país de la UE que lo aplica, pese a sus altos porcentajes de uso de reciclado y ser el único que no ha alcanzado aún el PIB pre-COVID.

El ámbito objetivo de este impuesto ambiental, que apuesta por una mayor circularidad en el uso del plástico, queda delimitado por los conceptos de “envase”, “no reutilizable” y “plástico”, tal como son
desprende que no sólo quedan gravados los que se utilicen para la venta o primarios, sino también los envases colectivos o secundarios y los de transporte o terciarios. Los productos compuestos por más de un material se gravarán únicamente por la cantidad de plástico no reciclado que contengan.
Nos encontramos, por tanto, ante un impuesto novedoso, no armonizado, aplicable en todo el territorio español, al que quedan sujetos principalmente los envases no reutilizables que contengan plástico, tanto vacíos, como si se presentan conteniendo, protegiendo, manipulando, distribuyendo y
EL IMPUESTO SERÁ DE 0,45
EUROS POR KILOGRAMO DE PLÁSTICO NO RECICLADO
presentando mercancías. También aquellos productos de plástico que permitan cerrar, comercializar o presentar los envases, como sería el caso de los tapones, cintas de y este punto es importante, quedarán sujetos los productos semielaborados, como sería el caso de preformas, láminas de termoplástico o las bobinas de plástico que sirvan para la obtención de los envases.
Dado que el tributo grava la utilización de los envases plásticos en España, el legislador ha establecido tres posibles hechos imponibles:
• La fabricación de los productos que forman parte del ámbito objetivo. En este caso, el impuesto se devengará con la primera entrega en España, siendo el caso más habitual que el fabricante del envase o del producto semiterminado repercuta al empresario hortofrutícola el impuesto.
• La importación de esos mismos productos, caso en el que el impuesto se liquidará en el documento de importación.
• La adquisición intracomunitaria, que obligará a quien la haga a autoliquidar el impuesto.
Respecto del hecho imponible “fabricación”, la norma ha optado por asociar la posición de contribuyente con la empresa del sector del envase plástico, en lugar de hacerlo con su proveedor de materias primas o con su cliente.
Ello supone que una empresa productora de fruta, que envasa y comercializa en cajas, estuches o redes de plástico que ad-
quiere a un tercero, no será contribuyente del impuesto por ello -puesto que será el productor del envase-, salvo que directamente lo importe de un tercer país, pero sí tendrá que soportarlo económicamente su proveedor por sus compras de envases, requiera para comercializar sus existencias.
Lo que hará a razón de 0,45 euros por kilogramo de plástico no reciclado, un tipo coincidente con el que Italia tendrá desde 2024, y algo superior al de 0,2 libras esterlinas que sí existe en Reino Unido.
La caracterización del impuesto como monofásico permitirá, a su vez, que los empresarios hortofrutícolas puedan repercutir económicamente el importe del impuesto a sus clientes y que -cuando así se le demande por los mismos- tengan la obligación deparado- la cantidad de plástico entregado con las mercancías y el impuesto soportado respecto de la misma.
Además, para los operadores que exporten parte de su stock, la Ley prevé que, a través del modelo A22, puedan obtener la devolución del impuesto soportado en España,cumentación acreditativa de dicho derecho.
de gestión para las empresas del sector que habrán de trazar la cantidad de plástico que acompaña a sus compras y ventas en cada momento, con el reto de poder gestionar la traslación del precio a los clientes o la devolución del impuesto en los supuestos de exportación.
Los empresarios hortofrutícolas podrán repercutir el impuesto del plástico






























Directora de Innovación del Parque Científico-Tecnológico de Almería.

Estamos en un momento complejo, relevante y de cambios para el sector agroalimentario. Hemos experimentado los efectos de la globalización de los conflictos y cuál es su impacto, mucho más allá de donde tienen lugar. Esto nos ha hecho ser conscientes de que la geopolítica es un factor estratégico y determinante que ha de estar presente en el sector agroalimentario para que éste pueda anticiparse a las demandas y necesidades de la población, que se caracteriza por tener una migración correspondiente al 4% de los habitantes de todo el mundo, concentrarse en grandes centros urbanos, estar envejecida y en continuo crecimiento.
Y a este escenario mundial se le suman factores restrictivos para el sector agroalimentario como son: el agotamiento de los recursos naturales, requerimientos en seguridad alimentaria, la necesidad de una agricultura regenerativa, las zonas climáticas cambiantes…
Me resulta curioso cómo los seres humanos nos contradecimos entre lo que hacemos y lo que decimos. Mientras nuestro discurso está basado en la preocupación por lo que comemos, por cómo ha sido cultivado, los productos que se han utilizado durante su producción… lo cierto es que los datos, a nivel global, nos muestran una realidad muy distinta.
Apostamos por una dieta saludable, pero esto se vuelve utópico cuando casi 3.100 millones de personas no pueden acceder a ella debido al incremento de los costes. (The State of Food Security and Nutrition in the World 2022). El hambre no para de crecer, llegando a casi 830 millones de personas en 2021 (FAO), mientras que casi 1.000 millones sufren de obesidad (OMS). Probablemente, el mayor reto y hacia donde realmente debería dirigirse el sector esté ahí, en el análisis de estos datos y las causas que hay detrás, para así pensar en cómo revertirlas.
Si realmente el objetivo de nuestro sector lograr la seguridad alimentaria y la mejora de la nutrición, y promover la agricultura sostenible”, esto solo lo conseguiremos con un cambio profundo del sistema alimentario y agrícola a nivel mundial.
Debemos reducir los factores que aumentan los costes en la producción, el almacenamiento, el transporte, la distribución y la comercialización de alimentos. Hablamos de tecnología cuando, en la mayoría de los casos, las soluciones tecnológicas ya existen, pero su implementación no se produce por un tema de costes. Hablamos también de sostenibilidad cuando son una minoría los consumidores que pueden pagar los alimentos cultivados sosteniblemente y el sector no puede asumir su coste.
Evidentemente, la innovación y la tecnología tendrán un papel fundamental en la solución a estos desafíos, pero no debemos olvidarnos de la viabilidad económica del sector para que las propuestas innovadoras sean realmente efectivas, disruptivas y de alto impacto.
Ya se están viendo las consecuencias de no tener como prioridad la viabilidad económica en sectores como la ganadería. Debemos innovar hacia una agricultura
sostenible basada en un conjunto de estrategias que tengan tres prioridades claras: elevar el nivel y calidad de vida de la población, y mejorar la armonía con el medio ambiente.
siempre que sea medioambiental, económica y social; solo de esta forma será implementable y perdurable en el tiempo.
ALICIA CAÑADAS, DIRECTOR OF INNOVATION AT THE SCIENCE AND TECHNOLOGY PARK OF ALMERÍA AGRICULTURE: AN INNOVATIVE AND SUSTAINABLE BUSINESS
We are in a complex moment for the agri-food sector, to which are added restrictive factors such as the depletion of natural resources, food safety requirements...
Human beings contradict ourselves between what we do and what we say and, while our discourse is based on concern for what we eat, the data show us a different reality. We are committed to a healthy diet, but this is somewhat utopian when almost 3,100 million people cannot access it due to increased costs, for instance. Probably the biggest challenge in the sector is there, in the analysis of data like this and its causes.
We must reduce the factors that increase costs, and innovation and technology will play a fundamental role. I believe in sustainability, but as long as it is environmental, economic and social.

Presidentas de la Asociación Española de Economía Agroalimentaria.
El sector de frutas y hortalizas juega un papel estratégico en términos económicos, sociales, ambientales y culturales. El valor medio de su producción en 2021 ronda los 21.000 millones de euros y tiene una importante vocación exportadora. Además de su valor económico, este sector es un motor de empleo que dinamiza los territorios, es fuente de alimentos indispensables en una dieta saludable y contribuye a mantener la diversidad genética y el patrimonio cultural de las áreas rurales.
Situaciones de crisis como la pandemia del COVID-19 y la guerra de Ucrania, sumadas a un escenario marcado por el cambio climático, han provocado que el suministro alimentario vuelva a ser una preocupación importante para la sociedad y las administraciones públicas.
El sector de frutas y hortalizas se enfrenta a una situación de gran incertidumbre e importantes retos. El actual contexto, marcado por la crisis energética, ha provocado un preocupante incremento de costes en la producción, con consecuencias negativas tanto para la inflación y los consumidores
agroalimentario. Por otro lado, la producción hortofrutícola se caracteriza por su alta vulnerabilidad a un cambio climático que ya es patente y frente al que es necesario implementar con urgencia medidas de adaptación para mejorar su resiliencia y sostenibilidad. Si bien la producción extensiva de frutas y hortalizas conforma
paisajes culturales y contribuye a preservar la biodiversidad, la producción intensiva se enfrenta a una creciente y necesaria regulación ambiental que exige un cambio para combatir la contaminación y sobreexplotación de los recursos naturales. El reto de la sostenibilidad se extiende a toda la cadena alimentaria, que debe plantearse buenas prácticas para reducir su huella ambiental.
Las soluciones a estos desafíos pueden estructurarse en torno a tres ejes. En primer lugar, la innovación y la digitalización son ya importantes herramientas para abordar y convertir estos retos en una oportunidad de crecimiento. Cabe destacar entre estas, las innovaciones enfocadas al desarrollo de envases más sostenibles que permiten la reducción de plásticos y aquellas dirigidas a disminuir el desperdicio alimentario. Con ello se consigue un doble dividendo: mejorar la huella ambiental y la rentabilidad del sector. En segundo lugar, el marketing es otra herramienta importante para valorizar las producciones sostenibles, destacando como estrategias el desarrollo de etiquetas que garanticen el origen, la producción local y artesanal o la responsabilidad ambiental y social. Finalmente, la cooperación es una herramienta necesaria para facilitar el acceso de los medianos y pequeños agricultores a la innovación, la digitalización y el marketing, con lo que podrán incrementar su competitividad en los mercados y contribuir a una cadena más equilibrada. El papel de las cooperativas es esencial para lograr estos objetivos.
Una de las grandes fortalezas del sector de frutas y hortalizas español es su gran dinamismo. La voluntad de los agentes implicados y el apoyo del sector público serán imprescindibles para mantener su competitividad y afrontar con éxito estos retos.
EVA IGLESIAS AND MARGA BRUGAROLAS, PRESIDENTS OF THE SPANISH AGRI-FOOD ECONOMY ASSOCIATION.


THE WILL OF THE AGENTS INVOLVED AND THE SUPPORT OF THE PUBLIC SECTOR WILL BE ESSENTIAL
The fruit and vegetable sector exceeds 21,000 million euros. In addition, it is a driving force for employment. Crisis situations such as the pandemic and the war in Ukraine, added to climate change, have caused the food supply to once again be a major concern. The solutions to these challenges can be structured around three axes: innovation and digitization, marketing and cooperation. The will of the agents involved and the support of the public sector will be essential to maintain their competitiveness and successfully face these challenges.
La voluntad de los agentes implicados y el apoyo del sector público serán imprescindibles

Consejero en la industria alimentaria y CEO de Servycat.

Hacer predicciones sobre los escenarios que nos podemos encontrar en 2023 es una tarea ardua y difícil con un importante riesgo implícito que, seguramente, derivará
Gual, a pesar de todos los sistemas y herramientas disponibles para poder anticipar la marcha de nuestra economía, se continúa fallando de manera clara y contundente. Solo hace falta tirar de hemeroteca para ver y argumentaciones de importantes entidades y centros de estudios e investigación -
go. Eso sí, siempre cuando ya ha sucedido. Para el profesor Gual, la razón principal es el componente emocional de la economía, factor que, por el momento, ningún sistema es capaz de implementar.
Me parece un razonamiento muy aplicable a nuestro sector agroalimentario y, en concreto, a nuestro consumidor en su efecto más importante: la decisión de compra. A pesar de intentar sistematizar y racionalizar este acto, realmente en lo profundo, es un tema de emociones o de estado emocional. Sin darnos cuenta, aplicamos, por un lado, la racionalidad (ej. precio, marca blanca/distribuidor, saludable…), pero a la vez nuestro cerebro nos traiciona y, cuando consumimos, nos lleva a recordar con quién lo hacemos, qué nos generó de satisdecisión no se queda solo en puro objetivismo, también participa lo subjetivo.
Los escenarios del 2023 se vuelven más inciertos y difíciles, pues a la variabilidad objetiva económica se añade la reacción subjetiva del consumidor y, por tanto, el efecto real que puedan tener las medidas o situaciones que se vayan generando.
Cerramos el 2022, casi in extremis, con la adopción de una serie de medidas, en su mayoría esperadas desde hace tiempo y cuyo
efecto veremos en 2023. Por suerte, o acción de alguna mente lúcida, se descartaron otras opciones como la de limitar los precios o una mayor carga impositiva que hubieran generado efectos muy adversos en el medio/largo plazo, sobre todo para la parte más débil de la cadena de valor.
Nuestro mercado es muy diferente a otros y el intervencionismo -nunca deseable- debe ser sutil y medido, si no la complejidad del ecosistema agroalimentario genera mecanismos de defensa que acentúan más si cabe el desequilibrio entre oferta/demanda y, por ende, los precios y el potencial desabastecimiento. Ejemplos tenemos en nuestra historia para aprender y no aplicar. Pero volvamos al efecto emocional.
La bajada del IVA para determinados productos alimentarios supone añadir a la acción directa sobre el PVP (veremos en sí el impacto) dos hechos importantes:
1) Condicionar la generación de precio. De manera que elimina de forma directa que, al marcar el precio, se tenga en cuenta el efecto inflación. Un economista amigo acostumbrado a trabajar en países inflacionarios siempre me explicaba que el problema no era solo la inflación en sí, sino que estaba tan interiorizada que el mecanismo de creación del precio llevaba implícito el efecto de inflación y, por tanto, un incremento desmesurado del PVP.
2) Efecto placebo en el consumidor. De forma que ayude a no ralentizar en exceso el consumo con el “atractivo” del descenso regulado temporal del precio, generando un efecto directo sobre el bolsillo.
El resto de medidas aprobadas entran dentro del sentido común a aplicar en estos casos, si bien con muy distinto calado. Entregar 200 euros para consumo me parece una medida solidaria cortoplacista que aliviará momentáneamente la presión sobre el bolsillo a los más desfavorecidos. En cambio, sí me parecen muy positivas las ayudas al sector primario; su impacto en la elevación de costes (combustibles, fertilizantes, materia prima o factores climáticos con reducción de producción/productividad, quiebra logística…) está orientado a eliminar posibles cierres o disminuciones de producción de explotaciones que llevan tiempo bajo mínimos. Recordemos que estos primeros eslabones son los más débiles para afrontar periodos convulsos y de duras negociaciones con otras partes de la cadena de valor. Obviamente, esto discurre (no de forma total) por los diferentes elementos constitutivos (primario, secundario y terciario) en la formación del
Veremos los efectos de estas medidas en los próximos meses, tanto sobre los elementos del complejo sistema agroalimentario como en nuestro principal foco (consumidor), pues el resultado de buen seguro estará diferido en el tiempo. Y obviamente, generar una redistribución de valor en la cadena agroalimentaria, ese tan cacareado reequilibrio (hasta el momento claro desequilibrio) entre los eslabones, sobre todo primarios. Fomentar una agricultura -
cursos y prácticas propias de nuestro siglo y que están a nuestro alcance (tecnología, digitalización, sostenibilidad…) sin duda empoderará y llevará a darle el valor nece-
El esfuerzo de todo el ecosistema agroalimentario en estos años ha sido y está siendo superior a cualquier valoración que pueda hacerse. Según las cifras, la inflación en alimentación y bebidas no alcohólicas supera el 15%, mientras que el incremento de los costes principales constitutivos del escandallo productivo y operativo ha superado con creces estos valores, lo cual se traduce en que no todo el coste ha sido repercutido en el precio y, por tanto, ha ido a la merma ostensible del margen. Este hecho debe ser constatado y sabido, que no se busquen chivos expiatorios donde no los limitación y solidaridad.

Nos tendremos que enfrentar a un mercado que sigue una tendencia a la baja, acelerada en cantidad (-8,8%) y atenuada en valor (-2,5%), sobre el que hay que plantear la estrategia y plan de acción. Obviamente, abundarán las ofertas y promociones, descuentos
de productos más “estándar” o básicos con escasas opciones para nuevas apuestas o cambios. Si bien debemos ser conscientes de la ampliación del gap entre el consumidor cuyo foco es el precio del que continúa primando la calidad o la experiencia de compra. Ambos coexistirán y deberemos adaptarnos
Un consumo interno reprimido deberá
natural hacia otros posibles. En primer lugar, habrá que orientar esfuerzos hacia la exportación; nuestro sector ya tiene experiencia y consolida año tras año cifras de evolución y crecimiento, superando en octubre de 2022 los 50.000 millones de euros (+13,8 %) con un superávit de la balanza comercial por encima de los 10.000 millones. La participación de frutas, verduras, hortalizas y legumbres continúa liderando las exportaciones con más de 17.000 millones de euros (+5,4%). La apuesta por nuevos países fuera de nuestro entorno europeo, como EE.UU. o Canadá, favorecerá el ritmo de crucero mantenido y constante, consolidándose como
riesgos comerciales. Tendrá mucho que decir el tipo de cambio al que se sitúe el euro y, por tanto, las políticas que decida el BCE.
Existe un hecho de especial relevancia que afectará, ya veremos el grado, al precio: el impuesto al plástico de un solo uso. Según estimaciones, este coste adicional supondrá más o menos el ahorro en el IVA. Por la
primordial de conformación), seguramente su
traslado será paulatino y modulado, aplicado también teniendo en cuenta el impacto sobre el consumidor y el consumo. De buen seguro veremos acciones educativas de fomento de los productos a granel, envases reutilizables y de la gestión del desperdicio alimentario como sistemas de reducción del impacto de dicho impuesto.
La innovación ganará protagonismo dentro de las acciones operativas y estratégicas en nuestras empresas, es un vector fundamental para afrontar el escenario descrito y el desarrollo y evolución de las diferentes magnitudes econó-
Con una aceptación amplia del concepto, no solo dirigido a producto sino también a “nuevas formas de hacer y trabajar”. Aquí es clave la participación de nuestro “talento” en el aporte de ideas, mejoras, métodos y generación de cultura en la organización.
Me permito aportar un ejemplo centrado en el su restaurante La Boscana, hace una apuesta clara por introducir la fruta dentro de cada uno de los platos de su propuesta gastronómica, de forma que no la relega a un postre, que tantas veces entra en competición con el lácteo o el pastel de turno, sino que se genera un hilo conductor con diferentes alternativas de la fruta local, próxima, de la zona de Lleida. Innovar con un sentido práctico, de valor añadido, de dar algo más que posicione el producto (ej. marca, uso, facilidad de consumo, de acceso, concepto…).
Nuestros procesos productivos y operativos deben implementarse dirigidos al uso de herramientas clave en su aplicación que generen retornos tempranos y mejoras que
ayuden a ser más competitivos, reactivos y anticiparnos dentro de este entorno complejo. Conceptos como automatización, tecnología aplicada, transformación digital… necesitan incorporarse a nuestros sistemas en la formates? ¿Podemos mejorar nuestros costes constitutivos de nuestro escandallo? ¿Podemos generar mejores condiciones de trabajo que faciliten la incorporación de talento? ¿Gestionamos correctamente nuestra operativa, con la necesaria anticipación a las necesidades de nuestro cliente-consumidor? Realmente es necesario hacerse estas preguntas y generar proyectos técnicos viables económicamente, que den respuestas y posicionamientos que nos permitan procesos, metodologías, procedimientos adaptados a los nuevos requerimientos, liberándonos y generando una menor dependencia de los cambios y avatares que desde nuestra óptica no controlamos ni controlaremos.
La estabilidad, continuidad y cada vez carácter más estratégico ha supuesto que las empresas agroalimentarias formen parte de las carteras de estudio de inversores que hasta hace poco centraban sus recursos y esfuerzos en otras opciones. La particularidad de la composición y conformación de los elementos constitutivos (familiares, pymes, locales, especializadas, concentradas, imagen, …) las hace atractivas tanto por el negocio que desarrollan como muchas veces por los activos que atesoran. Otro hecho al que debe darse la importancia debida y que, en 2023, de buen seguro se plateará a muchos de los propietarios que deberán tomar decisiones respecto a términos como continuidad, legado, transformación, vertebración…. De una forma u otra influirá en el devenir del sector y su desarrollo.

El Gran Consumo es particular en muchos aspectos y se trata, seguramente, del mercado más básico y estable que existe. Todos tenemos que comer y beber, independientemente de cómo vaya la economía, por lo que el mercado actúa de forma similar a un transatlántico, repleto de estabilidad e inercia.
Esta es la razón de que el Gran Consumo se suela comportar muy bien en periodos de crisis, sobre todo si lo comparamos con otros sectores, pero también es el corsé que evita que el mercado pueda crecer a ritmos superiores a la evolución de la población, al menos en volumen. Así pues, la única manera que tenemos de crecer en este mercado es haciéndolo en valor por encima del volumen (y de la inflación), asignatura que, por ahora, estamos suspendiendo. Y no hablo del último año, sino de la última década. La siguiente, que encaramos ahora, va a ser decisiva para el Gran Consumo, ya que se va a resolver si los operadores encuentran el equilibrio necesario para crecer sosteniblemente o no. -
te, será difícil una vuelta atrás.
La experiencia demuestra que la manera más probable y sostenible de crecer como marca es si tu mercado también lo hace. Por tanto, todos los operadores tenemos un objetivo común: hacer crecer nuestra categoría. Más allá de las estrategias individuales, para los consumidores y el mercado lo mejor es que este último esté en equilibrio. Para ello, necesitamos el impulso de la renovación y mejora de los productos que empujan el precio al alza encarnados en la innovación, así como que el mainstream –productos más vendidos de la categoría–vaya bajando o conteniendo los precios para hacer los productos más accesibles
PROBABLE Y SOSTENIBLE DE CRECER COMO MARCA ES SI TU MERCADO TAMBIÉN LO HACE
(terreno típico de actuación de la marca del distribuidor).
Este modelo, donde una parte del mercado va agregando valor mientras otra democratiza los precios, asegura crecimientos a largo plazo y, paulatinamente, mejores productos
Para que el mercado esté en equilibrio es importante que todos los operadores ganen dinero y se genere una sana competencia. Si el mercado es tan exclusivo que no hay posibilidad de abaratar el mainstream,
nunca será un mercado grande y los consumidores deberán asumir el sobreprecio de un mercado de competencia imperfecta. Si, por el contrario, el mercado se banalizara al extremo de que el precio ya no fuese sostenible para las empresas de valor, la mejora constante se paralizaría e, incluso, daría pie a una recesión en la calidad de los productos en busca del siguiente céntimo de margen.
Para que los mercados estén en equilibrio, pues, necesitamos una sana competencia con marcas premium y low cost
Sin embargo, actualmente, tenemos un mercado desequilibrado en el Gran Consumo o, al menos, con un evidente peligro de desequilibrarse hacia el precio. La marca de la distribución crece sin freno, mientras que la innovación acumula una década de retrocesos constantes, situándonos a la cola de Europa.
La consecuencia de todo esto es un mercado incapaz de crecer en valor por encima del volumen desde la crisis de 2008. La causa del desequilibrio es el creciente poder que
han adquirido algunos operadores con respecto a otros. Los que compiten por precio, insertos a su vez en una batalla intestina y dotados de un gran poder de negociación, arrastran el mercado hacia el low cost, desangrando márgenes propios y ajenos, y abocándonos al abismo.


No obstante, aún estamos a tiempo de evitar esta situación y de cambiar el rumbo ante lo que se vislumbra como la última oportunidad para el sector.
THE LAST CHANCE
The mass consumption is particular in many aspects and it is, surely, the most basic and stable market that exists. We all have to eat and drink, regardless of how the economy is doing. This is the reason why it tends to behave very well in periods of crisis, but it is also the corset that prevents the market from growing at rates higher than the evolution of the population, at least in volume. Thus, the only way for us to grow is in value, a subject in which, for the moment, we are failing.
The most likely and sustainable way to grow as a brand is if your market does
too. Therefore, all operators have a common objective: to grow the category. To do this, we need the boost of product renewal and improvement to push prices up embodied in innovation, as well as for the mainstream – best-selling products – to lower or contain prices to make products more accessible. This model ensures long-term growth and, products for everyone.
For the market to be balanced, it is important that all operators make money and that healthy competition is generated with premium and low-cost brands.



A día de hoy, la buena reputación de la agricultura española está fuera de toda duda. Y no es casualidad, sino el resultado del buen trabajo realizado desde hace décadas, cumpliendo con todos los controles sanitarios, adaptándonos -sin fisuras- a nuevas normas y a la legislación nacional e internacional, cumpliendo con las necesidades de nuestros clientes y de los consumidores, produciendo incluso cuando la pandemia lo puso más difícil, garantizando el abastecimiento de la población en todo momento y, siempre, ofreciendo la mayor calidad, por mencionar algunos aspectos. Todo ello, con la mirada en el futuro, apostando por el empleo en el ámbito rural, la modernización tecnológica y la sostenibilidad del sector.
Mantener esa buena imagen sin defraudartros es el principal objetivo que nos marcamos en la próxima década. Pero sabemos que no será fácil. Tenemos por delante unos años en los que el nivel de burocracia y los controles al sector agrícola se van a modula urgentemente, acabe por expulsar a la parte más débil de la producción.
En la Región de Murcia, la amenaza constante del recorte del Trasvase Tajo-Segura pone en el foco la incertidumbre en cuanto a la cantidad de agua de que vamos a disponer, su calidad y cuál será su precio. Sin duda, es uno de los puntos que más nos preocupa, pues sin agua no hay agricultura. Pero también las nuevas leyes que, como nos ocurre muy a menudo, no tienen en consideración las particularidades del sector. Ya lo hemos
visto con el nuevo impuesto del plástico y sabemos que seguirá ocurriendo.
No obstante, podemos presumir de ser un sector con una gran capacidad de adaptación y resiliencia. Estoy convencido de que, aunque con esfuerzo y sacrificio, conseguiremos superar todas las trabas que surjan en el camino y, como hasta ahora, será una oportunidad para salir fortalecidos. Con toda probabilidad, los nuevos requerimientos de las leyes europeas darán lugar a un sector más profesionalizado, en el que ganarán fuerza los desarrollos tecnológicos y terminarán de posicionar a la agricultura española como una de las más avanzadas del mundo.
Así que no nos queda más que pensar que todos lo cambios que están por venir, y las batallas que vamos a tener que lidiar, son asimismo una oportunidad para, por un lado, poner en valor todo el trabajo que llevamos hecho hasta ahora, y por otro, seguir mejorando y demostrar que somos capaces de cumplir con los estándares que nos demandan la sociedad y el planeta.
Con todo ello, no solo saldrán beneficiadas las empresas y los profesionales
del campo, sino también quienes cada día consumen nuestros productos y por quienes haremos todo lo que sea necesario para que sigan disponiendo de las mejores frutas y hortalizas del mundo, las producidas en el sureste español.

Today, the good reputation of Spanish agriculture is beyond doubt. Maintaining that image without disappointing those who trust us is the main objective we have set for ourselves in the next decade. But it will not be easy. We have a few years ahead of us in which the level of bureaucracy and controls on the agricultural sector are going to intensify, which, if it is not urgently modulated, will end up expelling the weakest part of production.
In the Region of Murcia, the constant threat of cutting the Tajo-Segura transfer is one of the points that worries us the most, but also the new laws, which do not consider the particularities of the sector. However, I am convinced that, although able to overcome all these obstacles and, as up to now, they will be an opportunity to emerge stronger.









CEO de Naturcode.
“En el campo, cuanto más, mejor, con la mayor calidad posible, y ya nos dirán el precio”. “Al cliente solo le importa el prey sostenibilidad solo valen para añadir más gastos”, “el problema de los precios está en la distribución”, etc. ¡Cuántas veces he-

La pandemia ha quebrado el último bastión de lo analógico, el acceso masivo por QR a la información digital. Silenciosamente, la curiosidad de los consumidores está penetrando en lo más profundo de la cadena agroalimentaria y sus efectos positivos serán inevitables en este cambio de paradigma. El problema real de la cadena siempre ha sido el mismo y no existían las condiciones para cambiarlo; se puede resumir en una frase de Sócrates: “El origen de todo mal es la ignorancia”. No obstante, aunque hay quien opone resistencia, la vacuna está inoculada y haciendo efecto, los no vacunados corren un riesgo muy elevado.
contrarrestadas por numerosos estudios. El último de ellos lo publicaba hace una semana el Consejo Económico Social de la Mesa de Participación de Asociaciones de Consumidores (MPAC), cuya Encuesta de Hábitos de Compra y Consumo 2022 revelaba que el precio no es ya el único motivo de compra de los consumidores. Ahora priman otros factores como el origen, la sostenibilidad, la responsabilidad corporativa y la calidad nutricional, aspectos que los consumidores (73%) están intentando re-
conocer de manera muy activa en Internet, pues casi tres cuartas partes (71%) consien las etiquetas físicas. Además, exigen y valoran las producciones sostenibles, las marcas solidarias con compromiso social y, sobre todo, ponen especial atención a la satisfacción de otros usuarios.
En paralelo, está la cuestión del etiquetado. Los consumidores demandan información transparente e imparcial del productor, no publicidad. A pesar de ello, algunas marcas continúan destinando importantes presupuestos a QRs de cuestionable parcialidad en paquetes, etiquetas y lineales, a través de los cuales el consumidor accede a plataformas de información como COCO, Yuka o Real Food, y que tratan de informar sobre aspectos nutricionales basados en algoritmos controvertidos como NutriScore, pero solo de las marcas cuya información de sus productos esté digitalizada. En España, estas suponen poco más del 13% de las casi 900.000 referencias existentes.
Pero el etiquetado debe elaborarse con la colaboración de nuestros distribuidooponga) para ofrecerle al consumidor lo que pide: información veraz, transparente e imparcial, que permita trazar el origen del alimento o la bebida y contenga todos sus datos nutricionales. Los consumidores ya no somos sujetos pasivos, queremos tomar decisiones de compra conscientes en base a los datos. Queremos saber, por ejemplo, qué diferencia un plátano de Canarias de una banana dejando de lado cuestiones como el precio; o un aguacate ecológico de Ecuador de uno ecológico bajo la normativa europea, y qué impacto tienen estas diferenciaciones en nuestra salud y la del planeta.
En resumen: el consumidor va a tener información holística del producto más temprano que tarde. El precio tiene su cabida, pero no es el único factor clave en las decisiones de compra, y los datos imparciales y transparentes procedentes del consumidor serán fundamentales para la rentabilidad y sostenibilidad en la cadena agroalimentaria.
Esta es la visión que compartimos y nos mueve en Naturcode desde hace años. Creemos que, como ya ha ocurrido en el sector turístico, las estrellas en los hoteles y la relevancia de la cadena a la que pertenecen son solo una orientación. Lo que verdaderamente ha cambiado las reglas del juego ha sido el empoderamiento del usuario con sus valoraciones y reseñas,
DEL CONSUMIDOR SERÁN LA CLAVE PARA LA RENTABILIDAD Y SOSTENIBILIDAD EN LA CADENA
capaces de igualar entrañables y coquetas pensiones con hoteles de cinco estrellas. De este modo, el consumidor alza la voz contra la pandemia de la ignorancia.
Permítanme, como hijo de agricultor, despedirme con una pregunta: ¿imaginan lo ilusionante que será rentabilizar y hacer con la ayuda directa del consumidor?

The pandemic has broken the last bastion of analogue, the massive access to digital information by QR. Quietly, consumer curiosity is penetrating the depths of the agri-food chain and its positive effects will be inevitable in this paradigm shift.
Now factors such as origin, sustainability, corporate responsibility and nutritional quality prevail, aspects that consumers are actively trying to recognize on the Internet, since almost three quarters (71%) consider the informaaddition, they demand and value sustainable production, solidarity brands with a social commitment and, above
all, they pay special attention to the satisfaction of other users.
In parallel, there is labelling. Consumers demand transparent and impartial information from the producer and the labelling must be elaborated with the collaboration of our trusted distributors to offer them what they ask for. Consumers are no longer passive subjects, we want to make conscious purchasing decisions based on data.
Price has its place, but it is not the only key factor in purchasing decisions, and impartial and transparent data from the and sustainability in the agri-food chain.
Los consumidores tienen una mayor preocupación e interés por la trazabilidad y formas de producción de los alimentos. La importancia de aspectos como la huella hídrica o la mejora en la gestión de los recursos está aumentando, y se precisará de tecnología que contribuya a aumentar la eficiencia y sostenibilidad de la producción agrícola.
Nuestras propuestas en agricultura innovadora están focalizadas, precisamente, en so-
tes que logren una agricultura viable para los agricultores y den respuesta a las demandas de un mercado concienciado y competitivo. Para ello, desarrollamos nuestras líneas de negocio y productos siempre en torno a dos grandes temas: el agua y el clima.
El foco de nuestro I+D está en el desarrollo de tecnologías para una agricultura sostenible -
ción de la huella hídrica, Green Deal, Farm to Fork, residuo cero, etc.) y digital, la puesta en valor del dato, de manera que se disponga de información del medio, cultivo y clima para realizar una adecuada toma de decisiones.
En este sentido, y dentro de la línea de negocio de horticultura protegida, perseguimos un diseño y fabricación de invernaderos más herméticos para impedir la entrada de plagas y, por tanto, menos dependientes de -
mitan generar un óptimo microclima con un manejo inteligente de los parámetros decisivos para el desarrollo de los cultivos.
Por otro lado, el encarecimiento de la energía ha sido el detonante de proyectos energé-
nuevo modelo de ‘Invernadero Agrovoltaico’ que reduce la huella de carbono, y prevemos seguir realizando instalaciones de riego para viña, frutales y leñosos con bombeo solar, donde se ha logrado un consumo cero, amortizando rápidamente la inversión.
No cabe duda, asimismo, de que un factor clave en el futuro será el ahorro de agua. Y esto nos lleva a la implementación de sistemas de aprovechamiento de la lluvia, recogida de drenajes y desinfección de agua para su reutilización; además de nuevos tratamientos como las nanoburbujas, que oxigenan y mejoran la calidad del agua, aumentando el desarrollo radicular de las plantas sin generar residuos.
En los próximos años serán fundamentales, asimismo, los modelos de Agricultura de Precisión con sensores interconectados que recogen y emiten datos en tiempo real.
elaborar modelos predictivos según las necesidades de cada suelo, clima y cultivo, proporcionando información al agricultor para la implementación de acciones basadas en parámetros objetivos, y poder realizarmento y cantidad adecuada.
La innovación debe estar siempre presente si queremos llegar a alimentar a la población prevista en 2030. Actualmente, la agricultura vertical es incipiente en España, pero ha pasado de algo casi experimental a concebirse como una propuesta real con altas posibilidades de crecimiento en un futuro. Llega a ahorrar un 95% de agua, es libre de pesticidas y capaz de producir alimentos los 365 días del año.
Existe asimismo un aumento del interés por sistemas de alimentación sostenibles y de proximidad. Los principales retos en este caso son la alta inversión necesaria en los modelos existentes. Desde Novagric trabajamos en propuestas alternativas a los modelos indoor, mediante sistemas de vertical farming facilitar el acceso a esta modalidad agrícola con proyectos como Greendomo o Vertical Sunning, y la introducción de nuevas especies de cultivo, dado que ahora está muy limitado a hoja verde.
En conclusión, apostar por la inversión en tecnología agrícola garantizará el futuro de una agricultura capaz de generar nuevos modelos de negocio, formas de empleo, contribuir a la soberanía alimentaria y al desafío del cambio climático.
JUAN PARDO, HEAD OF R&D AND GREENHOUSES AT NOVAGRIC. WE MUST GENERATE NEW BUSINESS MODELS

Consumers are more concerned about traceability and forms of food production. The importance of aspects such as the water footprint or the improvement in the management of resources is increasing, and technology will be required to in-ability of agricultural production.
Our proposals in innovative agriculture are focused on technically and achieve viable agriculture for farmers and respond to the demands of an aware and competitive market. We develop our business lines and products around two major themes: water and the climate. The focus of our R&D is on the development of technologies for sustainable and digital agriculture.
Innovation must always be present if we want to be able to feed the expected population in 2030. Investing in technology will guarantee the future of an agriculture capable of generating new business models, forms of employment, contributing to food sovereignty and the challenge of climate change.
Co-Founder Across The Shopper.
Analizando cuáles van a ser las vías de crecimiento de las categorías alimentarias en un futuro próximo nos encontramos con 4 gran-
mente, nos hemos basado en estos 3 ejes de consumo: la salud, el placer y la conveniencia. Pero, desde hace ya algún tiempo, debemos añadir uno más: la conciencia.
La preocupación por la sostenibilidad medioambiental es un factor cada vez más presente en la mente del consumidor y, aunque la situación económica actual puede penalizar las opciones más sostenibles y priorizar las de precio, es un deber de las empresas fabricantes y distribuidoras pensar en términos de reducción del impacto medioambiental. En un futuro muy cercano, no será un factor diferencial, sino una condición indispensable para poder ser elegido por el consumidor.
Al margen del cuidado del planeta, aparece otro tipo de conciencia: la social. Lo local y lo artesano/auténtico son un refugio emocional, aunque de nuevo, no a cualquier precio.
Un aspecto muy relevante en términos de sostenibilidad y muy sensible para el consumidor es la lucha contra el desperdicio alimentario y el aprovechamiento. Ahorro y conciencia se dan la mano.
Pero si tenemos que decantarnos por un eje más a largo plazo, este es, sin duda, la salud. Todos conocemos la frase ‘la salud no tiene precio’; es claramente una de las áreas de oportunidad. En este sentido, frutas y hortalizas tienen mucho territorio conquistado frente a los productos procesados. Además, la pandemia nos ha traído el concepto de ‘inmunidad’ asociado a los alimentos y esta ‘funcionalidad’ tiene un gran recorrido.
Hay que tener en cuenta que el consumidor busca alimentos que combinen salud y placer, no un alimento funcional puro, pero sí con una
y salud, por ejemplo, suele resultar mucho más rentable que centrarse exclusivamente en un único eje. Los ganadores serán aquellos que combinen 2 o más ejes y que, además, sean percibidos como ‘ahorro’ frente a otras alternativas. Es cierto que el precio será una prioridad para el consumidor en los próximos años, pero no nos olvidemos de estos 4 ejes para competir con otros argumentos.
XAVIER CROS, CO-FOUNDER ACROSS THE SHOPPER. HOW WILL THE FOOD PRODUCT CATEGORIES GROW?

Según el último estudio que hemos realizado desde Across The Shopper, ‘Tensiones alimentarias en relación con la salud’, en España, 2 de cada 3 adultos siguen algún tipo de hacen en mayor medida.
Analyzing what the growth paths of food categories are going to be
pillars of development. Historically, we have based ourselves on 3 axes: health, pleasure and convenience. But, for some time now, we must add one more: awareness.
EL CONCEPTO
Conciencia y salud son, por tanto, dos ejes prioritarios en la realidad actual, pero la alimentación siempre tendrá en cuenta el placer (sabor) y la conveniencia (productos que faciliten la vida al consumidor).
Podríamos concluir que, cuando hablamos de una opción ganadora en alimentación, la clave está en ser capaces de aglutinar en una misma propuesta por lo menos dos de estos ejes. Mezclar placer y salud o conveniencia
Concern for environmental sustainability is an increasingly present factor in the consumer’s mind and it is a duty of manufacturing and distributing companies to think in terms of reducing environmental impact. Apart from caring for the planet, another type of conscience appears: the social one. But if we have to opt for a more long-term axis, this is, without a doubt, health.
When we talk about a winning option in food, the key is to be able to bring together at least two of these axes in the same proposal and that, in addition, they are perceived as ‘savings’ compared to other alternatives.
¿Cómo crecerán las categorías de producto en alimentación?
Gerente de Sostenibilidad de AECOC AECOC.
Desde el pasado 1 de enero, España es el único país de la Unión Europea que tiene en vigor un impuesto a los envases de plástico no reutilizables, tal y como preveía la Ley de Residuos aprobada el pasado 8 de abril. Otros países, como Italia, también plantearon su puesta en marcha años atrás y han ido aplazando su imposición hasta, como mínimo, el 2024, para evitar nuevos sobrecostes a las empresas en un contexto de inflación sin precedentes en más de tres décadas.
AECOC y otras asociaciones representantes de sectores como el textil, perfumería y cosmética, bricolaje, bebidas, restauración o productos electrónicos, explicamos reiteradamente el gran impacto económico, los sobrecostes y la pérdida de competitividad que el impuesto generaría a las empresas, especialmente a las pymes.
En concreto, FIAB cifra en 690 millones de euros los sobrecostes que generará el impuesto en las empresas, tanto por la liquidación de la tasa como por las adaptaciones y trámites administrativos que son necesarios para su cumplimiento. Por otra parte, el hecho de ser el único país de la Unión Europea con un -
petitivo para nuestras empresas, que desde el pasado 1 de enero compiten en situación de desigualdad respecto a las compañías del resto del continente.
para generar una petición transectorial que, remarcar que los motivos para reclamar el aplazamiento del impuesto al plástico fueron estos. Las empresas de los principales sectores con la reducción de los plásticos de un solo uso. De hecho, las compañías españolas van por delante de la legislación para la gestión del plástico: según los datos de Eurostat, España se sitúa
entre los países con mejores ratios de reciclaje de envases de plástico (51,4%), por delante de naciones como Alemania, Francia o Italia y del conjunto de la media europea (37,7%).
Medidas como el rediseño, la reducción de peso de los envases o la reutilización son comunes entre las estrategias de las empresas españolas para tratar de minimizar la presencia del plástico en envases y embalajes.
Si se insistió en el aplazamiento de la puesta en marcha del impuesto al plástico es porque llega en el peor momento posible y no supone una mejora en los objetivos en sostenibilidad. Tan solo introduce una medida recaudatoria.
Además de la entrada en vigor del impuesto al plástico, las compañías se enfrentan a otros retos en el ámbito de la sostenibilidad y la economía circular. Durante el último Consejo de Ministros de 2022 también se aprobó el esperado Real Decreto de Envases y Residuos de Envases, con medidas como la obligación de los establecimientos minoristas de vender a granel las frutas y verduras frescas cuando no estén envasadas en lotes de 1,5 kilogramos o más. A pesar de que la norma pretende reducir el uso de envases, puede acabar conllevando que los consumidores reduzcan su compra de frescos y opten por formatos más convenientes. Y, cómo no, pone en riesgo la prevención
del desperdicio alimentario, ya que el envase incrementa la durabilidad de los alimentos.
Las empresas del gran consumo y, en concreto, los socios de AECOC son abanderados en la lucha contra el cambio climático. Según nuestro ‘Informe anual de sostenibilidad’, el 100% de las compañías realiza acciones para mejorar la circularidad de sus envases y embalajes y el 75% cuenta con estrategias para descarbonizar sus procesos, por lo que muchas compañías ya van por delante de los ambiciosos objetivos que marca Europa.
CINTA BOSCH, AECOC SUSTAINABILITY MANAGER. PLASTIC TAX: NEW EXTRA COSTS AT THE WORST MOMENT

only country in the European Union with a tax on non-reusable plastic containers.
AECOC and other associations representing sectors explained the huge economic impact, the extra costs and the loss of competitiveness that the tax would generate.
FIAB estimates the additional costs that it will generate in companies at 690 million euros, both due to the payment of the tax, as well as the adaptations and administrative procedures necessary for its compliance.
The plastic tax comes at the worst possible time and does not mean an improvement in sustainability objectives. It only introduces a revenue collection.

El sector hortofrutícola vive desde hace varios meses una fase incierta y llena de cambios. Por un lado, como en otros sectores, estamos luchando contra el aumento de los costes en logística, embalaje y mano de obra. Por otra, la tasa de inflación en Europa ha alcanzado niveles récord y muchos consumidores no pueden permitirse fácilmente responder a estas subidas de precios. De que los aumentos salariales puedan compensar la inflación en su totalidad, o al menos en parte, depende nuestro sector. A todo ello se suma que los últimos 24 a 30 meses ya fueron bastante difíciles debido al COVID-19, y fueron meses en los que, dependiendo de la cartera de clientes (restauración, industria transformadora o retail), estabas entre los ganadores o los perdedores.
Esa situación demostró claramente que una cartera de clientes equilibrada aumenta las posibilidades de éxito y la supervivencia de una empresa. Para ser honesto, esta no es realmente una idea nueva, pero, como suele suceder, solo en tiempos difíciles como estos te das cuenta de cuáles pueden ser las consecuencias. Por supuesto, una reorientación parcial o una reestructuración de una empresa no es cosa fácil y, por lo general, no se puede llevar a cabo en poco tiempo, y más aún cuando la ‘tormenta perfecta’ del mercado ya está en marcha.
Desde nuestro punto de vista, los siguientes tres puntos serán aún más importantes en nuestro futuro:
1. Contacto aún más cercano con clientes y proveedores
Nuestros clientes y proveedores también tienen que hacer frente a la competencia y a las cambiantes condiciones del mercado. A través de una cooperación estrecha y abierta, se pueden encontrar soluciones conjuntas, aunque esto no siempre es fácil. Por un lado, se deben conocer los deseos y requisitos del
cliente y, por otro, la capacidad de desempeño del proveedor. La experiencia demuestra que, cuando los cambios o problemas se abordan rápidamente y con mente abierta, la solución suele ser más satisfactoria. Una buena y próspera cooperación se basa, sobre todo, en una adecuada asociación en la que todos los participantes tienen que hacer compromisos apropiados, incluidos nosotros.
2. Seguir reinventándose Dormirse en los laureles puede parecer cómodo y absolutamente relajante, pero uno pierde la comprensión del mercado y la capacidad de responder a sus realidades actuales y futuras. Nuestro trabajo es satisfacer las necesidades de nuestros clientes, y estas no se quedan igual para siempre. Al contrario, los cambios se están produciendo a un ritmo cada vez más rápido. En nuestro mundo efímero, es muy importante reconocer lo que se está haciendo bien y estar dispuestos a mejorar lo que no, y que afectará a nuestra organización interna.
3. Innovación y anticipación Todos conocemos estos dos términos imqueremos generar nuestra contribución al mercado abasteciendo a los clientes, sino también ayudar a dar forma al mercado. Esto solo es posible alineando adecuadamente los sensores en todas las direcciones. Se trata,
principalmente, de reconocer las lagunas en las gamas, establecer nuevas variedades, crear nuevas combinaciones de productos, trabajar en las tendencias del mercado con -
añadido para el cliente en la medida que le siga mereciendo la pena que trabajemos juntos o que los nuevos se vinculen con nosotros.
Por supuesto, seguiremos lidiando con todas las demás alegrías y problemas de nuestro sector.
DANIELE D’ADDIO, PRODUCT MANAGER OF THE SWISS IMPORTER PPO SERVICES AG.

IT IS NECESSARY TO HAVE A BALANCED CLIENT PORTFOLIO
We are struggling with rising logistics, packaging and labor costs and the inflation rate in Europe has reached record levels. In addition to all this, the last 24 to 30 months have already been difficult enough due to COVID-19.
This situation clearly demonstrated that a balanced client portfolio increases a company’s chances of success and survival. But a partial reorientation or a restructuring of a company is not an easy thing and cannot be carried out in a short time.
The following three points will be important: Even closer contact with customers and suppliers, keep reinventing yourself, and innovation and anticipation.



Para seguir siendo un sector líder en la próxima década, debemos salir fuera y llegar a todos los mercados con productos premium y variedades protegidas en pro de los agricultores, y dejar de lado los commodities. Además, será necesario
En Rivoira, en los últimos años, hemos invertido en la compra de derechos de nuevos productos a nivel mundial para desarrollar nuestro negocio desde la producción basada en frutas con propiedad intelectual. Ahora trabajamos para dotar de valor esos conceptos y convertirlos en garantía, con calidad organoléptica homogénea. Esto nos permitirá ofrecer al mercado un negocio win win, donde agricultor y consumidor se convertirán en un binomio de productos mejorados que cubran necesidades reales de mercado. Así, el productor gana y garantiza su futuro, y el consumidor valoriza los productos en pro del sabor y el placer de una alimentación rica y saludable.
Los commodities, en cualquier caso, seguirán siendo importantes en el mercado, destinados a consumidores que buscan precio; pero lo serán más en el desarrollo de países que son competitivos en costes y que pueden afrontar este tipo de agricultura tan competitiva.
Nosotros concebimos los productos premium y las variedades vegetales protegidas como el resultado del I+D. Actualmente, tenemos programas de desarrollo de ciruelas, kiwis, cerezas, nectarinas y manzanas, y disponemos de campos de
investigación para llevarlos a cabo y lanzar al mercado productos que sabemos que ofrecen un valor diferencial.
En Rivoira queremos ser referentes en el futuro de la agricultura; por ello, no nos quedamos solo en el desarrollo interno de la variedad, sino que trabajamos codo a codo con los agricultores ofreciéndoles programas ad hoc uno de ellos. Asimismo, colaboramos en el desarrollo en campo de los distintos cultivos, que monitorizamos durante 5 años.
En conclusión, el agricultor debe cambiar su mentalidad hacia la búsqueda del rendimiento y enfocarse en una agricultura
dole disfrutar de productos premium. La agricultura debe centrarse, por su parte, en la apuesta por el desarrollo varietal de nuevos productos.
Las empresas tenemos que liderar este cambio y apostar por la investigación para poder hacer realidad este proceso e ir de la
mano del agricultor. En Rivoira hace añosdemos que este tiempo de investigación y desarrollo continuo nos permitirá aportar nuestro granito de arena hacia un futuro real y sostenible para nuestra agricultura y la continuidad del sector.
A WIN-WIN BUSINESS STRATEGY



To continue being a leading sector in the next decade, we must go out and reach all markets with premium products and protected varieties, leaving commodities aside. In addition, it will be necessary to diversify.
At Rivoira we have invested in the purchase of rights to new products worldwide and now we are working to add value to these concepts and turn them into a guarantee, with homogeneous organoleptic quality. This will allow us to offer the market a win-win business, where farmer and consumer will become a pair of improved products that meet real market needs. Thus, the producer wins and guarantees its future, and the consumer values the products in favour of the flavour and pleasure of a rich and healthy diet.
Director de Producción del grupo multinacional SanLucar.
La gestión de la agricultura está viviendo una mutación en los últimos años, en gran parte por la creciente adopción de tecnología. La generalización del uso de plataformas digitales, la madurez creciente del hardware en el agro, el incremento de capacidad computacional y AI, la institucionalización del sector, así como una democratización del acceso a la tecnología para el campo son en parte responsables de tal fenómeno.
Son tiempos de cambios para todos y la agricultura no está exenta de ellos. Nos enfrentamos a retos como los fenómenos climáticos extremos, el aumento generalizado de costes de producción por presión inflacionista, los conflictos bélicos o el impacto de la pandemia en los hábitos de consumo. Un panorama que muchos han bautizado ya como la crisis de las 3 C (climática, conflictos y COVID-19) y frente al cual las soluciones mencionadas dibujan una nueva realidad del sector agroalimentario.
Estas tecnologías dejan de ser percibidas como una opción y pasan a postularse como elementos imprescindibles para la me-
biental, así como optimización general de costes variables. Las diferentes tecnologías existentes ayudan en los distintos procesos de control de la producción: desde la medición de datos a través de la sensorización de parámetros, pasando por el registro de los mismos, el análisis a través de inteligencia de negocio, la integración de algoritmos de previsión de enfermedades, cosechas y medición del secuestro neto de carbono, así como la robotización de procesos fácilmente automatizables.
Todos estos elementos están cambiando el proceso tradicional de toma de decisiones basado en la experiencia de campo y el análisis de datos a veces no tan dinámicos. En SanLucar, la disponibilidad de estas innovaciones
ha contribuido a la evolución de nuestros procesos hacia una metodología híbrida que integra el conocimiento exhaustivo del campo con la integración de las tecnologías existentes. El resultado es un proceso que nos permite anticiparnos, leer mejor las necesidades de las personas y de las plantas, y todo con un mismociencia y, por supuesto, mayor sostenibilidad.
El uso de tecnologías digitales está siendo, además, un vector para la sostenibilidad de

de consumo de recursos y promoviendo la regeneración de los ecosistemas en los que trabajamos. El uso de sistemas modernos de riego combinados con la integración de la sensorización de dichos sistemas nos permite reducir el consumo de recursos hídricos, así como limitar las pérdidas de riego. De la misma manera, la fertilización de precisión, el estudio dinámico de los parámetros nutricionales, así como el análisis por imagen dron y satelital de las cubiertas vegetales favorecen la optimización del uso de recursos nutricionales y la mejora en el secuestro neto de carbono de nuestros procesos.
En SanLucar, implementamos tecnologías para asegurarnos de que nuestros consumidores tienen a su alcance un producto fresco, sano y natural, y que vela al tiempo por el cuidado de su salud y la del planeta. Los distribuidores pueden ofrecer a sus clientes
un producto diferenciador y en línea con sus compromisos y necesidades. Y los productores dan continuidad a una actividad, la agricultura, que resulta crucial para la sociedad.
The management of agriculture has undergone a mutation in recent years, largely due to the growing adoption of technology. The generalization of the use of digital platforms, the growing maturity of hardware in agriculture, the increase in computing capacity and AI... are partly responsible for such a phenomenon.
These are times of change. We are facing challenges such as extreme weather events, rising costs, wars or the impact of the pandemic on consumer habits. A scenario that many have already baptized as the 3 C´s crisis (climate, conflicts and COVID-19) and against which the aforementioned solutions draw a new reality of the agri-food sector.
These technologies start to be postulated as essential elements for im-
the traditional decision-making process and, in SanLucar, the result is a process that allows us to anticipate, better read the needs of people and plants, and all with the same objective: more flavour, better quality,
Profesor doctor de Economía y Empresa de la Universidad Europea.

Las perspectivas de la economía española no son tan favorables para el año 2023, debido al contexto de enorme incertidumbre y los tiempos convulsos de guerra, inestabilidad internacional y cambio climático.
Durante el año 2022, España ha experimentado un crecimiento del Producto Interior Bruto del 4,5%; sin embargo, las previsiones más optimistas reducen ese crecimiento a una tercera parte para el 2023, aunque por encima de la media prevista para la economía europea, ya que el estancamiento económico afectará al conjunto de la UE. El Gobierno español, no obstante, sigue esperando un crecimiento
1. Desarrollo de productos y aplicaciones tecnológicas que garanticen la seguridad alimentaria y propiedades nutricionales de los alimentos.
2. Industria auxiliar, con el desarrollo de nuevos materiales y envases en línea con las demandas del consumidor.
3. Promoción de la seguridad alimentaria y calidad de las frutas y hortalizas desde una perspectiva integral de salud.
4.mos para combatir plagas y enfermedades.
5.
continuado del empleo y una reducción de la tasa de paro, situándose por debajo del 10% de la población activa en 2025. La inflación tardará meses en desaparecer, con un riesgo real de que se haga crónica, y las subidas de los tipos de interés pueden provocar menos inversión y un posible incremento de la deuda pública y privada.
Por eso, cobran más sentido la necesidad de articular políticas macroeconómicas consensuadas que reduzcan la incertidumbre, gestionando de forma ágil los fondos europeos, mejorando la productividad de las empresas, fomentando el aprendizaje permanente e impulsando el diálogo social.
La industria agroalimentaria española debe tener, sin lugar a dudas, un papel principal en la necesaria resiliencia y para lograr la demandada recuperación económica. El sector alimentario ha tenido un enorme protagonismo en los últimos años con un crecimiento constante, siendo el sustento esencial de la economía, y alcanzando el 8% del PIB de España. Este sector ha tenido una enorme capacidad de arrastre,
industrial del país, con 31.000 empresas que tienen una capacidad de exportación de 17.000 millones de euros.
El sector agroalimentario genera 4 millones y medio de empleos en toda Europa y solo el de las frutas y hortalizas en España tiene más de 200.000 empleos directos, a los que hay que añadir 150.000 indirectos en labores de manipulación y envasado.
Somos el primer productor de frutas y hortalizas de la UE y el quinto a nivel mundial. Los principales productos exportados son hortalizas de invernadero (tomate, pimiento y pepino), cítricos, melocotón y nectarina.
La producción del sector de frutas y hortalide 1.815.446 hectáreas y agrupa a un número muy diverso de productos, que van desde la producción intensiva de hortícolas de invernadero hasta el secano extensivo de los frutos de cáscara.
Existen muy variadas y pujantes oportunidades de negocio y retos para el sector agroalimentario, como el desarrollo de productos y aplicaciones tecnológicas que garantizan la seguridad alimentaria y las propiedades nutricionales de los alimentos. De esta manera se puede hacer frente a la progresiva crisis alimentaria provocada por la guerra de Ucrania que sufren los países en vías de desarrollo.
Otras oportunidades de negocio están en la industria auxiliar de frutas y hortalizas, que
desarrolla su actividad vinculada al envasado de los diferentes tipos de productos. El desarrollo de nuevos materiales y envases debe ser una prioridad para satisfacer a un consumidor cada vez más exigente, en continuo cambio y con más sensibilidad a la necesaria transición ecológica y lucha contra el cambio climático. Estas exigencias de calidad, los cambios en el estilo de vida y la globalización de mercados son factores muy a tener en cuenta a la hora de desarrollar las nuevas oportunidades de negocio.
Además, la perentoria necesidad de aplicar la biotecnología en la industria alimentaria amplía las oportunidades de negocio vinculadas a la producción, promoviendo la seguridad alimentaria y la calidad de los alimentos desde una perspectiva integral de la salud, que permite aprovechar las tendencias sociales más naturales y saludables. Otras oportunidades interesantes son aquellas actividades enfocadas a la identilas plagas y enfermedades, y la elaboración
ECONOMIC DEVELOPMENT AND THE CHALLENGES OF THE AGRI-FOOD SECTOR IN SPAIN
The prospects for the Spanish economy are not so favourable for 2023, due to the context of enormous uncertainty and the turbulent times of war, international instability, and climate change. In 2022, Spain has experienced a growth of the Gross Domestic Product of 4.5%; however, the most optimistic forecasts reduce that growth to a third for next year.
Inflation will take months to disappear and interest rate rises may lead to less investment and a possible increase in public and private debt. For this reason, the need to articulate consensual macroeconomic policies makes more sense. And the agri-food industry must
play a leading role in the necessary resilience and to achieve the demanded economic recovery.
There are various business opportunities and challenges for this sector, such as the development of products and technological applications that guarantee food safety and the nutritional properties of food. Others are in the auxiliary fruit and vegetable industry, the development of new materials and packaging or the urgent need to apply biotechnology, in addition to the opportunities focused against pests and diseases, and the
 JOSÉ MANUEL CORRALES, PHD PROFESSOR OF ECONOMICS AND BUSINESS AT THE EUROPEAN UNIVERSITY.
JOSÉ MANUEL CORRALES, PHD PROFESSOR OF ECONOMICS AND BUSINESS AT THE EUROPEAN UNIVERSITY.
Responsable de Marketing de Sorma Group.
El cambio climático, la sostenibilidad de la producción y el envasado, los nuevos mercados potenciales y la reducción de las devoluciones en la fase de venta son los principales retos a los que se enfrentará el sector hortofrutícola en un futuro próximo. La clave fundamental para responder a todos estos factores es la innovación tecnológica. Los centros de procesado de frutas y hortalizas tendrán que estar cada vez más automatizados y, gracias a la integración de nuevas tecnologías relacionadas con la Industria 4.0 y el Big Data, ya se están mejorando todavía
pesaje y envasado. La automatización en lacontrar mano de obra, al tiempo que hace más sostenible la cadena de suministro, reduciendo costes y garantizando una estandarización de alta calidad. Además, permite al sector atender con celeridad las distintas demandas del mercado, cambiando fácilmente los parámetros de -
mente la introducción de nuevas variedades.
En este contexto, hay empresas tecnológicas que ya ofrecen una respuesta proyectada hacia el futuro. Es el caso de Sorma Group, con un catálogo de 59 máquinas que responden a las características de la Industria 4.0, que se interconectan al sistema informático de la fábrica y pueden ser controlables a distancia. Los sistemas de telemantenimiento y telediagnóstico, las actualizaciones de las cantidades procesadas y los tiempos de preparación también se mantienen activos en remoto. Además
cada máquina conectada a la red local.
Entre las nuevas soluciones más punteras que tenemos en catálogo se encuentra la última versión del software de visión de Sorma, InstanDefect-AI, basado íntegramente
sistemas de deep learning, que garantizan -
lices/pedúnculos de los frutos junto con una
detección avanzada de defectos externos y de
cates, con una altísima productividad (hasta 8 frutas/segundo por línea).
Para el sector de la manzana, presentamos en Interpoma una nueva línea de llenado y cierre de bandejas de cartón que permite pasar rápidamente de un formato de bandeja a otro gracias a un software que memoriza los diferentes ajustes; y la versión actualizada de Aporo, el revolucionario Pick & Place, fruto de la investigación neozelandesa y del que Sorma Group es distribuidor en Europa y Sudamérica, capaz de colocar en las bandejas 8 manzanas a la vez, con el tallo en la misma dirección y con el mejor lado visible.
hemos buscado materiales alternativos con la revolucionaria línea Sormapaper. Se trata de redes en varios formatos fabricadas con celulosa y papel FSC totalmente reciclables. Entre los formatos se encuentra también el Vertbag, que reúne todas las características del impresión, ligereza, robustez, transpirabilidad y posibilidad de ver el contenido- con el uso de materias primas procedentes de fuentes renovables. Todas las soluciones de envasado de Sorma también están diseñadas para dar espacio a la comunicación de la marca y a las características del producto mediante el uso de tintas al agua de bajo impacto medioambiental.
MARIO MERCADINI, HEAD OF MARKETING AT SORMA GROUP. TECHNOLOGICAL INNOVATION, KEY TO FACE THE CHALLENGES OF THE FUTURE
Processing centers will have to be increasingly automated and, thanks to the integration of technologies related to Industry 4.0 and Big Data, -
Las novedades tampoco faltarán en 2023; de hecho, en Fruit Logistica, Sorma Group presen-mente para tomates en racimo.

ENVASES
En este segmento de negocio, la industria avanza hacia envases sostenibles capaces de conservar el producto el mayor tiempo posible. Por un lado, con soluciones de redes fabricadas con un 40% menos de plástico que las redes estándar, compensadas con una banda de puede separar fácilmente (línea Sormapeel). Por otro lado, para los clientes corporativos que plastic free’,
tion, weighing and packaging are being improved. This automation will compensate for the lack of labour, while making the chain more sustainable, reducing costs and guaranteeing quality. In addition, it allows the sector to meet the different demands. There are technology companies that already offer a response projected towards the future, such as Sorma Group, with a catalogue of 59 machines that meet the characteristics of Industry 4.0, which are interconnected to the factory’s computer system and can be controlled remotely.
DISEÑADA PARA TOMATES EN RACIMO
La innovación tecnológica, clave para enfrentarse a los retos del futuro

ISABEL FERNÁNDEZ
“Gracias a este tipo de soluciones logramos un control muy detallado de las distintas operaciones que se han ejecutado en la explotación, tratamientos aplicados, rendimientos obtenidos, así como también controlamos el inventario de insumos, de modo que logramos un mejor aprovechamiento de los recursos, también los naturales”, explica.
LAS HERRAMIENTAS QUE VIENEN

Al igual que las herramientas de gestión para las empresas agroalimentarias, otras como el portal del empleado o el Software As a Service (SaaS, 100% nube) también están en auge. Facilitan la comunicación entre la propia empresa, trabajadores, clientes y proveedores; evitan la duplicidad de tareas, optimizando tiempo y recursos; y permiten el acceso a la información en cualquier momento y desde cualquier lugar. “Hablamos de herramientas relacionadas con la movilidad, ya no información en el sistema, basta con un móvil y una app”, explica. Además, el pago por uso comienza a popularizarse entre las compañías del sector.
situación económica es que la optimización de costes y procesos no es ya una opción, sino una obligación, y la transformación digital, la vía para lograrla. Y es que la elevada inflación ha evidenciado la necesidad de controlar cada céntimo
reduciendo costes, y para ello es crucial la implementación de herramientas que ayuden a la toma de decisiones. En tiempos de incertidumbre, contar con la información precisa en el momento oportuno puede marcar la diferencia.
“Las empresas se están dando cuenta de que, mientras mayor información tenga el decisor de negocio y más fácil sea el acceso a esta, más fácil será también la toma
MIENTRAS MAYOR
INFORMACIÓN TENGA EL DECISOR DE NEGOCIO, MÁS FÁCIL SERÁ LA TOMA DE DECISIONES
director comercial de Gregal Soluciones Informáticas. Precisamente por ello, solo en el último año, Gregal Soluciones Informáticas ha visto crecer la demanda de soluciones de gestión de explotaciones agrarias, que permiten controlar cada paso desde la producción a la manipulación del producto.

HORIZONTE 2030
Pero esto no ha hecho más que empezar. “Si echamos la vista 10 años atrás, se ha producido un cambio importante, pero en los próximos siete será mucho mauna mayor profesionalización del sector agroalimentario sustentada sobre la automatización de procesos, la sensorización de las explotaciones y el uso de más y mejores herramientas predictivas basadas en -
vencido de que se va a producir un vuelco en el uso de los sistemas de información que hacen las empresas agroalimentarias”, comenta, y apunta a un aspecto clave: “Las compañías agroalimentarias son cada vez más grandes y, como tales, demandan un mayor control sobre su actividad, de ahí la importancia de lograrlo a golpe de clic”.
Optimizar costes es una de las fórmulas para contrarrestar la inflación y, desde Gregal Soluciones Informáticas lo tienen claro: la tecnología es la mejor aliada para lograrlo.JAIRO HERNÁNDEZ, DIRECTOR COMERCIAL DE GREGAL SOLUCIONES INFORMÁTICAS.
Certis Belchim cuenta con una amplia y reconocida cartera de productos Bio-racionales registrados (formulados con materias activas de origen natural). Son productos eficaces que posicionados adecuadamente en un programa IPM con productos convencionales, nos permiten producir frutas y hortalizas sin residuos.
Recientemente, se ha incorporado al proyecto Growing For The Future una nueva gama de bioestimulantes y nutrientes especiales que proporcionan una mayor rentabilidad de las producciones y una mejora en la calidad.
Vamos a detallar el caso de éxito en cultivo de lechuga iceberg en primavera. En una parcela se implementó el programa Growing For The Future frente a otra en la
El proyecto Growing For The Future es una propuesta de valor de Certis Belchim para toda la cadena alimentaria, cuyo objetivo es el control de plagas y enfermedades mediante el monitoreo e implementación de programas de cultivo con soluciones adaptadas a las exigencias del consumidor y los supermercados, y a la nueva directiva europea ‘De la Granja a la Mesa’.
que se siguió una estrategia convencional. En la primera, se combinaron productos convencionales con Bio-racionales con el fin de alcanzar un buen estado sanitario del cultivo. Para el control de lepidópteros se utilizó Mimic® en la primera semana de cultivo, continuando con Delfin® y Turex®. En el control de áfidos se usó la estrategia con Mospilan® Max al inicio del cultivo, seguida de Botanigard® en programa y tratamientos puntuales con Majestik® y Breaker® Max. Además, estos productos poseen efecto secundario en mosca, trips y araña.

El control fungicida a nivel foliar se centró en el uso de Amylo-X®, mientras que, a nivel radicular, se incorporó Tri-Soil®, potente fungicida para proteger las raíces de enfer-

medades como Phytophthora spp, Fusarium spp, Phythium spp y Rhizoctonia spp.
Para estimular el desarrollo del sistema radicular al inicio del cultivo se aplicó Incrementum® Root, seguido de Pushy+®, un bioestimulante que mejora el desarrollo y vigor de la planta, así como la acción de los microorganismos aplicados al suelo.
En la parcela en la que se siguió la estrategia Growing For The Future se realizó un control satisfactorio de plagas y enfermedades, consiguiendo reducir un 63% el número de materias activas de síntesis química, así como el nivel de residuos en fruto y se alcanzó un mayor beneficio económico por el incremento en la producción.
La actual situación geopolítica dibuja una nueva coyuntura social y económica a cada segundo, obligando al sector a ser más versátil que nunca, adaptándose a cada nuevo contexto con agilidad y sin perder de vista retos globales como el cambio climático, los avances hacia una agricultura más sostenible y la digitalización de un campo que no puede seguir envejeciendo.
Son las dos palabras que más resuenan entre las empresas de los distintos sectores económicos a nivel global. La guerra en Ucrania y su impacto en el aumento de los costes de las materias primas, la inflación, las distintas legislaciones en marcha… obligan al sector hortofrutícola a hacer gala de su resiliencia, esa capacidad de adaptación que siempre le ha caracterizado y que hoy, si cabe, resulta más importante que nunca.
¿Pero en qué contexto nos movemos? Detallamos cuatro factores claves:
1. Incertidumbre económica. La inflación, que al cierre de 2022 se situó en un 5,7%, pero que supera el 15% en el caso de los alimentos, augura un estancamiento del valor del gran consumo, así como un descenso de su volumen de venta.
2. Nuevo marco legislativo. La Unión Europea (UE) no parece dispuesta a renunciar a su gran objetivo en el horizonte 2050, alcanzar la neutralidad de emisiones; aunque para ello haya que reducir el uso de
para los productores, o aumentar la super-

A nivel nacional, el impuesto al plástico no reutilizable, en vigor desde el pasado 1 de enero -solo en España, el resto de países europeos han postpuesto su aplicación-, supone nuevos sobrecostes para un sector donde los márgenes comerciales se siguen reduciendo. La buena noticia es la eliminación o reducción del IVA de los alimentos en marcha hasta el próximo mes de junio; sin embargo, esta medida, en combinación con el citado impuesto al plástico, deja los precios al consumidor, prácticamente, como estaban.
3. Contención y ahorro. Son, según NielsenIQ, las dos palabras ‘mágicas’ para el consumidor, que ha vuelto a aupar el precio entre sus drivers de consumo, tensando aún más su relación con la gran distribución. Esta, por su parte, pone la gestión de la inflación en el centro de su estrategia y, cual satélites, dos aspectos más: la protección de su margen y la disponibilidad de producto en el lineal que debe seguir asegurando.
4. Cambio climático. Solo en la última campaña, ha afectado a las distintas cosechas en España y Europa, provocando en algunos casos mermas productivas más que considerables.
Teniendo en cuenta todo esto, el sector hortofrutícola debe trazar ahora una nueva hoja de ruta que garantice su supervivencia en el medio y largo plazo. El reto está en ha-
cerlo en este entorno tan volátil, que, como reflexiona en esta misma edición Enrique de los Ríos, director general de Unica, “cambia a cada momento”. Agilidad y adaptación son, por tanto, las claves para navegar en este mar revuelto.
Un año de cosechas cortas
No es solo Putin quien ha encarecido la cesta de la compra. Si algo ha caracterizado a la agricultura en 2022 han sido los efectos del cambio climático. La subida de las temperaturas medias, los episodios de heladas fuera de los periodos habituales, los golpes de calor, y toda serie de inclemencias meteorológicas han mermado gran parte de de frutas y hortalizas en el mercado. La borrasca Ciril sufrida en abril se ha convertido en el peor fenómeno meteorológico de carácter puntual sufrido por el campo español desde hace más de 40 años. En Cataluña y Aragón per-
dieron el 60% de la producción prevista en fruta de hueso y un 20% en fruta de pepita, en la Comunidad Valenciana el kaki registró pérdidas de hasta un 50% del volumen, en melón y sandía otro tanto… y así sucesivamente en toda España y en prácticamente todos los cultivos.
Por otra parte, la sequía derivada de esta situación climática también ha contribuido gravemente a reducir las cosechas en volumen y calibre de los frutos.


Una renta insuficiente Según la ley de la oferta y la demanda, esta situación de menor oferta y mayor coste, unida a la subida generalizada de los costes de producción derivados de la guerra en Ucrania, ha supuesto un aumento del precio
del producto. De hecho, en el conjunto de la Unión Europea, en 2022 los precios de la mayoría de los productos agrícolas se incrementaron un 24% durante el año pasado, en comparación con el anterior, de acuerdo con la estimación preliminar realizada por Eurostat. Sin embargo, el balance de las campañas no ha sido bueno. ¿Por qué? En primer lugar, las cotizaciones percibidas no han compensado las pérdidas registradas en producción, que han sido demasiado elevadas. En segundo lugar, el incremento del coste de los insumos ha disminuido el margen del agricultor. Y, por último, estos costes no se han podido repercutir en el producto al 100% por parte del productor.
En sostenibilidad, ni un paso atrás Los requerimientos del Pacto Verde mar-
Foto: Aitor Borruel Gárate.cados por la UE responden a esta difícil situación medioambiental a la que nos enfrentamos. De hecho, el Comisario euen la entrevista que publicamos en esta edición, urgencia en el ámbito sostenible para poder seguir proporcionando alimentos a una población mundial en aumento. Es el momento de acelerar las inversiones que garanticen la transición verde. Como señala Eduardo Baamonde, presidente de Cajamar, “el reto de la sostenibilidad debemos contemplarlo no desde la óptica del imperativo legal, sino como una necesidad para mejorar
también al uso de los fertilizantes y a la lucha contra las plagas y enfermedades, al manejo del suelo y al desarrollo de bioproductos”. En esta línea, ante la falta de materias activas y la necesidad de producir más, el sector debe apostar por el control biológico y otros métodos sostenibles como alternativas con garantía de rendimiento. Asimismo, el sector tiene que cerrar sus circuitos de energía y materiales y aplicar estrategias de economía circular y bioeconomía para aprovechar hasta el último gramo de nuestras producciones, convirtiendo los subproductos en oportunidades de negocio. Y todo elevándolo a la fórmula de la máxima transparencia hacia el consumidor, cada día más responsable y comprometido, y que exige cada vez más información sobre el origen y proceso que siguen los alimentos. No hay marcha atrás.
Ese es el objetivo del sector hortofrutícola, que debe trabajar en 5 líneas estratégicas si quiere garantizar su supervivencia.
1. Afrontar retos globales desde la unidad. Y es que, parafraseando de nuevo a Enrique como la última frontera del sector agroalimentario español”. El diálogo y la solidaridad empresarial serán claves.

2. Mejora de la eficiencia. El contexto inflacionario actual requiere de soluciones que permitan a las empresas minimizar costes maximizando resultados. Las nuevas tecnologías, automatización, roboti-
el mayor sentido de la palabra debe llegar para quedarse. Pero no solo el sector debe hacer los deberes; las políticas verdes europeas y españolas también exigen mayor agilidad a la Administración, por ejemplo, en la autorización de materias activas y soluciones biotecnológicas para unos cultivos más sostenibles.
3. Reorganización del mercado. La demanda de productos de proximidad, entre ellos frutas y hortalizas, continúa al alza y desde el sector productor se afanan en apuntar a la UE como el mercado local del producto español -que lo es-. Ahora bien, es fundamental dirigir la mirada también al mercado doméstico, a nuestro país, cuyas importaciones crecen a un ritmo frenético (el 21% solo hasta el pasado mes de octubre).
4. Relevo generacional. Seis de cada 10 profesionales del campo se jubilarán en la próxima década, de modo que, según el informe ‘Agro-millennials agricultores y ganaderos del siglo XXI’, de COAG, el sector necesitará 200.000 nuevos agricultores en los próximos años. En este
CEO de Patatas Meléndez, “la tecnología tiene un papel crucial y es una vía para acercar a los jóvenes al campo y luchar contra la despoblación rural”.
5. Comunicación con el consumidor. La actual situación económica ha agudizado los consumidores visita hoy un mínimo de tres establecimientos a la hora de hacer la compra, que ahora basa en la MDD. Sin embargo, no renuncia a la calidad y exige una mayor transparencia a la cadena. Quiere saber la procedencia de aquello que compra, y es que, aunque el precio vuelve a ser determinante, salud y sostenibilidad siguen en su top de prioridades.
The current geopolitical situation draws a new social and economic context at every second, forcing the sector to be more versatile than ever, adapting to each new situation with agility and without losing sight of global challenges such as climate change, a more sustainable agriculture and the digitalization of crops.
These are the two words that most resonate among companies in different economic sectors globally, in the agricultural one too. But in what context do we performe? We detail four key factors:
1. Economic uncertainty.
2. New legislations, both in the European Union and in Spain.
3. A consumer focused on containment and savings.
4. Climate change. The rise in temperatures, episodes of frost, heat stroke and all series of inclement weather have reduced much of -
sector cannot take a step back in sustainability.
We must work on 5 strategic lines:
1. Face global challenges from unity.
2.
3. Market reorganization.
4. Attracting young farmers.
5. Communication with the consumer.
“Estos datos están basados en la información que nos facilitan las empresas, aquellas que no aparecen es porque no responden o no han querido participar”

Oferta y demanda de melón y sandía no discurrieron de forma paralela durante el último ejercicio, generando tal presión en los mercados que los precios se dispararon, ayudando a rentabilizar una campaña con volúmenes muy por debajo de años anteriores.
ISABEL FERNÁNDEZ
EL CLIMA, PROTAGONISTA
Seguro que muchos de ustedes recibieron el pasado verano algún meme invitándoles a pedir un préstamo para comprar una sandía o, cuando menos, a pagarla a plazos. Esta era la imagen que el consumidor tenía del mercado: alguien se está lucrando tanto con este producto, y también con el melón, que comprarlos era casi prohibitivo. Pero nada hubo más lejos de la realidad.
13,4% en el caso de la sandía y un 16,5% en el del melón, y la producción un 27,4% y un 23,6%, respectivamente. Esta merma productiva fue fruto, por un lado, de los malos resultados de la campaña anterior, que ya auguraban una reducción de las hectáreas; pero sobre todo de las lluvias persistentes desde febrero hasta prácticamente mayo, que retrasaron plantaciones en Murcia y obligaron a replantar o desistir en el intento en el caso de los ciclos tempranos. Y todo ello aderezado con una calima que ‘vistió’ los frutos.
“Todo esto afectó a los rendimientos de los cultivos”, recuerda Carlos Nemesio, responsable del programa de sandía de Anecoop,
1. Mejora en la gestión del producto: punto de corte, logística…
2. Más calidad en los formatos midi, “pueden generar mayor demanda
3. Continuidad de la calidad durante todo el ciclo.
quien añade un factor más a la ecuación: la demanda sostenida durante, prácticamente, 10 semanas en Europa como consecuencia de las altas temperaturas. “No fue superior a otros años, pero sí constante”, tanto que “nos ha permitido mantener unos niveles de precios que nos han ayudado a rentabilizar el cultivo”. Y eso a pesar del aumento de los costes de producción, que el sector cifra en torno al 30%.
LA DEMANDA EN EUROPA NO FUE SUPERIOR A OTROS AÑOS, PERO SÍ CONSTANTE
En Castilla-La Mancha, el resultado no fue diferente al logrado en Almería, Murcia o
cayó hasta situarse en apenas 5.000 hectáreas de melón y 2.800 de sandía, según la Interprofesional de Melón y Sandía de Castilla-La Mancha. Y lo hizo, por un lado, por el “temor” a no rentabilizar los cultivos, como

1. Calidad y sabor consistentes.
2. Formatos más adecuados a las unidades familiares actuales.
3. ‘Rejuvenecer’ al consumidor (más del 70% de los consumidores de piel de sapo, por ejemplo, supera los 50 años).
SANDÍA
• 21.489 ha
• 1.003.226 Tn
• 511 mill. € exportados
MELÓN
• 16.017 ha
• 498.566 Tn
• 294 mill. € exportados
otro, porque “tenemos una dotación de agua muy escasa”.
producción también más baja y, por consiguiente, precios más altos, de 0,32 €/kg, de media, para el melón y unos 0,46 €/kg para la sandía. “Tuvimos una campaña muy equilibrada entre oferta y demanda”, comenta
recuperar el nivel de exportaciones de 2020, superando el 40%.
A pesar de los buenos resultados del último ejercicio, desde el sector apelan al sentido común. Son conscientes de que los altos precios son el resultado de una serie de factores, algunos controlables y otros no, que difícilmente se volverán a repetir. Y lanzan un aviso: “Si continúa sin llover y, además, se mantiene el recorte del trasvase Tajo-Segura, que afecta a la zona norte de Almería, Murcia y Alicante, la situación será muy complicada”, lamenta Nemesio, quien reconoce que, hoy por hoy, es mucha la incertidumbre en el sector.

“Estos datos están basados en la información que nos facilitan las empresas, aquellas que no aparecen es porque no responden o no han querido participar”

La drástica reducción en la mayor zona productora de fruta de hueso y pepita, Cataluña, ha hecho que España sea el país que mayor merma ha tenido a nivel europeo esta campaña. Este descenso productivo, generalizado en los últimos años debido al cambio climático, está definiendo los ejercicios más recientes en Europa.
Tras una campaña 2021 con la menor producción histórica de fruta de hueso en el conjunto de los países europeos, en 2022 se produce una recuperación generalizada a excepción de España (-31%). Así, por segundo año consecutivo, las heladas primaverales provocaron importantes pérdidas en la fruta de hueso. Esta merma productiva fruto del cambio climático en los últimos años tiene su aspecto positivo en aquellas zonas que no han sufrido tanto la reducción de volumen: a menor oferta, mayor cotización de la fruta en el mercado. Una situación que se puede revertir en cuanto se alcance, en un año climático menos accidentado, el potencial productivo del sector. Es el temor de muchos operadores que, a la vez que trabajan por recuperar sus volúmenes, son conscientes de este riesgo. “Los arranques tras el veto ruso y el cambio climático han hecho bajar la producción, pero en cuanto tengamos una campaña normal, atravesaremos de nuevo una crisis”, argumenta convencido Miguel Ángel Gómez, gerente de la Asociación Frutícola Extremeña (Afruex). Mientras tanto, la búsqueda de mano de obra, el desarrollo de variedades de sabor, los altos costes de producción, la implantación de tecnología antiheladas y antigranizo, la sequía… protagonizan el cartel de desafíos de las diferentes zonas productivas de España.
CATALUÑA
- Líder nacional en melocotón y nectarina.
- Campaña pasada: 70% menos de fruta respecto a su capacidad productiva.
- Principal desafío: implantación de sistemas antihelada y antigranizo + variedades mejor adaptadas.
Solo hace 45 años se vivió una situación parecida a la pasada campaña, donde la borrasca Ciril provocó mermas de hasta el 70% de la fruta, por lo que desde el sector confían en que se trate de un hecho aislado. Sin embargo, el cambio climático no deja grandes certezas en su tendencia, solo que las temperaturas serán cada vez más altas y los episodios climáticos más extremos. Hecho que lleva al sector a apostar por seguir implantando los sistemas antiheladas y antigranizo en sus plantaciones ante los resultados de los últimos años. “Esta última campaña ha llevado a una situación complicada a las empresas catalanas, algunas han tenido que hacer Ertes para cubrir los costes
En el ámbito varietal, programas españoles pioneros como Fruit Futur trabajan para desarrollar variedades más adaptadas a climas más cálidos, con el objetivo de hacer frente al cambio climático.

EXTREMADURA
- Ciruela, paraguayo y cereza.
- Campaña pasada: volumen de producción similar a la anterior, problemas de calidad en la primera parte.
- Principal desafío: falta de mano de obra y sequía.
La escasez de agua ha sido un factor limitante en la calidad y calibre de los frutos esta pasada temporada, asunto que representa todo un reto para el sector extremeño en los próximos años. De forma paralela, Miguel Ángel Gómez, gerente de Afruex, sostiene que están trabajando las contrataciones en origen para esta temporada, dada la necesidad de mano de obra que no puede cubrir el sector. Las consecuencias del nuevo impuesto al plástico, que incrementará los aumentando el volumen de burocracia para el sector, son otras de sus preocupaciones. “El descenso de los niveles de consumo no se queda atrás en nuestro frente de prioridades, haciéndonos poner el foco en la promoción y el desarrollo de variedades de sabor”, detalla Gómez.
ANDALUCÍA
- Nectarina, melocotón, albaricoque.
- Campaña pasada: correcta en producción y en el ámbito comercial.
- Principal desafío: falta de mano de obra.
El balance de la Comunidad andaluza en fruta de hueso fue positivo en la pasada campaña, según sostiene el presidente del Comité de Fruta de Hueso de Fepex y gerente de la empresa Sintesis, Pepe Rodríguez. “Nos habíamos marcado como objetivo aumentar el precio un 25-30% para cubrir el incremento de costes y el mercado nos lo devolvió sin mucho esfuerzo”, detalla. Son la sequía, que esperamos se esté resolviendo con esta temporada de lluvias, y la falta de mano de obra, los aspectos que más preocupan al sector de cara a la próxima campaña.
- Melocotón, nectarina, paraguayo y albaricoque (20% de la producción nacional).
- Campaña pasada: 20% de reducción de la producción con respecto a la anterior.
- Principal desafío: reducir los altos costes de producción.
“Podría haber sido una campaña excepcional pero los altos costes no
gerente de Apoexpa. La región padece el incremento de insumos generalizado, pero, además, esta campaña, los costes logísticos para exportación han estado disparados, especialmente los contenedores, y eso ha repercutido en el balance de la campaña murciana, que no ha podido aprovechar al máximo el mercado incipiente de países terceros. Su reto, por ahora -con avanzados sistemas de aprovechamiento de agua y disponibilidad de mano de obra (debido a la sucesión de cultivos) superados-, está en ser más productivos y optimizar aún más sus procesos en almacén y campo.

MEDIA
2016-2020
20212022* VARIACIONES Act vs Ant Act vs Media
ITALIA1.398.851951.8241.343.29441%-4%
GRECIA782.606465.780763.80064%-2%
ESPAÑA1.641.8541.390.009955.852-31%-42%
FRANCIA317.453220.871325.13147%2%
TOTAL4.140.7643.028.4843.388.07712%-18%
Fuente: Europech (MAPA).
-
sumo en estos productos y continúa importando en gran medida, siguiendo la tradición desde antaño, manzanas de Francia e Italia y peras de Bélgica y Holanda. El sector nacional ha ido, en los últimos años, renovando su oferta varietal y cambiando a zonas de producción más altas para obtener una mejor calidad. Sin embargo, es aún difícil cambiar esta tendencia comercial, ya que el consumidor cambio está en marcha para los productores de Lleida y Girona en esa apuesta por llegar a un público más joven y que opta por el sabor, y vendrá acompañado en los próximos años de campañas de promoción transgresoras como la que han lanzado con la manzana desde Afrucat con ayuda de los fondos europeos.
A nivel productivo, estos cultivos también están a merced del cambio climático, cuyos efectos se están intentando amortiguar con la instalación de mallas antihelada y antigranizo que están ya instauradas en una proporción de más de un 50% en Cataluña y de hasta un 75% en zonas como Girona. Es una muestra de las importantes inversiones que el sector está dispuesto a llevar a cabo para impulsar y poner en valor estos cultivos en el mercado. Son importantes estas inversiones, ya que, solo en la pasada campaña, sufrieron debido al clima una reducción del 30% de su potencial y una bajada de su aprovechamiento comercial, tanto en manzana como en pera.
El camino hacia la sostenibilidad de la agricultura pasa por las soluciones biológicas, donde la empresa Symborg juega un importante papel.
La adquisición de Symborg por parte de la multinacional estadounidense Corteva Agriscience el pasado mes de septiembre acelerará el desarrollo de la cartera de productos microbiológicos sostenibles disponibles para el sector agrícola. “La integración con Corteva es una oportunidad para reforzar nuestro impacto en el campo ayudando a los agricultores frente a los desafíos actuales y futuros, constituyendo la pareja perfecta para diseñar el futuro de la agricultura”, sede Symborg.
de 60 países de todo el mundo, ha ayudado con su extensa cartera de productos y durante más de una década, a maximizar el rendimiento de los cultivos mientras a su vez ayuda a preservar los hábitats y ecosistemas. La compañía posee patentes de bioestimulantes de origen natural que per-

y ponerlo a disposición de la propia planta, proporcionando una fuente de nitrógeno alternativa y suplementaria y reduciendo potencialmente la emisión de gases de efecto invernadero por el uso de fertilizantes.
rector de Marketing de Symborg, hay cuatro tendencias clave que impulsan el crecimiento de productos biológicos: protección del medio ambiente, tensión regulatoria, alimentos más seguros y prohibición de materias
activas. “Necesitamos una combinación de soluciones biológicas y químicas tradicionales que brinden una respuesta efectiva y sostenible a lo que buscan, tanto consumidores como legisladores”, señala Domínguez. En posicionado para satisfacer esta demanda.
“El objetivo de Symborg siempre ha sido apoyar a los agricultores de todo el mundo con soluciones biológicas de vanguardia”,
“Esta motivación, junto con un equipo alta-tirnos en un actor clave para la agricultura sostenible”, añade.
Las instalaciones de Symborg en Murcia, Unidos, México, Perú, Chile, Brasil, Francia, Turquía, China y Australia se convertirán en elementos clave de la cartera de productos biológicos de Corteva.

“Estos datos están basados en la información que nos facilitan las empresas, aquellas que no aparecen es porque no responden o no han querido participar”

El sector de los cítricos español cierra una campaña 2021/2022 para olvidar y abre una nueva con claroscuros, marcada por un fuerte descenso productivo, elevados costes y un consumo en España y Europa en retroceso. La buena noticia es que los cítricos siguen entre las frutas preferidas del consumidor, de ahí que haya motivos para el optimismo.
ISABEL FERNÁNDEZ
“La merma ha sido muy acusada en las variedades tempranas”, lamenta Pedro Sánchez, director general de Canso. Y no solo eso, en todas las zonas de producción, los calibres han sido inferiores a los habituales.
De cara a la segunda mitad del ejercicio, las expectativas son algo más halagüeñas y, de hecho, ya desde principios de enero, los precios en origen comenzaron a repuntar. Ahora bien, si la campaña será o no rentable es algo aún difícil de dilucidar, sobre todo teniendo en cuenta el incremento de los costes de producción (+30%, según el sector) y si estos podrán o no trasladarse en su mayor parte al PVP.
LA PRODUCCIÓN, A LA BAJA
España no es, en cualquier caso, el único país del hemisferio norte que experimentará un descenso de su cosecha de cítricos. Es más, según los últimos datos de la World Citrus Organization (WCO, por sus siglas en inglés), solo dos países aumentarán su producción: Grecia (+11%) y Egipto (+8%).

La 2021/2022 fue una campaña en negativo para los cítricos españoles, cuya producción cayó un 5%, hasta situarse en torno a los 6,8 millones de Tn. Sin embargo, este menor volumen cosechado no se tradujo en mejores precios para el sector que, según la Unión de Uniones, dejó de ingresar 618 millones de euros, un 26% menos.
“El mercado de los cítricos mostró síntomas de cansancio”, recuerda Miguel Abril, director comercial de Anecoop, quien apunta que, de hecho, “entre enero y junio, incluso las importaciones de naranjas cayeron un 30%”. Y, ni siquiera así, el mercado respondió.
La campaña 2022/2023 no ha comenzado mucho mejor. En este caso, las lluvias de la pasada primavera, unidas a las olas de calor del verano, la falta de agua para riego y el propio cansancio de los árboles, auguran una merma superior al 15%, situando la cosecha en unos 5,9 millones de Tn, la más corta de la última década.
“La cosecha de este año es una de las más pequeñas de las últimas temporadas -25 millones de Tn, un 13% menos- en el hemisferio norte debido a los problemas meteorológicos en los principales paíImbert, de la Secretaría Técnica de la WCO, quien añadió que, pese a todo, este continúa siendo “un mercado prometedor”. Y es que los cítricos se mantienen como una de las frutas líderes en el mercado mundial. Solo en la última campaña, su comercio global alcanzó los 15 millones de Tn, el 21% del total, que ascendió a 71 millones de Tn. Además, de las 10 frutas más comercializadas a nivel mundial, tres
3 AMENAZAS
• El aumento de costes y la inflación.
• Plagas como la falsa polilla y el cotonet, ya presentes en España; el HLB, cuyo vector ya se ha detectado en Portugal; y la Xylellafastidiosa, presente también en el país vecino en cítricos y, por tanto, por primera vez en la UE.
• El crecimiento de países competidores como Egipto, cada vez más cerca de superar la producción española de naranjas.
• La garantía de calidad y sostenibilidad medioambiental, social y económica de la producción española.
• La entrada de los fondos de inversión, que contribuyen a concentrar la oferta en un sector muy atomizado.
• La puesta en marcha del Corredor Mediterráneo, que agilizaría la logística desde España al centro de Europa.
son cítricos: naranjas, que ocupan el tercer puesto de este ranking; easy peelers (mandarinas), en cuarto lugar; y limones, en el noveno.
La oportunidad, por tanto, existe, y la menor cosecha prevista este año en todo el hemisferio norte, lejos de suponer un hándicap, puede contribuir a poner en valor un producto muy del gusto del consumidor. Eso sí, capturar un mayor consumo no se prevé una tarea fácil.

¿Y EL CONSUMO?
Y es que, en Europa, el consumo va en retroceso (-3%, en la última campaña), incluida España. De hecho, según el último Informe de Consumo Alimentario 2021 del Ministerio de Agricultura, su peso en la cesta de la compra de los españoles cayó un 11,9% en volumen y un 14,6% en valor con respecto a 2020.
Aun así, el sector puede, y debe, dar un giro a esta situación, apostando por una mayor organización de la oferta, un producto con una calidad homogénea durante todo el ciclo y, además, por la promoción del cítrico nacional. “Los cítricos están disponibles en el lineal los 12 meses del año, por lo que no hay ningún elemento novedoso cuando comienza la campaña española”, lamenta Enrique Bellés, presidente de Intercitrus, quien insiste en que “tenemos que promocionarnos mejor y generar esa necesidad en el consumidor”.
La Unión Europea (UE), por su parte, también debe aportar su granito de arena, haciendo cumplir las cláusulas espejo, que exigen a las importaciones de terceros países los mismos requisitos que a las producciones comunitarias; y ampliando el cold treatment al resto de cítricos, más allá de las naranjas, entre otras cuestiones, para garantizar una competencia leal.
• 5,9 mill. Tn, aforo 2022/23
• 3,4 mill. Tn, previsión exportación
Fuente: World Citrus Organization.
El aumento de costes agravado por las mermas sin precedentes en cultivos como el caqui o los cítricos obligan al sector a replantearse su futuro que, para Canso, pasa por la diversificación de la oferta, tecnificación del campo, puesta en valor del producto y la reorganización del propio sector.
ISABEL FERNÁNDEZ
El pasado 2022 no fue un año fácil para la agricultura de la Comunidad Valenciana. La adversa climatología de la primavera causó estragos en cultivos como el caqui, cuya producción cayó más de la mitad; y no fue mucho mejor para los cítricos, que iniciaron un nuevo ejercicio en octubre. “Tenemos una merma importante en las variedades tempranas”, comenta Pedro Sánchez, director general de Canso, quien lamenta que, a principios de enero, “llevábamos recolectados la mitad de kilos que el año pasado”. La buena noticia es que prevé una segunda parte de la campaña de cítricos “fuerte”, en la que las mandarinas Tango y Orri serán dos de sus bazas ganadoras.
Esta merma productiva, unida al aumento de costes, solo viene a agravar aún más la situación del sector; de ahí que Sánchez insista en la importancia de trabajar en 4 líneas estratégicas para seguir liderando la producción en Europa:
oferta y su disponibilidad en los lineales, ofreciendo más productos durante más tiempo. En Canso, si bien el caqui (55%) y los cítricos (35%) continúan siendo sus principales referencias, “estamos divercultivado en torno a 120 hectáreas de sandía y unas 70 de brócoli”.
2. Tecnología. “No podemos vivir de espal-
que, en las centrales de manipulado, se ha avanzado mucho en los últimos años. Aunque es consciente de que resulta más fácil mecanizar en zonas como Andalucía, donde las explotaciones agrícolas son más extensas, confía en que, “en Valencia, también se pueda”.
3. Valor. Para el director general de Canso, las producciones españolas deben poner en valor aquello que las diferencia del resto: la proximidad y la calidad. “Vendemos salud y sostenibilidad”, insiste.
4. Reorganización del sector. Mientras la gran distribución se sigue concentrando, la producción continúa muy atomizada, quedando en gran desventaja frente a los la integración o modelos de cooperación como el que Canso mantiene con Anecoop. “Es la única manera de sobrevivir”,
CONSUMO
Con respecto al consumo, no duda de la preferencia del consumidor por las frutas y hortalizas, si bien reconoce que el aumento de referencias en el lineal y la desestacionalización de muchas de ellas complica la decisión de compra. “Puede que caiga el consumo de frutas y hortalizas puntuales, pero no globalmente, ya que el consumidor quiere comer cada vez más saludablemente”, concluye.
The increase in costs aggravated by the losses in crops such as persimmon or citrus fruits force the sector to rethink its future which, according to Canso, involves the -

value to the product and the reorganization of sector itself.
AN ANNUSHORRIBILIS
The adverse weather in 2022 wreaked havoc on crops such as persimmon, whose production fell by more than half, and citrus.
early varieties”, says Pedro Sánchez, general manager of Canso, who expects a “strong” second part of the campaign.
THE STRATEGIES
Sánchez insists on the importance of working on 4 strategic lines:
1.
2. Technology.
3. Value.
4. Reorganization of the sector.

Los atributos de los envases de madera de FEDEMCO son de sobra conocidos por sus clientes. El reto está en ponerlos en valor y extender aún más su presencia en el mercado, mostrar la enorme evolución que ha tenido el sector y cómo estos envases de madera pueden ayudar a la sostenibilidad y a cubrir las necesidades de toda la cadena alimentaria.


Por ejemplo, la madera tiene la propiedad higroscopia. Es decir, tiene la capacidad de absorber la humedad del medio circundante. Por ello, a la hora de exportaciones a destinos más lejanos, los envases de madera son los aliados perfectos, porque contribuyen a controlar la humedad y, por tanto, a prolongar la vida útil de los productos frescos.
Por otro lado, los sistemas de producción de envases de madera han evolucionado mucho en los últimos años, y hoy somos capaces de atender las demandas de los clientes de una forma inmediata, sin roturas de stock por falta de materias primas. Igualmente, estos modernos sistemas de producción nos permiten ajustar medidas para
Además, la madera que utilizan los asociados de FEDEMCO procede de explotaciones privadas y de bosques públicos gestionados de una manera sostenible. Con ellos se contribuye no solo a frenar las emisiones de CO2, sino que tenemos una huella de carbono negativa.
Un envase de madera utilizado con producto fresco no puede volver a
Por ejemplo, sus residuos se pueden utilizar para la fabricación de tableros aglomerados de madera y otros tipos de tableros técnicos.
En este sentido, desde FEDEMCO trabajan con otras industrias que utilizan su madera reciclada para darle visibilidad a esa segunda vida. Por lo tanto, sus envases sí son reciclables y reutilizables, convertidos en otros productos.

La empresa Suterra lanza para esta campaña CheckMate® CRS, un producto de confusión sexual para combatir esta importante plaga.
Carolina Maset, International Brand Manager de Suterra, nos explica que se trata de técnicas fáciles de implementar, “la única particularidad es que, al menos en cítricos, son relativamente recientes y nos gusta acompañar al agricultor para una óptima implementación”, explica Maset. Sus productos están al alcance de todos y más ahora, cuando la reducción de materias activas a nivel europeo es una realidad, lo que antes era una elección del agricultor hoy es necesidad y “el biocontrol es una alternativa en la que Suterra es pionera”, concluye.
CONFUSIÓN SEXUAL PARA CÍTRICOS
de otoño, las plagas han tenido unos comportamientos atípicos”.
Para Suterra, la colocación del producto en el momento adecuado es esencial, ya que muchas veces se espera a que la fruta madure y tenga color y entonces es tarde porque la plaga puede estar latente desde la campaña anterior, como sucede en los cítricos.
Los productos de biocontrol de Suterra son clave para la transición hacia una agricultura española más sostenible. La técnica de confusión sexual consiste en utilizar elementos que ya están presentes en la naturaleza, por lo que protegen y mejoran la biodiversidad, la calidad del suelo, la salud de los cultivos y todo esto contribuye a una producción sostenible de alimentos.
Es una técnica sostenible que consiste en emitir en el cultivo feromonas de la hembra de la plaga que se quiere controlar, los machos pierden su rastro sexual, dejan de aparearse y se reduce la población. Así se evita el daño en cosecha consiguiendo fruta limpia y sana.
El biocontrol mediante feromonas es actualmente esencial en una gestión integrada de plagas y es un sistema respetuoso con la fauna útil, ya que solo incide en la plaga diana. No genera resistencias y no deja residuos.
La técnica de confusión sexual ayuda al agricultor a conseguir los objetivos de sostenibilidad del Pacto Verde de la UE cómo de la Agenda 2030 de la ONU.
Esta es la primera campaña en la que Suterra tiene disponible un producto de confusión sexual para cítricos, concretamente para una plaga tan importante como es el Piojo Rojo de California, no solo en España, sino en toda la cuenca Mediterránea. “El producto se llama CheckMate® CRS y ya se utiliza en Estados Unidos desde hace unos años con gran éxito”, detalla Maset, quien refuerza que sus resultados avalan la reducción del uso de insecticidas y consecuentemente la disminución de costes, prioridad en el contexto actual para agricultores que ya lo han aplicado.
UN ESFUERZO PARA AGILIZAR LOS REGISTROS DE NUEVOS PRODUCTOS DE BIOCONTROL
Pero no solo las plagas propias del cultivo están afectando a las frutas y hortalizas, también el cambio climático. Sin ir más lejos, en el caso de esta campaña, la mosca de la fruta del Mediterráneo, una plaga muy extendida también en España, se ha prolongado más allá de octubre y noviembre, “nuestrosdas temperaturas de este verano y principios

Maset destaca para este año el 25 aniversario de la tecnología de confusión sexual en sistema aerosol Puffer®, un sistema pionero y que, generación tras generación, tanto para frutal, viña o frutos secos, ha ido evolucionando y sigue siendo una solución innovadora, eficaz y sostenible para los agricultores.
La estrategia de la UE ‘Farm to fork’ (‘De la granja a la mesa’), que se aprobó dentro del Pacto Verde de la UE hace un par de años, tiene como objetivo caminar hacia una agricultura más sostenible y obviamente el biocontrol es una herramienta necesaria para poder llegar a ese objetivo. Estas nuevas estrategias tienen como meta reducir la dependencia de los insecticidas químicos, algo que solo será alcanzable si, al mismo tiempo, se autorizan soluciones de control biológico.
Recalca Maset que Europa debería acelerar la aprobación de nuevos productos. “En Europa nos cuesta muchísimo, primero se ha de aprobar la materia activa y posteriormente el producto, estamos haciendo un esfuerzo para poder agilizar los trámites, pero necesitamos ir de la mano con la Administración para que estos procesos se agilicen lo máximo posible”.
Desde Suterra recomiendan al sector que en este año 2023 apueste por el biocontrol, una industria que está en continúa investigación para la mejora de estos productos, y que, aunque a priori puedan parecer
inversión, tanto a nivel económico como de sostenibilidad.


“Estos datos están basados en la información que nos facilitan las empresas, aquellas que no aparecen es porque no responden o no han querido participar”
El ejercicio 21-22 se cerró con un balance positivo, donde las expectativas se cumplieron, el consumidor demandó más berries y el sector respondió. En este nuevo curso, la inflación ha reducido el poder adquisitivo de las familias y se teme que una disminución de la demanda lastre la campaña.
El año pasado analizábamos en estas mismas páginas que los berries afrontaban con ciertas garantías un 2022 inflacionista, por la alta demanda que experimentaron en los mercados europeos. En este curso, por el contrario, los indicadores macroeconómicos apuntan a una contención del gasto en favor de un mayor ahorro, que ya ha notado el sector hortofrutícola en los meses de noviembre y diciembre del pasa-
señala que los precios de la fresa hasta enero fueron un 30% menores que en 2021-22. El bolsillo del consumidor se ha quedado ajustado para la partida de frutas y hortalizas, conocido el último dato, que lo reduce un 13% en 2022. “Parecía que 2023 traería la senda de normalidad del 22, pero afrontamos un nuevo escenario de incertidumbre con nuevos obstáculos como el impuesto al plástico”, explica Báñez, para quien este solo reduce la rentabilidad, ya que les resulta muy difícil repercutir ese incremento a la distribución.
El sector afronta un nuevo ejercicio con retos estructurales a corto y me-
Desinfección. Es quizá la principal preocupación de cara a las plantaciones de vivero y posteriores replantaciones en Huelva en
1,3-Dicloropropeno y la Cloropicrina no va a revertirse, ni autorizarse excepcionalmente. Por lo tanto, el sector afronta un salto al vacío sin
gerente de Agrofresas, “es obligado un cambio de mentalidad, la desinfección con antibióticos no es posible y la alternativa es la microbiología”. En este sentido, ya hay avances y resultados con el uso de probióticos que bloquean los patógenos, enriquecen el suelo y, como nos comenta Pablo García, director comercial de Sovitae, ya hay empresas onubenses testeando.
Agua. La situación sigue siendo crítica para el sector, y aunque las lluvias de diciembre aliviaron a los cultivos, el campo está necesitado. Huelva sigue reclamando infraestructuras como la presa de Alcolea para que pueda recoger el agua de riego o el desdoble del Túnel de San Silvestre. Los niveles de agua en los pantanos de la provincia son los habituales en estas fechas, pero los agricultores onubenses siguen manteniendo restricciones de riego por seguridad y precaución, lo que puede mermar las condiciones de la plantación, desarrollo de la fresa y la producción.
Mano de obra. Aunque parece que Honduras va a ser un nuevo origen -
terializado en 2022. Llegó la circunstancia de que todavía había fresa y el arándano estaba a pleno rendimiento, pero muchos agricultores
abandonaron parcelas de fresas. No es algo nuevo, pero está siendo un factor determinante en la viabilidad y el éxito de las campañas de frutos rojos.

Costes. Un nuevo actor se incorpora al contexto de los berries, el imla fabricación de este material, pero que, por las características de los berries y para poder ofrecer un precio competitivo en los mercados, sigue utilizándose, aunque en su mayor parte, reciclado. El precio del nuevo impuesto de 2023 se aplica por la cantidad de plástico no reutilizable que contienen los productos para los berries, que es de 45 céntimos por kilogramo. También es para los envases compuestos por varios materiales; si uno de ellos es el plástico, se paga por la cantidad que contenga. El tributo no se aplica si el que contienen es reciclado. En cualquier caso, como apuntan fuentes consultadas, parece que la subida de costes va retrayéndose y dando un respiro a un sector presionado por muchos factores ajenos a su actividad.
CAMPAÑA 2021-2022
Rafael Domínguez, gerente de Freshuelva. La tormenta perfecta que se preveía, provocada por el incremento en los costes de la energía y fertilizantes, paros en el transporte y la invasión de Ucrania, afectó a la rentabilidad del agricultor, sin embargo, la menor oferta de fresa y el aumento de la demanda consiguieron equilibrar el mercado con mejores precios.
Los efectos climáticos de 2022 (bajas temperaturas en enero y precipitaciones por encima de la media en marzo y abril) afectaron principalmente a la fresa, que sufrió un descenso de un 10,2% respecto a la campaña 20-21. La producción de frambuesas fue de 49.990 Tn, registrándose un aumento del 7,5%. Y el mayor incremento de producción lo registró el arándano, que, con un total de 59.100 toneladas, vio una subida del 20,2% respecto al ejercicio anterior.
medio de venta de fresa para envases estándar ha subido un 13,9% y para envases especiales un 24,5%, datos que se vieron minimizados por la subida de los costes de producción.



Por el contrario, en la campaña de arándano, el precio no fue tan positivo y cayó un 18,5%, respecto a 2021, y un 12% en relación a
la media de los últimos 6 años. Diferentes voces del sector apuntan a que se debe a una entrada masiva de origen chileno, que supuso una sobreoferta en los mercados europeos.
Andalucía ha vuelto a batir su récord de exportaciones de frutos rojos en los primeros nueve meses de 2022, con unas ventas que superaron los 1.300 millones de euros, la cifra más alta jamás alcanzada en toda la serie histórica para este periodo, gracias a un incremento del 3,2% respecto al mismo periodo del año anterior. Alemania, Reino Unido y Francia fueron sus principales destinos.

Desde la cooperativa moguereña Agromolinillo, perteneciente a la cooperativa de segundo grado Fruta de Andalucía y cuya producción de arándano ha aumentado considerablemente en los últimos años, manifiestan que este cultivo se encuentra en una situación difícil ante la creciente competencia de terceros países.
Claramente. Esta complicada situación se debe a la competencia desleal que tenemos con estos países en cuanto a productos autorizados para cultivar, diferencias salariales, límites de recursos hídricos y otras muchas exigencias impuestas por la UE que otros países no tienen que cumplir y nos dejan en clara desventaja competitiva. Además, la guerra en Ucrania ha impedido que estos terceros países productores exporten a Rusia y su mercancía se derive a Europa, inundando el mercado de oferta y, por consiguiente, bajando los precios del arándano en el mercado. Siempre somos optimistas, pero estamos llegando a una situación sostenida de pérdidas que nos hace pensar que la agricultura pueda desaparecer en nuestro país, como lo han hecho otros sectores.
El crecimiento de la producción mundial de arándano ha creado una sobreoferta en el mercado europeo. ¿En qué situación se encuentra este cultivo en la provincia de Huelva?
Huelva ha crecido en los últimos diez años un 80%, alcanzando las 3.709 hectáreas en la campaña 21/22, convirtiéndose en el fruto rojo con mayor incremento en los últimos años en la provincia. Sin embargo, su precio en origen sigue una línea irregular, con avances y retrocesos, y con un precio medio en torno a los 4 €/kg, según el Observatorio de Precios y Mercados de la
Hoy día el arándano bio supone menos de un 1% de la producción total del mercado global.

DIFERENCIAR NUESTRA OFERTA EN EL MERCADO
¿Qué balance hacen de la pasada campaña?
El arándano en Huelva se resiente debido a la competencia creciente de terceros países, principalmente. En Marruecos, Sudáfrica, Perú, etc., su futuro puede ser muy prometedor, pero no aquí debido a los altos costes.
Cada vez es más difícil diferenciar nuestra oferta en el mercado, y de hecho, las dos últimas campañas de arándano en Huelva no han sido buenas.
¿Existe una desventaja competitiva con respecto a países terceros?
“THE


From the Agromolinillo cooperative from Moguer, whose blueberry production has increased considerably in recent years, they state that this crop is in a difficult situation due to the growing competition from third countries.




The blueberry area in production

years in Huelva, reaching 3,709 hectares. However, its original price follows an irregular line, with ups and downs.
Agromolinillo (Fruta de Andalucía), explains that the blueberry in Huelva is suffering due to the growing competition from third countries:
“In Morocco, South Africa, Peru and Mexico, its future can be very promising, but not here due to the high costs that we have, aggravated by the war in Ukraine”.


“Estos datos están basados en la información que nos facilitan las empresas, aquellas que no aparecen es porque no responden o no han querido participar”
La elevada demanda ha disparado la superficie mundial de aguacate en los últimos años, pero las duras condiciones climáticas de 2022 han frenado su capacidad productiva y disminuido el calibre medio para esta campaña, amenazando seriamente los resultados.
ALICIA LOZANOcorto plazo por parte de la Administración den sus frutos y en poco tiempo puedan contar con agua regenerada para riego: “Estaremos como Almería, el agua será cara, pero habrá”.
UN REDUCTO EN EUROPA
La producción española de aguacate cubre una cuota de mercado en Europa del 15% y,
(un 14%), los países terceros lo hacen a mayor ritmo, convirtiéndonos en un pequeño reducto. Ya no hablamos solo de los tradicionales líderes del sector, como México, Perú, Sudáfrica y Chile, que han multiplicado su producción; otros como Marruecos, Colombia o Kenia también se suman a esta tendencia con importantes cosechas. De hecho, en esta campaña, se han estado cerrando programas con otros países para suplir la falta de la producción española. De 2018 a 2021, la
En 2021, el consumo de aguacates en Europa aumentó en aproximadamente 55.000 toneladas (+7%).
EL MANGO, BUENA CALIDAD Y BAJO PRECIO
ACUSADO DESCENSO
La merma en calidad y producción es la tónica de este año en muchos cultivos y no iba a ser diferente en el aguacate. Las altas temperaturas registradas en verano, unidas a la sequía y al carácter vecero del árbol, han provocado una reducción para esta campaña 22/23 de aguacate de al menos un 25% a nivel nacional (entre 50 y 60.000 Tn previstas), según detalla Domingo Medina, presidente de la Asociación Española de Tropicales. Hay que tener en cuenta que el año pasado la campaña tuvo una producción récord. Esta disminución se ha dado también en terceros países productores como Marruecos, Israel y México. “Creo que va a ser un periodo complicado de suministro”,pical Millenium, al respecto.
EL AGUA, SU TALÓN DE AQUILES
Sin duda, la sequía es actualmente el condicionante número uno para el sector tropical español. Solo en la mayor zona productora de Europa, la Axarquía malagueña, la falta de riego ha provocado una merma de producción de hasta un 50% respecto al año anterior, y una reducción global de los calibres que repercutirá en la cotización del producto en el mercado. Pese a que entran plantaciones en producción en Cádiz y Huelva que están creciendo a buen ritmo, su volumen no logrará subsanar esta pérdida. Prudencio López, gerente de Natural Tropic, confía en que las obras planteadas a
LA FALTA DE RIEGO HA
PROVOCADO UNA MERMA DE PRODUCCIÓN DE HASTA EL 50%

importación de aguacate a Europa procedente de terceros países aumentó un 22%, según el European Statistics Handbook de Fruit Logistica. El temor reside en que, “si estas empresas comercializan de forma directa al continente, nuestro papel importador se perderá, lo que supone una gran parte de nuestro negocio”, declara Prudencio López.
Las altas temperaturas del verano adelantaron la cosecha, dando como resultado una calidad de fruto excelente, aunque de calibre inferior, debido a la falta de agua, un hecho que no le permitió alcanzar precios altos en el mercado. “El mango de Málaga vale más de lo que se está pagando por él”, declara Enrique Colilles, CEO de Trops. Debido a esta maduración temprana, la temporada comenzó y terminó antes de lo previsto, siendo una campaña más corta. El volumen, por su parte, fue similar al año anterior.
OTROS TROPICALES
Chirimoya. Se mantiene estable en supervisto mermada en volumen y calibre por la falta de agua esta campaña.
Pitaya. Tiene la gran ventaja de que, aunque necesidades hídricas son menores, dando una oportunidad de oro a los productores.
Papaya. Adquiere cada vez mayor protagonismo en el lineal y en la producción española, como la pitaya, a pesar de ser un cultivo costoso.
20202021Var.
España15.84918.06114%99.125116.76918% Fuente: MAPA. Datos 2021, provisionales.


“Estos datos están basados en la información que nos facilitan las empresas, aquellas que no aparecen es porque no responden o no han querido participar”
La producción total de hortícolas se redujo en la última campaña con respecto a la anterior. Almería y Murcia, las zonas que concentran más del 90% de la producción nacional, han visto caer sus toneladas producidas un 8%; sin embargo, el pepino contradice este dato con una tendencia muy positiva en los últimos años.

En este análisis queremos hacer especial hincapié en el pepino. La mejora de sus precios en la pasada campaña, un 39% superiores (pasando de 323.539.000 € a 450.907.000 € en la 21-22), le hacen liderar el crecimiento en valor de todas las hortalizas y lo señalan como un valor de futuro.
Se trata del único producto que mejora en haberse situado en la segunda posición tras el pimiento en aumento de producción y suun 12,4% y un 10,7%, respectivamente. Cabe destacar, además, que su valor no se incrementó, como en el resto de hortícolas, fruto de los menores volúmenes a consecuencia de la meteorología.
Si bien es cierto que la menor producción ha favorecido la comercialización de las hortalizas en los mercados, la campaña 21-22 se caracterizó por un contexto económico y geopolítico marcado por la invasión rusa de Ucrania, la subida de costes de los insumos, la sequía como consecuencia del inexorable cambio climático y la dependencia de la evolución de los mercados energéticos. Esto supuso, solo para los invernaderos almerienses, un aumento del 12% del total de gastos por hectárea.
POR CULTIVOS
Calabacín.
hortaliza se ha mantenido estable, aunque con un ligero retroceso respecto a 2020/21, 8.013 ha (-0,6%). Respecto a la producción, también se redujo levemente hasta alcanzar las 499.901 Tn (-4%), condicionada por la meteorología.
Berenjena.
únicas hortalizas que han mejorado sus volúmenes respecto a la campaña anterior sumando 2.387 ha (+4,8%) y superando las 220.897 Tn (+3,9%).
Brócoli y coliflor. El primero creció un 30,5%, pasando de 192.514 a 251.268 Tn; y mayor, si cabe, es el crecimiento de la coliflor, de un 41%, pasando de 30.105 Tn a 42.455. Ello debido, principalmente, a la aumentó en más de 3.000 hectáreas con respecto a la campaña anterior.
Lechuga: Murcia y Almería, las grandes zonas productoras, sufrieron una leve caída de Agricultura, a pesar de la tendencia positiva de la región murciana en años anteriores.
Así, en un contexto donde, por un lado, el tomate parece haber frenado la caída detana que, por ahora, está dejando Holanda debido a la subida de costes energéticos. Y, por otro, el pimiento se consolida como líder por sus menores costes de producción frente al tomate. El pepino se erige como alternativa, más concretamente el tipo holandés, que se produce en Almería, con un mayor rendimiento y mejores precios liquidados en los mercados. Complementariamente, sigue vez una mayor demanda en Europa.
Desde las casas de semillas apuntan a que las nuevas variedades con mayores paquetes de resistencias y mejor postcosecha están ayudando a que el plástico no sea un obstáculo en la comercialización en Francia o Alemania, sus principales mercados.
Para mantener este crecimiento y los precios alcanzados, el sector debe posicionarse en la calidad y la postcosecha como úni-
co camino para aumentar su rentabilidad. Aunque se prevén reducciones de costes tras dispararse en 2020 y 2021, estos serán progresivos y no sabremos cuándo volverán a valores normales.
Sostenibilidad
La sostenibilidad ha estado marcada en las últimas campañas por las directrices de Europa, sin embargo, cada vez es más valorada por los consumidores. El sector lleva años trabajando en este sentido, pero no debe cesar ahora. La sostenibilidad del suelo, la
rán los puntos clave.
Consumo
Los europeos han disminuido sus impor-

taciones cerca de un 10,5% en 2022, la inflación está haciendo mella en el bolsillo de los consumidores. En consecuencia, la reducción productiva de Holanda, que en un principio se tituló como oportunidad para las producciones españolas, no deben ser un aliciente, sino un indicador que evite posibles excesos de oferta.



Digitalización
Es el otro gran argumento para aumentar la rentabilidad, junto a la reducción de costes. Esta estrategia será la que permita mejorar los recursos disponibles. Se incorporarán también con mucha fuerza la Inteligencia
ductividad de las empresas.

UN CAMINO SOSTENIBLE
JAVIER CARMONA, DIRECTOR DE MARKETING DE LA UNIÓN.Si algo caracteriza a La Unión como empresa es la capacidad de adaptarse a los cambios para encontrar el modelo de negocio más
monetario y las necesidades sociales de pro-
LA
remos trabajando en el compromiso genera-

UN REFERENTE EN EL EMPRENDIMIENTO SOSTENIBLE Y RESPONSABLE
desarrollará distintas líneas de negocio traba-

S.A.T. 9855
S.A.T. Nº 9662
S.A.T. 9989
“Estos datos están basados en la información que nos facilitan las empresas, aquellas que no aparecen es porque no responden o no han querido participar”

La elevada inflación está causando estragos en el sector, que ve cómo se reduce la brecha de las frutas y hortalizas bio frente a las convencionales y, aun así, el consumo frena su ritmo de crecimiento.

ISABEL FERNÁNDEZ
CONTEXTO GLOBAL-
• Hortalizas: 519.000 Tn
• Frutas: 129.500 Tn
• Cítricos: 404.000 Tn
driver dediscount -
al discount -
3 AMENAZAS
• Inflación.
• Guerra de precios.
• Caída del consumo.
cesta de la compra ecológica de los espa-
LA INFLACIÓN VA A PROVOCAR
LA DESAPARICIÓN DE MUCHOS
PRODUCTORES ECOLÓGICOS
UN SECTOR ESTANCADO
¿HAY FUTURO?

“Estos datos están basados en la información que nos facilitan las empresas, aquellas que no aparecen es porque no responden o no han querido participar”

Si analizamos el pasado ejercicio agrícola, se -
El pimiento consolida su liderazgo en hortícolas, tanto en superficie como producción, frente a un tomate que redujo ambos valores en la campaña pasada. En esta, las previsiones son de estabilización (+2%), influidas por el crecimiento de la superficie de tomate de un 15%, sin embargo, la persistencia de los problemas de calidad por plagas podría afectar en próximas campañas.

FERNANDO PEREA
(+) Especialidades. La demanda de es-
+13,6%
Variación entre la producción de pimiento en la campaña 21/22 y la media de los cinco últimos años.

al commodity
CAMPAÑA 21/22

“Estos datos están basados en la información que nos facilitan las empresas, aquellas que no aparecen es porque no responden o no han querido participar”

Esta historia ha sucedido en varias ocasiones en el sector hortofrutícola, un determinado producto de calidad, reconocido en los mercados, con un buen manejo de cultivo y todas las condiciones para liderar o recuperar determinados mercados, de repente desaparece esa oportunidad.
EXPECTATIVAS
ESPAÑA NO PUEDE COMPETIR HOY CON HOLANDA-
EXPORTACIONES DE TOMATE A LA UE. CAMPAÑA 2021/2022 (AGOSTO-JULIO)
VolumenValorVariación 20-21

LA PRIMERA PARTE DE 2022 SE ALCANZARON PRECIOS MUY FAVORABLES, SUPERIORES AL 20-30% DEPENDIENDO DE LA VARIEDAD

AMENAZAS 2023 •
OPORTUNIDADES 2023
Este país continúa siendo el principal destino de las exportaciones españolas de tomate, un mercado que se decanta por los tipos pequeños y que, pese a la crisis económica, no cierra por completo la puerta a los tomates premium, que generan el 25% del valor del mercado.
ISABEL FERNÁNDEZ
EL TOMATE EN EUROPAprescindibles en la cesta de la compra de -
siendo el primer destino de las exportacio-
LOS TOMATES PEQUEÑOS GENERAN EL 64% DEL VALOR DE ESTA CATEGORÍA EN ALEMANIA
EL CONSUMO EN ALEMANIA precio como el principal driver discounters


“Estos datos están basados en la información que nos facilitan las empresas, aquellas que no aparecen es porque no responden o no han querido participar”
UN AMARGO RÉCORD calibres grandes -escasos este ejercicio- ydonde a los bajos calibres y rendimientos se
Ajo y cebolla viven, una campaña más, realidades muy distintas: el primero, con dificultades para su comercialización y, la segunda, con una venta tan fluida como elevados han sido sus precios. El único denominador común ha sido el descenso de los rendimientos de ambos cultivos como consecuencia de la sequía y las olas de calor.
ISABEL FERNÁNDEZ
LA PRÓXIMA CAMPAÑA DE CEBOLLA DEPENDERÁ DE LA DISPONIBILIDAD DE AGUA


“Estos datos están basados en la información que nos facilitan las empresas, aquellas que no aparecen es porque no responden o no han querido participar”

El sector de la patata nacional está convencido de que existe una oportunidad de crecimiento. La gran calidad de su producto fresco, su cada vez mayor profesionalización, el déficit de la oferta nacional y la fuerte apuesta por el producto local le empujan a creer en ello.

ALICIA LOZANO
Crece el producto de conveniencia -
PRECIO EN ORIGEN
La conservación no es una opción
EN CONTRA Francia no decae
A FAVOR
Alto nivel de profesionalización

“Estos datos están basados en la información que nos facilitan las empresas, aquellas que no aparecen es porque no responden o no han querido participar”

Tras la desaceleración que ha supuesto la pandemia en la categoría de IV y V Gama en innovación y consumo, se recupera con más fuerza que nunca ante el atributo de ser una opción saludable, cómoda y sostenible que no tiene por qué verse frenada por la inflación y la complicada situación económica.

ALICIA LOZANO
EL CONSUMO SE RECUPERA
no ha cesado de crecer anualmente Sin embargo, con la pandemia, 2021 registró un estancamiento de las ventas en volumen de frutas y hortalizas de IV Gama, con un descenso del 46,9 % con respecto a 2020, según el último Informe de Alimentación en España. Sin embargo, en 2022, el ritmo de crecimiento parece haberse recuperado. Según la consultora internacional NielsenIQ, en la primera mitad del año, el consumo de IV Gama en general ha crecido un 8,96% frente a 2021.
Muestra de ello son las cifras de balance que presentan empresas como Vicente Peris, cuyo volumen de producción de enero a septiembre de 2022 ha ascendido a 1,6 millones de kilos de fruta y verdura procesada, lo que supone un incremento de ventas de un 38% con respecto al mismo periodo del año anterior. Lo corroboran igualmente desde Primaflor: “La evolución de ventas ha sido buena desde el punto de vista del consumo”, detalla María Glover, responsable de Marketing. Es también el caso de la V Gama, donde Surinver, por ejemplo, aumentó su facturación un 8% el año pasado en su línea ‘ready to eat’
EL PROBLEMA, LA ESCALADA DE COSTES
Pero estos datos de crecimiento del consumo se ven ensombrecidos por el incremento de los costes derivado de la guerra en Ucrania, que ha afectado tanto a nivel de producción como de materiales, reduciendo los márgenes a los productores y encareciendo
do a nivel legislativo con el nuevo impuesto al plástico no reciclado, que se ha transmitido a la cadena como un coste añadido. De esta forma, el temor está ahora en que esta situación de inflación afecte a los niveles de consumo próximos de la categoría de IV y V Gama, “teniendo en cuenta que de por sí son referencias de mayor precio y el consumidor se va a decantar por opciones más econó-
micas ante el contexto de empobrecimiento actual”, tal y como sostiene Marta Jiménez, responsable de Marketing de Caña Nature.
LO SOSTENIBLE EQUILIBRA LA BALANZA
En esta tesitura, la apuesta del consumidor por la sostenibilidad representa una oportunidad para la línea de IV y V Gama, que, a pesar de su precio más elevado en el lineal, tendrá de su lado a los consumidores comprometidos, que tienen en cuenta que este tipo de soluciones contribuyen a reducir el desperdicio alimentario. Ofrecen una vida más larga del producto, aprovechan frutos que no iban destinados al mercado en fresco y evitan el porcentaje de desecho habitual en el hogar al ser cantidades más ajustadas al consumo, entre otros aspectos. “Ejemplo del fomento de la economía circular de nuestra línea de V Gama es nuestro nuevo postre de calabaza, que aprovecha aquellas no aptas para su consumo en fresco por defecto visual o de calibre”, detalla Loli López, directora de Marketing de Surinver.
BUEN PRONÓSTICO
operadores del sector auguran un buen desarrollo de la categoría. “Esperemos que los costes se vayan conteniendo y que podamos ver una recuperación del consumo dentro de unos meses”, detalla Ana San Romualdo, responsable de Comunicación de Huercasa. Así lo cree Alberto Cáncer, director comercial de Janus Fruit, la línea de V Gama de Anecoop: “El producto tiene un valor añadido más importante que el precio”, quien a su vez explica que la categoría mantendrá los

niveles de crecimiento porque responde a la comodidad y las nuevas formas de consumo, además de la apuesta por una alimentación saludable, poniendo como ejemplo el Brocomole que acaban de lanzar. De la misma forma lo corroboran desde Primaflor: “La tendencia de consumo convenience en ensaladas crecerá de forma constante cada año, ya que responde a la demanda de salud, reducir el desperdicio, unidades familiares pequeñas…”.

habrá consumo más allá del precio.
· Adaptar los envases y embalajes a las nuevas demandas reciclables y compostables







· canal Horeca.

· Sabor y color con opciones saludables, 100% vegetal y sin alérgenos, propios de la categoría.







EARIS - Packing & Sorting presenta este año en Fruit Logistica UPCOBOT, una unidad de paletizado única en el mercado, además de seguir dando a conocer sus equipos de etiquetado non-stop, que eliminan los temidos cuellos de botella en las grandes líneas de producción.





ETIQUETADO NON-STOP tecnología non-stop
EN EARIS CONTAMOS CON LA ENVASADORA IDEAL PARA CADA TIPO DE PRODUCTO Y TAMAÑO DE LÍNEA DE PRODUCCIÓN
UPCOBOT, UNA UNIDA DE PALETIZADO ÚNICA

sostenibilidad medioambiental y social de la
Vuelta a la normalidad total sin restricciones, ¿qué expectativas tienen para esta edición? ¿Qué novedades van a encontrar expositores y visitantes?
lema de este año es “All in One”
¿Qué eventos del programa de conferencias destacaría dentro de cada una de las áreas de conocimiento que presentan? Fresh ideas, Logistic hub, Start up days, Fresh Produce Forum, Tech stage, Future Lab…
Hydrogen
SE PRESENTAN UN GRAN NÚMERO DE SOLUCIONES TECNOLÓGICAS EN ESTA EDICIÓN
La digitalización y la automatización son claves en un entorno donde la subida de costes y la reducción de agua y mano de obra presionan al mercado, ¿qué soluciones pueden encontrar los productores nacionales en Fruit Logistica?
Hay quien comenta que lo que necesita ya lo tiene en Madrid, y otros que Berlín y Madrid son complementarias. ¿Por qué debe el productor español volver a Berlín?

CAJAMAR CAJA RURAL
Chairman: Eduardo Baamonde Noche
Plaza Juan del Águila Molina, 5. 04006 Almería (Spain)
+34 950 21 01 91
cajamar@grupocooperativocajamar.es
Yearly Turnover: 97.835.000.000 €
Main Product: Bank and insurer.
UNICA GROUP S.C.A.

Manager: Enrique de los Ríos
+34 950 18 15 00
Yearly Turnover: 515.000.000 €
Main Product: Pepper, tomato, cucumber, melon, waterme lon, zucchini, eggplant, orange and others.
AGROPONIENTE
+34 950 58 30 02
Yearly Turnover: 339.000.000 €
Main Product: Pepper, tomato, cucumber, zucchini, eggplant, green beans, melon, watermelon and others.
CASI S.C.A.

Chairman: Antonio Bretones
(Almería, Spain) +34 950 62 60 07
Yearly Turnover: 210.000.000 €
Main Product: Tomato.
MURGIVERDE S. COOP. AND. 2º GRADO
+34 950 48 90 90
Yearly Turnover: 210.000.000 €
Main Product: Pepper, cucumber and watermelon.
S.A.T. Nº 9662 AGROIRIS

Ctra. Almerimar, km 1. 04700 El Ejido (Almería, Spain)
+34 950 48 90 75
Yearly Turnover: 180.000.000 €
Main Product: Pepper.
BIO CAMPOJOYMA

Avda. Las Negras, 200. 04110 Campohermoso (Almería, Spain)
+34 950 38 65 90
Yearly Turnover: 90.000.000 €
Main Product: Ecological horticulture.
BIOSABOR S.A.T.

Manager: Francisco S. Belmonte
(Almería, Spain)
+34 950 70 01 00
Yearly Turnover: 71.500.000 €
GRUPO LA UNIÓN

Chairman: Jesús Barranco Martín
Ejido (Almería, Spain)
+34 950 58 08 00
Yearly Turnover: 327.000.000 €
Main Product: Cucumber, zucchini, pepper, eggplant, tomato, beans, watermelon, cantaloup, melon, subtropical
S.A.T. 9855 PRIMAFLOR
Avda. Cecilio Peregrín, 2. 04640 Pulpí (Almería, Spain)
+34 950 46 40 11
Yearly Turnover: 174.168.998 €
Main Product: Lettuce, baby leaves and mini leaves (inclu des all baby leaves and spinach), oriental vegetables, salads
HORTOFRUTÍCOLA COSTA DE ALMERÍA, S.L.
Manager: Juan Enrique Vargas Ctra. de La Mojonera, km 3. 04740 Roquetas de Mar (Almería, Spain)
+34 950 32 62 32
Yearly Turnover: 158.629.967 €
Main Product: Cucumber, pepper, green bean, aubergine, courgette, tomato, melon, watermelon and products ready to eat ‘Qdelicias’.
INDASOL S.A.T.
+34 950 48 82 50
SUCA, S.C.A
+34 950 58 18 69
Yearly Turnover: 282.000.000 €
Main Product: Agrochemicals.
VICASOL, S.C.A.

+34 950 55 32 00
Yearly Turnover: 240.000.000 €
Main Product: Tomato, pepper, cucumber, courgette, auber gine, melon and watermelon.
Yearly Turnover: 123.000.000 €

Main Product: Pepper, cucumber and watermelon.
HORTOFRUTÍCOLA MABE S.A.T.
(Almería, Spain)
+34 950 58 33 00
Yearly Turnover: 114.000.000 €
Main Product: Pepper and cucumber.
S.A.T. 9989 PEREGRIN
+34 950 46 41 11
Yearly Turnover: 108.000.000 €
NATURE CHOICE, S.A.T.
Manager: Antonio Roque Escobar Rubio Ctra. de Almerimar, 24. 04700 El Ejido (Almería, Spain)
+34 950 60 77 77
Yearly Turnover: 105.500.000 €
Main Product: Cucumber, pepper, watermelon, melon, aubergine, zucchini and tomato.
Main Product: Organic tomatoes, cucumber, zucchini, aloe vera, melon, watermelon, gazpacho, salmorejo, organic soups and ecological sauces.
AGRUPAPULPÍ S.A.
04640 Pulpí (Almería, Spain)

+34 950 46 41 54
Yearly Turnover: 70.564.837 €





mini romaine lettuce, bicolor mini romaine, lettuce buds, red lettuce melon and yellow melon.
AGROEJIDO, S.A.
+34 950 48 91 05
Yearly Turnover: 70.320.000 €
Main Product: Pepper, eggplant, zucchini, cucumber, watermelon and pea.
RIJK ZWAAN IBÉRICA S.A.
Ricardo Ortiz Portero Paraje El Mamí. Ctra. de Viator. www.rijkzwaan.com
Yearly Turnover: 64.187.926 €
Main Product: Horticultural seeds production.
COPROHNÍJAR S.C.A.
Chairman: Francisco de Ves Gil
(Almería, Spain)
+34 950 36 60 15
Yearly Turnover: 60.000.000 €
Main Product: Tomato, watermelon, pepper, cucumber, zucchini and eggplant.
CAPARRÓS NATURE, S.L
(Almería, Spain)
+34 950 60 02 13 www.caparrosnature.com comercial@caparrosnature.com







Yearly Turnover: 51.810.000 €
Main Product: Tomato, pepper, courgette, aubergine and watermelon.
S.A.T. ACRENA
Manager: Bernardo Castillo
Rambla de Bernal, 6. 04710 El Ejido (Almería, Spain)
+34 950 58 11 00
Yearly Turnover: 50.473.360 €
Main Product: Pepper, cucumber, tomato, aubergine, melon and watermelon.
FRUTAS ESCOBI, S.L.
Manager: Gabriel Escobar Rubio
Ctra. La Mojonera, 153. 04716 Las Norias
El Ejido (Almería, Spain) +34 950 58 71 01
Yearly Turnover: 50.305.153 €
(Almería), eggplant, zucchini, melon (Yellow, Galia, Cantaloupe).
S.A.T. LAS HORTICHUELAS

(Almería, Spain)
+34 950 34 90 16
Yearly Turnover: 47.000.000 €
Main Product: Tomato.
EJIDOMAR S.COOP. AND.
Ctra. de Almerimar, km 1, Apdo. de correos 21. 04700 El Ejido (Almería, Spain)
+34 950 48 35 11
Yearly Turnover: 45.000.000 €
Main Product: Pepper and watermelon.
HORTAMAR, S.C.A.
Ctra. de Alicún, 148. 04740 Roquetas de Mar (Almería, Spain)
Yearly Turnover: 43.000.000 €
Main Product: Cucumber, pepper, pear tomato, hot pepper, papaya, pitaya, melon, watermelon, zucchini, eggplant and sweet corn.
AGRÍCOLA NAVARRO DE HARO S.L.
Manager: José Alonso Navarro Flores
Ctra. de Palomares a Cuevas del Almanzora, km 2. 04617 Palomares (Almería, Spain)
+34 950 61 80 96 www.agricolanavarrodeharo.es juaninavarro@agricolanavarrodeharo.es
Yearly Turnover: 40.000.000 €
Main Product: Watermelon.
HORTALAN MED, S.L.
Manager: Juan Francisco Rueda
Camino Puesto Rubio, km 0,3. 04710 Santa María del Águila (Almería, Spain) +34 950 58 02 29
Yearly Turnover: 40.000.000 €
Main Product: Auxiliary.
FERVA S.A.T.
Chairman: Francisco Manrique Alonso
+34 950 60 33 07
Yearly Turnover: 37.479.643 €
Main Product: Tomato.
COOP. SAN ISIDRO LABRADOR - COPISI
Manager: José A. Brao
+34 950 58 18 53
Yearly Turnover: 35.000.000 €
Main Product: Pepper and cucumber.
HNOS. DAZA PALMERO S.L.
+34 950 48 43 11
Yearly Turnover: 33.000.000 €
Main Product: Pepper, aubergine, cucumber, zucchini and melon.
MERCOPHAL S.L.

Manager: Juan José Vargas Rodríguez
La Gangosa. 04738 Vícar (Almería, Spain) +34 950 34 61 15
Yearly Turnover: 32.495.392 €

Main Product: Tomato, capsicum and zucchini.
Sales Manager: Josephine Cuadras



Camino Cuatro Higueras. 04610 Cuevas del Almanzora (Almería, Spain)
+34 950 52 90 43
Yearly Turnover: 30.000.000 € artichoke.
KOPPERT SPAIN, S.L.
Manager: Boaz Oosthoek
cela P14, nave 3. 04745 La Mojonera (Almería, Spain)
+34 950 55 44 64
Yearly Turnover: 30.000.000 €
resilience and production. Biological and microbiological control agents and natural pollination.

CABASC S.C.A.
Manager: Jorge Silva
+34 950 40 61 00
Yearly Turnover: 25.556.403 €
Main Product: Aubergine, pepper and beans.
BERJA FRUTAS S.A.
Manager: Klaus Sander (Almería, Spain)
+34 950 48 80 80
Yearly Turnover: 25.000.000 €
Main Product: Pepper, cucumber, aubergine, tomato.
S.A.T. COSTA DE NÍJAR
+34 950 61 27 00
Yearly Turnover: 25.000.000 €
Main Product: Tomato and watermelon.
VIAGRO
Manager: Francisco del Águila
+34 950 29 09 00
Yearly Turnover: 24.000.000 €
Main Product: Nutrition and plant health.
CAMPOSOL S.C.A.
Manager: Ángel Lirola Pérez
Paraje Laimund nº 13. 04700 El Ejido (Almería, Spain)
+34 950 57 31 31
Yearly Turnover: 22.000.000 €
Main Product: Pepper.
NÍJAR GREEN BIO S.L.
04100 Almería (Spain)
+34 950 04 30 59
Yearly Turnover: 22.000.000 €
Main Product: Bio vegetables, tomato, cucumber and zucchini.
GRUPO CRISTALPLANT S.L.

General Manager: José Blanco Céspedes
(Almería, Spain)
+34 950 56 50 32
Yearly Turnover: 21.000.000 € and nursery.
EXPORTACIONES AGRÍCOLAS ALDENOR S.L.
(Almería, Spain)
+34 950 58 73 12
Yearly Turnover: 20.577.548 €
Main Product: Fruits and vegetables.
MAYES EXPORTACIÓN S.L.
+34 950 58 73 98
Yearly Turnover: 20.203.333 €
Main Product: Marrow.
KIMITEC
CEO: Félix García Moreno
04738 Vícar (Almería, Spain)
+34 950 34 69 09
Yearly Turnover: 20.175.930 €
Main Product: Biostimulants, prebiotics, probiotics and biopesticides.


CRIADO Y LÓPEZ S.L.
+34 950 48 79 73
Yearly Turnover: 20.000.000 €
Main Product: Agrotextiles and nonwoven specialists.






NATURPLÁS
Manager: Francisco Cirera
+34 950 48 29 40
Yearly Turnover: 20.000.000 €
AGRO RED & GREEN
Almería, Spain) +34 637 43 27 36
Yearly Turnover: 19.000.000 €
Main Product: Pepper, bean, tomato, zucchini, cucumber
ECOSUR - PRODUCTOS ECOLÓGICOS DEL SUR S.L.


+34 950 95 29 97
Yearly Turnover: 19.000.000 €
FRUIT & VEGETABLES LA ÑECA, S.L.
Manager: Saúl Escobar
Paraje Pampanico, 257. 04715 El Ejido (Almería, Spain)
+34 950 48 22 31
Yearly Turnover: 15.282.279 €
Main Product: Zucchini and eggplant.
ALFRUIT HORTOFRUTÍCOLA S.L.
Manager: Juan Gabriel Acién Requena
04711 El Ejido (Almería, Spain)
+34 950 49 73 60
Yearly Turnover: 14.357.863 €
Main Product: Fruits and vegetables.
FRUTAS LUNA IMPORT/EXPORT S.L.
Manager: Kees Havenaar
Avda. del Sabinal, 253. 04740 Roquetas de Mar (Almería, Spain)
+34 950 17 86 53
Yearly Turnover: 12.500.000 €
Main Product: Pepper, eggplant, zucchini, tomato, cucumber, citrus, lettuce, broccoli, cherries, melon and watermelon.
COHORSAN, S.C.A
+34 950 53 60 08
Yearly Turnover: 12.000.000 €
Main Product: Pepper, squash, cucumber.
HISPATEC
CEO: José Luis Molina
+34 950 28 11 82
Yearly Turnover: 12.000.000 €
S.A.T. CÍTRICOS DEL ANDARAX
Manager: Juan Torres Ramírez
+34 950 64 60 20
Yearly Turnover: 10.000.000 €
BALCÓN DE NÍJAR HORTOFRUTÍCOLA, S.L.
+34 950 95 59 37
Yearly Turnover: 7.500.000 €
Main Product: Cherry tomato and ecological, sweet pepper and specialty vegetables.
INDUSER
CBO: Pedro Martínez
(Almería, Spain) +34 950 58 11 36
Yearly Turnover: 7.500.000 €
AGRO ANDALEX S.L.
Ctra. Solera. Hoyo Cuenca km 5,600. 04738 Vícar (Almería, Spain)

+34 950 32 88 68
Yearly Turnover: 7.329.048 €
Main Product: Fruits and vegetables.
PONIENTEPLAST S.A.
(Almería, Spain)
+34 950 60 33 25
Yearly Turnover: 7.142.805 €
Main Product: Plastic containers.
KEOPS AGRO
+34 950 29 09 00
Yearly Turnover: 6.200.000 €
CAPITAL GENETIC EBT S.L.
Ctra. de Zamora, 2738. 04738 Vícar (Almería) +34 950 53 95 60

Yearly Turnover: 6.000.000 €
Main Product: Pepper, tomato, cucumber, aubergine and papaya seeds.
AGRAR PLANTAS DEL SUR S.A.
Manager: Carlos Salazar Aina
+34 950 60 77 45
Yearly Turnover: 5.968.065 €
Main Product: Fertilizers.
AGROCOLOR S.L.
Manager: Gerardo Romero Martínez
Ctra. de Ronda, 11 bajo. 04004 Almería (Spain)
+34 950 28 03 80
Yearly Turnover: 5.550.000 €
EUROFINS SICA AGRIQ, S.L.U.

(Almería, Spain)
+34 950 55 43 62
Yearly Turnover: 5.500.000 €
Main Product: Analytical services.
ECOCULTURE BIOSCIENCES, S.L.
Manager: Ángel Ruiz Serna
04001 Almería (Spain) +34 950 26 49 81 www.ecoculturebs.com
Yearly Turnover: 5.000.000 €
CalFlux, Blush, RainbowWave, TipTop, ZimaFlux and Slick.
SEMILLEROS JARICO S.L.
Manager: Laura Parra
a (Almería, Spain) +34 950 46 43 26
Yearly Turnover: 4.723.319 €
Main Product: Seedbed.
PREFORMATI BOX S.L.
04700 El Ejido (Almería, Spain)
Yearly Turnover: 3.250.823 €
GUILLERMO BARRANCO S.L.
Manager: Guillermo Barranco
04700 El Ejido (Almería, Spain). Apdo. de correos 45 +34 950 58 00 60 guille@guillermobarranco.com
Yearly Turnover: 2.359.436 €
Main Product: Logistics.
+34 950 34 53 18 www.envasesjosemiguel.com
Yearly Turnover: 2.037.319 €
Main Product: Packaging. ANDAL EXPORT S.L.
+34 950 56 81 49 andalexport@ncs.es
Yearly Turnover: 2.000.000 €
Main Product: Pepper, squash, aubergine. DE HARO MAÑAS S.L.
+34 950 39 16 78
Yearly Turnover: 1.467.887 €
Main Product: Agricultural machinery.
GRUPO IBERIQOS
Manager: José Enrique Moreno (Almería, Spain) +34 620 73 02 00 gestion@iberiqos.com
Yearly Turnover: 1.000.000 € pepper, aubergine, courgette and other vegetables.
WISE IRRISYSTEM S.L.
CEO: Gabriel Camhi
04700 El Ejido (Almería, Spain)
+34 950 10 17 10
Yearly Turnover: 1.000.000 €
AGRINATURE
(Almería, Spain) +34 950 30 63 34
Main Product: Horticultural seeds and biodegradable parts.
AGROBÍO S.L.

Ctra. Nac. 340, km 419. 04745 La Mojonera (Almería, Spain) +34 950 55 82 20
ALMERIPLANT SEMILLEROS S.L.
(Almería, Spain) +34 950 55 34 10
Main Product: Seedbed, almond tree, pistachio tree.
BIOBEST SISTEMAS BIOLÓGICOS S.L.
Manager: Jordi Portoles Peramo
+34 950 55 73 33
Main Product: Natural pollination and biological control.

EL PLANTEL SEMILLEROS
Ctra. Las Norias, 15. 04745 La Mojonera (Almería, Spain)
+34 950 33 01 01
ENZA ZADEN ESPAÑA, S.L
Subsidiary Sale Manager: Vicente Sanz Carmona
El Ejido (Almería, Spain)
Main Product: Vegetable seeds.
GAUTIER SEMILLAS

+34 635 84 82 73 www.gautiersemences.com gautiersemillas@gautiersemences.eu (tomato, zucchini, lettuce and melon).
GRUPO AGF FASHION S.L.
Manager: Joaquín Hidalgo Martínez
04700 El Ejido (Almería, Spain)
+34 628 46 91 85
Main product: Watermelon.
GRUPO TECNIAGRO
Ctra. Roquetas de Mar, nº 4811. 04738 Vícar (Almería, Spain)
Main Product: Agricultural supply group specialized in intensive production under plastic.

HAZERA Spain 90 S.A.U.
General Manager: Manuel Machado
04710 Santa María del Águila El Ejido (Almería, Spain)
+34 950 58 09 22
Main Product: Vegetable seeds.
HM.CLAUSE IBÉRICA S.A.U.
Paraje Reserva 7. Apdo. de correos 17. 04745 La Mojonera (Almería, Spain)
+34 950 60 34 00
Main Product: Horticultural seeds.
INVER S.A.T.
Manager: Francisco Moreno Carrillo
+34 950 34 24 62
Main Product: Tomato, pepper, melon and cucumber
NEW GROWING SYSTEM S.L.
Manager: Manola Belmonte Mula
Paraje Canadillar, 10. 04640 Pulpí (Almería, Spain)
+34 950 46 44 68
Main Product: Greenhouses, hydroponic systems
PÁEZ ADUANAS
04002 Almería (Almería, Spain)
+34 950 584 646
Main Product: Customs clearance in Spain, France and England.
ROYAL BRINKMAN
Manager Spain: Erik de Smalen
+34 950 34 68 00
TECNOPONIENTE INVERDADEROS, S.L.
Manager: Manuel Villegas Fuentes
+34 950 58 30 54
Main Product: Greenhouses.
VELLSAM MATERIAS BIOACTIVAS
+34 950 36 93 18
Main Product: Vegetal nutrition.
VERDITA S.L.
Chairman: Antonio Bretones Albacete
General Manager: Miguel Ángel Arenas Vergara
04131 Almería (Spain)
+34 637 31 08 01
Main Product: Brown ribbed tomatoes.
FRUSANA

President: Juan Manuel Rodríguez
+34 956 360 231
Yearly Turnover: 42.000.000 €
Main product: Carrots, sweet potato, potato, tomato and other vegetables.
COOP. AGRARIA VIRGEN DEL ROCÍO S.C.A.
+34 956 38 72 42
Yearly Turnover: 32.000.000 €
Main Product: Bunch carrot, sweet potatoes, potatoes,
NTRA. SRA. DE LAS VIRTUDES S.C.A.
+34 956 44 08 35
Yearly Turnover: 32.000.000 €
Main Product: Tomato, pepper, carrot, leek and celery.
PRIMEALE ESPAÑA
Manager: Mikel Elorza Martín de Oliva
Ctra. Nueva Jarilla, km 1. 11591 Jerez de la Frontera
Yearly Turnover: 25.500.000 €
Main Product: Carrot.
SHERRYQUALITY, SL
Finca Vega de la Florida, Parcela 17. Apdo. de correos 2918.
+34 956 11 21 32
Yearly Turnover: 11.000.000 €
Main Product: Potato, zucchini, corn and avocado.
EL CORTIJO BIO S.L.
Manager: Jean Claude Mathaly
+34 956 41 71 88
Yearly Turnover: 7.000.000 €
Main Product: Organic vetegables (sweet potatoes, carrots, red beet, leeks, onions, avocados and mango).
FRONTERA MARKETING, S.R.L.
Manager: Clive Evans
+34 956 73 42 22
Yearly Turnover: 4.000.000 €
Main Product: Chirivia, sweet potato, carrot, corn.
SOUTHERN EXPORTERS S.L.
Manager: Kim Hansen
Avda. 25 de noviembre, bloque 7, casa C.
+34 956 44 20 11
kimhansen@southernexporters.com
Yearly Turnover: 898.777 €
Main Product: Potato, garlic and black garlic.
ARCOVAL 2005 S.L.
Manager: José Martínez Tierno
Main Product: Carrots, conventional and bio.
HORTALIZAS CHIPIONA S.L.
Manager: Francisco Javier Castellano
+34 956 23 00 50
Main Product: Potato, sweet potato, carrot and beet.
PARTIDA ADUANAS (Partida Logistics)
Main Product: Customs clearance and logistics coordination.
EUROSEMILLAS S.A.

Chairman: Juan Cano Ruano
+34 957 42 17 32
Yearly Turnover: 50.000.000 €
gus and pistachio.
SAT GUADEX S.L.
CEO: Juan Antonio Martínez Moya
+34 957 71 04 84
Yearly Turnover: 19.404.000 € watermelon.
SUNARÁN S.A.T.
Manager: Antonio Carmona
+34 957 64 64 64
Yearly Turnover: 17.000.000 €
Yearly Turnover: 594.457 €
Main Product: Carrots.

AJOS PALACIOS
Manager: Juan Palacios Cabrera
+34 957 31 00 95
Main Product: Garlic.
S.A.T. FUENTE EL PINO
Manager: Francisco Rey Calatayud
+34 957 31 37 31
Yearly Turnover: 12.000.000 €
Main Product: Onion and garlic.
LA ABUELA CARMEN
Manager: Manuel Vaquero Ortiz
+34 957 31 04 52
Yearly Turnover: 11.450.000 €
Main Product: Ecological garlic.
GRUPO LA CAÑA. MIGUEL GARCÍA SÁNCHEZ

E HIJOS - EUROCASTELL
Manager: Jesús García
(Granada, Spain)
+34 958 60 10 52
Yearly Turnover: 160.000.000 € and pepper.
GRANADA LA PALMA, S.COOP.AND.
Chairman: Pedro Ruiz
Ctra. Nac. 340, km 342. 18730 Carchuna
(Granada, Spain) +34 958 62 39 03
Yearly Turnover: 153.161.684 €
CENTRO SUR S.Coop.And. (CESURCA)
(Granada, Spain)
+34 958 33 20 20
Yearly Turnover: 26.610.090 €
Main Product: Green, purple, wild & organic asparagus, artichoke, butternut and green beans.
HORTÍCOLA GUADALFEO S.L.
Manager: Antonio Lorente Rivas
Ctra. de la Celulosa, km 199. 18600 Motril (Granada, Spain)
+34 958 60 23 04
Yearly Turnover: 25.000.000 €
Main Product: Tomato specialities and chinese leaves.
FRUTAS LOS CURSOS
Manager: Antonio Rodríguez Antequera
+34 958 63 04 74
Yearly Turnover: 21.350.000 €
Main Product: Custard apple, mango, avocado, medlar.
SEMILLEROS SALIPLANT S.L.
Ctra. Nac. 340, km 341. 18730 Carchuna (Granada, Spain)
+34 958 62 33 76
ECONATUR
+34 957 30 30 13
Yearly Turnover: 10.000.000 €
Main Product: Natural agriculture solutions. Biostimulants,



DAPLAST S.L.
+34 957 32 94 48
Yearly Turnover: 8.600.000 €
NECTFRUIT S.A.T.
Financial Manager: Antonio Cabezas
+34 957 71 60 09
Yearly Turnover: 6.500.000 €
EL PAJIZO S.L.
Manager: Vicente Campo Benito
+34 957 31 00 21
Yearly Turnover: 4.500.000 €
Main Product: Garlic.
ZAMEXFRUIT S.L.L.
Manager: Álvaro Zamora Ortega
+34 957 64 41 36
Yearly Turnover: 4.371.637 €

Main Product: Citrus.
ZANAHORIAS LEONARDO S. L.
+34 957 52 07 25
other species.
S.A.T. CAMPOS DE GRANADA
Manager: Javier Jiménez Medina Avda. de las Palmeras, 9. 18730 Carchuna (Granada, Spain)
+34 958 62 31 36
Yearly Turnover: 54.000.000 €
Main Product: Cherry tomato, cucumber and pepper.
EL GRUPO S.C.A
Manager: Miguel Manzano
(Granada, Spain) +34 958 83 01 46
Yearly Turnover: 52.000.000 € Main Product: Cucumber, tomato cherry, pepper and watermelon.

FULGENCIO SPA
Avda. de las Palmeras, 12. 18730 Carchuna (Granada, Spain) +34 607 911 348 www.camposdegranada.com
Yearly Turnover: 30.000.000 € snack cucumber.
FRUTAS RAFAEL MANZANO E HIJOS, S.L.
(Granada, Spain) +34 958 61 25 88
Yearly Turnover: 29.500.000 €
Main Product: Avocado, cherimoya, mango and loquat.
S.A.T. HORTOVENTAS OPFH Nº 1006
(Granada, Spain) +34 958 36 21 90
presidente@hortoventas.com
Yearly Turnover: 27.000.000 € lettuce and zucchini.
Yearly Turnover: 21.000.000 €
Main Product: Horticultural plants.
LOS GALLOMBARES S.C.A.
(Granada, Spain)
+34 958 31 51 95
Yearly Turnover: 18.600.000 €
Main Product: Fresh green asparagus.
PROCAM S.C.A.
Manager: Fernando Martín
Ctra. Almería, km 1,6. 18600 Motril (Granada, Spain)
+34 958 82 01 97
www.procamsca.com
Yearly Turnover: 16.000.000 €
Organic tomato, pepper and zucchini.
FRUTAS H. FAJARDO, S.L.U.
Manager: José Antonio Fajardo Rodríguez
18611 Molvízar (Granada, Spain)
+34 958 64 40 92
Yearly Turnover: 13.000.000 €
COOPERATIVA AGRÍCOLA SAN FRANCISCO S.C.A (COSAFRA)

Manager: Javier Trujillo
(Granada, Spain) +34 958 33 22 30
Yearly Turnover: 10.500.000 €
Main Product: Asparagus, olive oil, potato, watermelon and artichoke.
18327 Lachar (Granada, Spain)
+34 958 51 30 61
Yearly Turnover: 9.100.000 €
Main Product: Fresh green asparagus..
NOVO FAJARDO S.L.
Manager: José Francisco Novo Bustos
+34 686 91 13 80
Yearly Turnover: 7.800.000 €
Main Product: Cherimoya, avocado, mango and loquat.
CAÑA NATURE S.L.U.
Manager: Javier Valverde García
Avda. de Íncar, 33. 18130 Escúzar (Granada, Spain)
+34 958 05 00 02
Yearly Turnover: 5.000.000 €
morejo, grated tomato, guacamole, avocado pulp and mex sauce.
FRUTAS EL CERVAL S.L.
+34 606 33 44 36
Yearly Turnover: 5.000.000 €
Main Product: Avocado, mango, loquat and cherimoya.
FRUTAS CASTILLA PLÁTANOS-BANANAS S.L.
Manager: Antonio Castilla Camacho
+34 958 43 68 03
Yearly Turnover: 4.651.634 €
IMPORTPATATA S.L.
18015 Granada (Spain)
+34 958 44 05 81
Yearly Turnover: 4.506.190 €
Main Product: Potatoes.
FIJAPLAST S.L.
Manager: José Guarnido García
+34 958 33 24 13
Yearly Turnover: 4.327.604 €
Main Product: Plastics.
S.A.T. Nº 8182 SOL DE FARDES

Manager: Antonio Tejada Olmos
+34 958 69 00 00
Yearly Turnover: 4.200.000 €
Main Product: Peach and nectarine.
FRUTAS RÍO VERDE S.L.
+34 958 63 16 89
Yearly Turnover: 4.068.177 €
FEROFRUIT ALMUÑECAR S.L.

Manager: Félix Rodríguez Antequera
+34 958 63 27 48
Yearly Turnover: 2.900.000 €
EKOBABY S.L.
+34 958 60 40 24
Yearly Turnover: 2.000.000 €
Main Product: Ecological products (cucumber, pepper, tomato, bean, zucchini, eggplant, avocado, cherimoya, loquat, cherry and lime caviar).
FRUTAS & HORTALIZAS BIODOAL S.L.
(Granada, Spain)
+34 655 77 08 20 ventas@biodoal.com
Yearly Turnover: 2.000.000 €
Main Product: Ecological cucumber.
HNOS. RUIZ BALDERAS C.B.
Manager: José Ruiz Balderas Mercagranada. Puestos 102 y 103. 18015 Granada (Spain)

+34 958 20 37 06
Yearly Turnover: 1.500.000 €
ONUBAFRUIT S.C.A.
21001 Huelva (Spain)
+34 959 54 08 44
Yearly Turnover: 260.000.000 €
Main Product: Strawberries, raspberries, blackberries, blue
SUREXPORT COMPAÑÍA AGRARIA S.L.
Manager: Andrés Morales

21730 Almonte (Huelva, Spain)
+34 959 45 15 50
Yearly Turnover: 209.250.000 €
Main Product: Strawberry, raspberry, blueberry and blackberry.
FRESÓN DE PALOS, S.C.A. SANTA MARÍA DE LA RÁBIDA
21810 Palos de la Frontera (Huelva, Spain)
+34 959 65 60 20
GRANADA COATING S.L.


+34 958 62 41 38
Yearly Turnover: 1.200.000 €
Main Product: Seed technologies.
ÉRIDDES INFORMÁTICA INDUSTRIAL, S.L.
Manager: José Luis Prieto
(Granada, Spain)
+34 958 88 70 24
Yearly Turnover: 1.000.000 €
Main Product: Fruttec ERP, Fruttec Analytics, Fruttec Control Fruttec Productivity Control.






CARLOS GARCÍA E HIJOS S.L.
Manager: Carlos García Barrera
+34 958 58 01 54
Yearly Turnover: 970.000 €
Main Product: Onion & garlic.
NECOMI S.L.
Manager: Julio Raya Bolívar
+34 958 13 57 09
Yearly Turnover: 287.865 €
Main Product: Garlic, onion, asparagus, peaches, and grapes. HORTOVILLA SDAD. COOP. AND.
Avda. Andalucía, 65. 18369 Villanueva Mesía (Granada, Spain)
+34 958 44 43 47 hortovilla@yahoo.es
Main Product: Asparagus, green beans and artichoke.
Yearly Turnover: 165.000.000 €
Main Product: Strawberry, blueberry, raspberry and blackberry.
AROFA S.L
Manager: Francisco Arotzarena Marín
Ctra. Ayamonte, km 121. 21440 Lepe (Huelva, Spain)
+34 959 38 30 48
Yearly Turnover: 130.000.000 €
Main Product: Berries and chestnuts.
CUNA DE PLATERO S.C.A

+34 959 37 21 25
Yearly Turnover: 125.000.000 €
Main Product: Strawberry, raspberry, blackberry, blueberry and pitahaya.
FRUTA DE ANDALUCÍA, S.C.A.
Manager: Juan Manuel Vivas
+34 959 37 29 45
Yearly Turnover: 110.000.000 €
Main Product: Strawberries, raspberries, blueberries, Pilonar, Pilonar Berries, La Condesa, Lujovi, Frescolon,

GRUPO TRANSONUBA S.L.
(Huelva, Spain)
+34 959 36 38 48
Yearly Turnover: 103.465.164 €
S.C.A. COSTA DE HUELVA
21820 Lucena del Puerto (Huelva, Spain)
+34 959 36 01 36
Yearly Turnover: 86.456.998 €
Main Product: Strawberry, raspberry, blueberry, blackberry and avocado.
COOPERATIVA AGRARIA HORTOFRUTÍCOLA DE CARTAYA

S.COOP.AND.
+34 959 39 10 88
Yearly Turnover: 64.500.000 €
Main Product: Strawberry, blueberry, raspberry and kaki.
S.C.A. NTRA. SRA. DE LA BELLA - COBELLA

+34 959 38 31 62
Yearly Turnover: 55.000.000 €
Main Product: Strawberry, raspberry, blueberry and
SMURFIT KAPPA HUELVA S.A.
Manager: Eugenio Rodríguez Zambrano
21700 La Palma del Condado (Huelva, Spain)
+34 959 40 28 53
Yearly Turnover: 54.000.000 €
PLUS BERRIES
President: Javier Velo Prieto
PCTH 200. 21110 Aljaraque (Huelva, Spain)
+34 959 04 19 07
Yearly Turnover: 51.000.000 €
Main Product: Strawberries, raspberries, blueberries, black
S.A.T. GRUFESA
+34 959 37 23 35
Yearly Turnover: 45.204.285 €
Main Product: Strawberry.
S.A.T. LAS PALMERITAS
+34 959 38 33 01
Yearly Turnover: 42.000.000 €
Main Product: Strawberry.
S.A.T. CONDADO DE HUELVA

21720 Rociana del Condado (Huelva, Spain)
+34 959 41 62 87
Yearly Turnover: 39.500.000 €
Main Product: Strawberry, raspberry, blackberry, blueberry.
MOGALLA S.A.T.
21450 Cartaya (Huelva, Spain)
+34 959 39 02 83
Yearly Turnover: 30.000.000 € Main Product: Oranges.
S.A.T. ALGAIDA PRODUCTORES
General Manager: Francisco Marín
Yearly Turnover: 25.000.000 €
Main Product: Strawberry, raspberry, blueberry, blackberry. Organic strawberry, organic raspberry and organic pomegranate.

BONAFRÚ S.C.A. HORT. DE BONARES
(Huelva, Spain)
+34 959 36 61 33
Yearly Turnover: 16.000.000 €
Main Product: Strawberry, rapsberry and blueberry.
TIERRAS DEL CONDADO S.L.
Manager: José Manuel Romero
21730 Almonte (Huelva, Spain)


+33 959 41 21 86
Yearly Turnover: 12.500.000 €
Main Product: Strawberry, raspberries, blackberries and blueberries.
LUCENA FRUIT S.L.


Manager: Juan Camacho
+34 959 50 00 02
Yearly Turnover: 12.392.462 €

Main Product: Berries.
ALFRUT S.A.T. H-0011
Manager: José Manuel Cantarero Cabello
Ctra. Ayamonte, km 115. Apdo. de correos 178.
21440 Lepe (Huelva, Spain)
+34 959 38 46 18
Yearly Turnover: 22.000.000 €
Main Product: Strawberry, raspberry, blueberry, kaki and citrus.
SURBERRY
Chairman: Harold Huot
+34 959 24 14 26
Yearly Turnover: 18.000.000 €
Main Product: Conventional and bio berries.

FLOR DE DOÑANA BIORGANIC
Manager: Juan María Rodríguez
+34 959 02 63 32
Yearly Turnover: 17.000.000 € pomegranate and goyi. All bio products.




NECTALIA - FIRST FRUIT S.L.
Manager: Marc Espagnach
CC. Bellavista, Pl. 1, local 23. Avda. de los Príncipes.
21110 Aljaraque (Huelva, Spain)
+34 959 30 18 92
Yearly Turnover: 12.000.000 €
FRES PALOS S.A.T.

21810 Palos de la Frontera (Huelva, Spain)
+34 959 35 11 54
Yearly Turnover: 11.595.406 €
Main Product: Strawberry and blueberry.
DOÑANA FRESA S.C.A.
Manager: Fernando Pérez Andrade
+34 959 50 62 20
Yearly Turnover: 6.236.176 €


Main Product: Strawberry and raspberry.
GOROFRES S.A.T. 7523
+34 959 35 10 62
Yearly Turnover: 6.157.378 €
PERLA HUELVA
+34 959 41 78 44
Yearly Turnover: 5.500.000 €
Main Product: Raspberry, strawberry and blueberry.
FRUTEMSA S.A.
Manager: Ángel Embid Escolano
+34 959 35 63 10
Yearly Turnover: 4.254.211 €
Main Product: Citrus.
EARIS & BERRYPRO, S.L.U. (EARIS - Packing & Sorting)

CEO: Juan José Cruz Acosta
21440 Lepe (Huelva, Spain)
+34 959 87 18 14
Yearly Turnover: 3.300.000 €
TASEMAR EXPORT S.L.

Chairman: Ana Pérez Soto (Huelva, Spain)
Yearly Turnover: 2.500.000 € Main Product: Strawberry.
FRESAS NUEVOS MATERIALES S.A.
General Manager: Juan Manuel Arenas Pizarro
+34 959 80 98 91
Yearly Turnover: 2.483.000 €
Main Product: Strawberry varieties.
PRODUCTORA CORCHITO S.L.
Manager: José Antonio Oria Ruiz
+34 670 61 19 60
Yearly Turnover: 2.295.497 €
Main Product: Citrus.
FRESSAN DE LEPE S. L.
Manager: Manuel Santana Camacho
+34 959 38 01 56
Yearly Turnover: 1.168.281 €


Main Product: Strawberry.
FRESAS DE HUELVA S.L.
21710 Bollullos del Condado (Huelva, Spain)
+34 959 40 80 94 nachoreale@hotmail.com
Yearly Turnover: 1.000.000 €
Main Product: Strawberry, raspberry, grape and cherry.
LA FRESSA EXPORT IMPORT S.L.
21440 Lepe (Huelva, Spain) +34 959 38 24 12 lalepera@lalepera.com


Yearly Turnover: 612.074 €
Main Product: Strawberry and raspberry.
NEWPATENT S.L.
Manager: Miguel Salas
Yearly Turnover: 476.809 €
CÍTRICOS THARSIS S.A.
Manager: Antonio Castillo
+34 959 39 75 20
Yearly Turnover: 315.742 €
Main Product: Citrus.
BERRYWORLD IBERIA




Main Product: Strawberries, raspberries, blueberries, blackberries and niche berries.
BERRYNEST S.A.T. H-0023
Manager: Juan Soltero Pardo (Huelva, Spain)
+34 959 45 06 56
Main Product: Organic and conventional berries.
DOÑANA 1998
Manager: Manuel Matos
+34 615 01 49 06
Main Product: Strawberries alveolar tray (eggbox), strawberries, blueberries, blackberries, raspberries, tangerines and oranges.
INTER TERRA SAT DE RL
Manager: Juan Soler
Ctra. Nac. 431, km 122. 21440 Lepe (Huelva, Spain)
+34 959 38 31 26
Main Product: Specialist in Sharoni persimmon, Sharon and Rojo limes, blueberries (conventional and organic). Brands: Sharoni and Medina.
JOTE S.C.A.
+34 959 37 05 10
Main Product: Strawberry.
LUJOVI S.C.A.
Chairman: Antonio Gutiérrez Padilla
+34 959 41 67 75
Main Product: Strawberry, raspberry and blueberry.
S.C.A. AGROMOLINILLO
+34 959 37 12 36
agromolinillo@agromolinillo.com





Main Product: Berries and citrus.
AJOS GALLARDO
Manager: Juan Garrido
Ctra. de Martos, 13. 23658 Jamilena (Jaén, Spain)
+34 953 41 72 24
Yearly Turnover: 1.500.000 €
Main Product: Garlic and black garlic.
JOSÉ LUIS MONTOSA S.L.
Manager: José Luis Montosa
+34 952 51 35 33
Yearly Turnover: 160.000.000 €
Main Product: Avocado, mango and guacamole.
S.A.T. TROPS

CEO: Enrique Colilles Cascallar
+34 952 50 07 00
Yearly Turnover: 148.000.000 €
Main Product: Avocado and mango.
REYES GUTIÉRREZ S.L.
Managing director: Juan Antonio Reyes Gutiérrez
+34 952 50 56 06 comercial@reyesgutierrez.com
Yearly Turnover: 68.000.000 € le, natural sauces.

Yearly Turnover: 40.000.000 €
Main Product: Organic avocado.

FRUNET S.L.
Manager: Antonio Manuel Lavao
+34 952 52 75 10
Yearly Turnover: 40.000.000 €
Main Product: Organic vegetables, pineapples, mangoes and avocados.

ALCOAXARQUÍA, S.L.
Manager: José Antonio Alconchel
+34 951 333 933
Yearly Turnover: 36.000.000 €
Main Product: Avocado, mango, oranges and sweet potato.
BROKAW ESPAÑA S.L.
Manager: Juan Ferrer
+34 952 03 03 62
TROPICAL MILLENIUM S.L.

+34 952 50 72 40
Yearly Turnover: 53.000.000 € Main Product: Avocado, mango, papaya and pitaya.

AXARFRUIT S.L.
Manager: Álvaro Martínez
+34 952 54 95 62
Yearly Turnover: 52.000.000 € Main Product: Avocado and mango.
NATURAL TROPIC S.L.
+34 952 50 77 09 administracion@naturaltropic.es

Yearly Turnover: 50.000.000 €
Main Product: Avocado, mango, cherimoya, kumquat and loquat.
Yearly Turnover: 14.000.000 €
SIGFRIDO S.L.
+34 951 91 99 44
Yearly Turnover: 14.000.000 €
Main Product: Avocado and mango.
PELUCHE CASTILLO NAVAS S.L.
Manager: Antonio Santiago Castillo Navas
+34 952 55 08 81
Yearly Turnover: 10.000.000 €
Main Product: Mango, avocado and sweet potato.
SERAGRO INTEGRAL
Yearly Turnover: 5.900.000 €
Main Product: Plant nutrition and biostimulants.
EMBASUR S.L.
+34 952 50 07 50
Yearly Turnover: 5.775.434 €
Main Product: Packaging.
MESBONSA S.L.
Manager: Antonio Medina Salvatierra
+34 952 53 07 00
Yearly Turnover: 5.000.000 €
NORDEN AGRO
TRÓPICO SPAIN

Manager: Óscar Ramírez
+34 951 23 79 66
Yearly Turnover: 47.000.000 €
Main Product: Avocado and mango.
EUROFRESH V&F
Owner and Founder: Francisco Claros
+34 951 20 40 49
+34 952 04 11 99
www.quimsaitw.com
Yearly Turnover: 3.000.000 €
Main Product: Oxi Premium 15.
XARKI S.L.
Manager: Francisco Ruiz Martín
+34 952 50 05 42
Yearly Turnover: 2.989.794 €
Main Product: Avocado, mango, kumquat and chestnuts.
BALCÓN DE EUROPA S.C.A.
+34 952 52 00 48
Yearly Turnover: 2.500.000 €
Main Product: Ecological sweet potato.
FRUTAS FAUSTINO S.L.
Manager: Faustino Rodríguez Gutiérrez (Sevilla, Spain)
+34 954 26 08 68
Yearly Turnover: 41.117.270 €
MARTIMAR (HIJOS DE ENRIQUE MARTÍN S.A.)
Chairman: Francisco de Asís Riego Martín
CEO: Francisco Riego Ramos Mercasevilla. Apdo. de correos 13246. 41080 Sevilla (Spain)
+34 954 99 88 10
PALTAVO Manager: Óscar Ramírez
+34 951 17 19 95
Yearly Turnover: 2.000.000 €
EUROBERRY MARKETING S.A.



Manager: Javier Rico
26. 41018 Sevilla (Spain)
+34 954 93 23 17
Yearly Turnover: 160.000.000 €
Main Product: Blueberries and raspberries.
FRESHROYAL
Hacienda La Jarilla. Apdo. de correos 47.
41300 San José de La Rinconada (Sevilla, Spain)
+34 954 79 15 11
Yearly Turnover: 130.000.000 €
REYENVAS S.A.
+34 955 63 15 40
Yearly Turnover: 66.211.478 €
Yearly Turnover: 38.000.000 € and vegetables.
S.A.T. 0039 SÍNTESIS
Manager: José Rodríguez Carrascal
+34 902 70 24 22
Yearly Turnover: 32.000.000 €
Main Product: Citrus (oranges, clementines, tangerines and
GRUPO ARRÉBOLA S.L.
41309 La Rinconada (Sevilla, Spain)
+34 954 68 61 89
david@patatasarrebola.com
Yearly Turnover: 23.200.000 €
Main Product: Potato.
Yearly Turnover: 18.000.000 €
Main Product: Concentrated tomato.
PATATAS RUBIO MARTÍNEZ
pa_ru_mar@hotmail.com
Yearly Turnover: 14.568.432 €
Main Product: Potato.
DISTRISUR AGRÍCOLA S.L.
Manager: José Porcel
Ctra. Bética, 8. 41300 San José de la Rinconada (Sevilla, Spain)
+34 954 79 57 00 distrisur@distrisur.net

Yearly Turnover: 14.500.000 €
Main Product: Potato.
ALCAFRUIT – PRODUCTORES DEL CAMPO S.C.A.
Manager: Rocío Soriano (Sevilla, Spain)
+34 954 78 08 10
Yearly Turnover: 12.000.000 €
CONTAGRI, S.L.
+34 670 20 38 09
Yearly Turnover: 12.000.000 €
Main Product: Potato and broccoli.

RENTA DE MAQUINARIA SLU
Manager: Luis José Álvarez Álvarez
+34 954 40 50 21
Yearly Turnover: 9.081.601 €
Main Product: Agricultural machinery.
TECNIFRÍO SEVILLA S.C.A
+34 954 45 12 99
Yearly Turnover: 6.000.000 €
FRUTAS Y VERDURAS SANPOR S.L.
INTERSUR 2011, S.A.
41300 San José de La Rinconada (Sevilla, Spain)
+34 955 79 00 07
Yearly Turnover: 20.040.247 €
Main Product: Spanish new potato.
CÍTRICOS ANDALUCES S.A.T. 3719

CEO: Juan Francisco Gil Ruiz
+34 955 03 12 50
Yearly Turnover: 19.060.322 €
ANDPATFRUT, S.L.
AGQ LABS



Manager: Estanislao Martínez
Avda. La Palmera, 27. 41013 Sevilla (Spain)
+34 955 73 89 08
Yearly Turnover: 50.000.000 €
des, residues, heavy metal and other contaminants analysis, crop nutritional monitoring, environmental inspections and analysis.


41850 Villamanrique de la Condesa (Sevilla, Spain)
+34 955 75 54 41
Yearly Turnover: 18.000.000 €
Main Product: Potato, watermelon, melon and pumpkin.
LAS MARISMAS DE LEBRIJA SCA
Manager: Manuel Caro Gallardo
+34 955 97 70 11
Mercasevilla. Nave 1, puesto 8. 41020 Sevilla (Spain)
+34 954 51 67 59
Yearly Turnover: 5.675.961 €
Main Product: Wholesaler.
MEIJER IBÉRICA S.L.
Manager: Javier Boceta
Avda. Jerez 60, piso Bajo A. 41014 Sevilla (Spain)
+34 954 61 16 26
Yearly Turnover: 4.604.256 €
Main Product: Potato.
SESUR SEMILLA Y EXPORTACIÓN S.L.U.
Apdo. de correos 20008. 41020 Sevilla (Spain)
+34 647 62 57 88
Yearly Turnover: 4.500.000 €
Main Product: Potato and services.
VIVEROS SEVILLA S.A.

Manager: Carlos Carrascosa (Sevilla, Spain)
+34 955 65 59 20
Yearly Turnover: 3.214.147 €



Main Product: Citrus trees.
BIOGELVES, S.L.
+34 954 11 56 88
biogelves@hotmail.com

Yearly Turnover: 3.177.410 €
Main Product: Beet, carrot, patato and corn.
COMERCIALIZADORA ANDALUZA DE PATATAS S.L.
Manager: José Luis Benítez Acosta
+34 954 79 57 20
Yearly Turnover: 2.860.599 €
Main Product: Potato.
MANTENIMIENTOS FRIGORIFICOS SEVILLA S.L.U.
41960 Gines (Sevilla, Spain)
+34 607 77 42 62
Yearly Turnover: 2.520.000 €
SOHISCERT S.A.
Manager: Eduardo Merello Álvarez
+34 955 86 80 51
www.sohiscert.com

sohiscert@sohiscert.com
Yearly Turnover: 2.112.921 €
CABECO
+34 954 58 12 01
Yearly Turnover: 1.656.175 €
BÉTICA DE EMBALAJES S.L.
Manager: Manuel Blanco Tejera
Mercasevilla. 41020 Sevilla (Spain)
+34 954 51 30 31
www.beticaembalaje.com betica@beticaembalaje.com
Yearly Turnover: 1.309.368 €
Main Product: Packaging.
EXPLACO SEVILLA S.A.
Mercasevilla. Nave 2, puesto 65. 41020 Sevilla (Spain)
+34 954 51 75 30
Yearly Turnover: 1.245.226 €
Main Product: Wholesaler.
PATATAS SÁNCHEZ S.L.
Manager: Mercedes Valle Campos
+34 955 79 21 50
Yearly Turnover: 540.000 €
Main Product: Potato.
ANPASOL
Avda. Ferrocarril, 4. 41320 Cantillana (Sevilla, Spain)
+34 955 73 17 92
Main Product: Potato.
AZCAVAL TECNOLOGÍA DEL ENVASADO S.L
Guadaira (Sevilla, Spain)
+34 954 91 14 75 administracion@azcaval.com
CRESPO CAMINO EXPLOTACIONES AGRÍCOLAS S.A
+34 954 23 18 26 crescasa@crescasa.com
Main Product: Potatoes.
FALL CREEK FARM & NURSERY EUROPE, S.L.U.
Hans Liekens
Spain)
+34 954 49 19 31
Main Product: Blueberry plants genetics, blueberry plants nursery stock.
COOPERATIVA AGRÍCOLA OSSO DE CINCA
Chairman: José Poy
+34 974 45 61 61
Yearly Turnover: 3.800.000 €
Main Product: Peach and nectarine.
NAMIFRUITS S.C.
+34 658 58 55 83
Yearly Turnover: 500.000 €
COOP. SAN MIGUEL - COFRUVAL
Manager: Arsenio Rújula
+34 978 83 80 00
Yearly Turnover: 6.121.268 €
Main Product: Yellow peach, red peach, white peach, donut peach, apricots, pears, apples and plums.








PRODUCTOS DE CALANDA S.L.
Manager: María Rosa Aznar Bondia
+34 978 84 70 03
Yearly Turnover: 784.618 €
Main Product: Calanda’s peach.

IRRITEC IBERIA S.A.
President: Guillermo O’Shanahan
Spain)
SUMMER FRUIT S.L.
+34 974 45 39 15
Yearly Turnover: 18.000.000 €
IBERECO PRODUCCIONES ECOLÓGICAS S.L

Manager: José Guarné Buisan
+34 973 78 07 42
Yearly Turnover: 8.500.000 €
GLOBAL HMG SAT 9997
Manager: Ángel María Miguel García (Huesca, Spain)
+34 610 46 16 73
Yearly Turnover: 6.060.000 €
FRUTARIA
Alberto Prieto
+34 976 46 94 59
Yearly Turnover: 100.000.000 €
varieties plants and rootstocks, technical support).



AGRÍCOLA GIL S.L.
Manager: Pedro Gil
(Zaragoza, Spain)
+34 976 81 22 40
Yearly Turnover: 45.000.000 €
Main Product: Apple, pear, melon, watermelon, strawberries, necta rines, plums, cherries, peppers and tomatoes.
FUENCAMPO XXI, S.L.
+34 976 50 40 26
Yearly Turnover: 15.000.000 €
Main Product: Sweet onion.
COSANSE
Manager: Alberto Navarro Cabrejas
Avda. de Madrid, 15. 50100 La Almunia (Zaragoza, Spain)
+34 976 60 00 50 www.cosanse.com cosanse@cosanse.com
Yearly Turnover: 10.000.000 €
peaches, apples and pears. Extra virgin olive oil.
LA CHIPRANESCA S.C.L. O.P.F.H. Nº 302
Chairman: Valentín Acero Piazuelo
+34 976 63 72 40
Yearly Turnover: 8.000.000 €
Main Product: Peach and nectarine.
JUMOSOL FRUITS S.L.
+34 976 16 10 40
Yearly Turnover: 7.500.000 €
Main Product: Extra sweet onion, brown onion, red onion, white onion, green onion and shallot.
DRUPO SOCIEDAD COOPERATIVA
+34 976 77 07 29
drupo9447@gmail.com
Yearly Turnover: 7.000.000 €
ORCHARD FRUIT COMPANY S.L.
+34 976 81 90 60
Yearly Turnover: 6.250.679 €
Main Product: Apple, pear and cherry.
FRUTAS ERRUZ S.L.
Manager: Arturo Erruz Erruz
+34 976 88 33 33
Yearly Turnover: 5.516.979 €
Main Product: Pear and apple.
FRUTAS HERMANOS AGUILAR S.L.
Manager: Pascual Aguilar Montero Avda. San Blas 15. 50200 Ateca (Zaragoza, Spain)
+34 976 84 23 13
Yearly Turnover: 4.743.742 €
Main Product: Apple and pear.
FRUTAS TABERNER S.L.
Manager: Alberto José Taberner Albiac
+34 976 63 52 27
Yearly Turnover: 3.777.041 €
A. BERDEJO S.L.
Manager: Javier Berdejo
+34 976 78 44 30
Yearly Turnover: 1.629.653 €
Main Product: Apricot bio.

METOS IBERIA, S.A.
Manager: Álvaro Velasco
+34 976 14 47 00
adminiberia@metors.at
Yearly Turnover: 1.000.000 €
Main Product: Weather stations.
FEITO Y TOYOSA
Manager: Francisco Feito Feito Mercasturias, nave 6. 33192 Llanera (Asturias)
+34 985 26 22 58
Yearly Turnover: 31.023.848 €
Main Product: Fruits, vegetables and potato.
KIWIS LA ISLA
Manager: Juan Cimas
+34 610 46 61 46
Main Product: Kiwi.
VEGA DE AGUÍN, S.L.
Manager: Manuel Cimas
(Asturias, Spain)
+34 609 80 15 17 www.vegadeaguin.com
Main Product: Kiwi.
COOP. DEL CAMPO SANTA MÓNICA S.C. DE C-LM
Yearly Turnover: 20.000.000 €
(Ciudad Real, Spain)
+34 926 52 34 56
penarroya@ucaman.es
Yearly Turnover: 7.000.000 €
Main Product: Melon, wine and cereals.
AGROBORJA S.L.
Manager: Antonio Borja Crespo
13230 Membrilla (Ciudad Real, Spain)
+34 639 88 24 18
Yearly Turnover: 5.000.000 €
Main Product: Melon and watermelon.
COMERCIAL AGROMANCHA S.L.
Manager: Juan Ángel Gutiérrez Colado
+34 926 85 15 77
Yearly Turnover: 3.269.370 €
Main Product: Melon, watermelon and pumpkin.
S.A.T. HORTIMÁN 9775
AGROMAR HISPANA S.A.
02080 Albacete (Spain)
+34 967 24 07 10
Yearly Turnover: 19.773.000 €
Main Product: French potatoes.
A.G. VILLODRE, S.L.
Manager: Andrés y María García de Lis
02630 La Roda (Albacete, Spain) +34 967 44 01 26 www.antogar.com
Yearly Turnover: 6.000.000 €
Main Product: Garlic.
DISPAMAN EXPORT-IMPORT S.L.
Manager: Juan Manuel Padilla Jiménez Avda. Santiago. 02320 Balazote (Albacete, Spain)
+34 967 36 01 54
Yearly Turnover: 5.673.974 €
Main Product: Garlic.
HIDROLAB S.L.
Manager: Ángel Polo Rodríguez
+34 967 22 41 33 www.hidrolab.es
Yearly Turnover: 337.556 €
Main Product: Laboratory.
CEREALES BORRASCAS S.L.
Ctra. de La Solana, 11. 13230 Membrilla (Ciudad Real, Spain) +34 606 93 98 43
Yearly Turnover: 21.000.000 €
Main Product: Melon and watermelon.
SOLMESAN, S.L.
(Ciudad Real, Spain) +34 926 69 61 43
Yearly Turnover: 19.200.000 €
Main Product: Melon and watermelon.
MERCOMANCHA S.A.
Chairman: Antonio Atienza
(Ciudad Real, Spain) +34 926 61 05 70
Yearly Turnover: 10.000.000 €
Main Product: Melon and watermelon.
S. C. A. NTRA. SRA. DE PEÑARROYA
Manager: Valentín Ramírez Serrano
Camino del Campo, 3. Apdo de correos 79.
13700 Tomelloso (Ciudad Real, Spain)
+34 610 52 75 17
Yearly Turnover: 1.800.000 €
Main Product: Melon and watermelon.
AGRÍCOLA JJF
Manager: José Luis Agudo
13220 Llanos del Caudillo (Ciudad Real, Spain)
+34 926 64 41 55
Yearly Turnover: 1.500.000 €
Main Product: Melon, pumpkin and watermelon.
MENCHERO LA MANCHA IMPORT & EXPORT
(Ciudad Real, Spain)
+34 926 87 14 17 www.mencherolamancha.es
Yearly Turnover: 1.456.700 €
Main Product: Onions.
NÚÑEZ GARCÍA Y PERICO S.L.
Ctra. Nacional 430, km 365,5. 13200 Manzanares (Ciudad Real, Spain)
+34 926 61 42 81 www.elcaballeroandante.net meloneselcaballeroandante@gmail.com
Yearly Turnover: 1.000.000 €
Main Product: Melon, watermelon and pumpkin.
VILLALTA VALERO S.L.
Manager: Antonio Villalta Jiménez
Ctra. Nacional 430 a, km 366,2. 13230 Membrilla (Ciudad Real, Spain)
+34 649 41 67 68
Yearly Turnover: 700.000 €
Main Product: Melon, watermelon and pumpkin.
CARBOTECNIA, S.L.
13200 Manzanares (Ciudad Real, Spain)
+34 926 61 32 42
Main Product: Carbosoil.
COOP. SANTIAGO APÓSTOL DE TOMELLOSO
Manager: Amparo Perona
Tomelloso (Ciudad Real, Spain)
+34 926 51 14 95
Main Product: Melon.
AJOESCAR S.L.
Manager: Antonio Escudero
+34 967 16 30 74
ajoescar@gmail.com
Yearly Turnover: 2.980.000 €
Main Product: Garlic.
TERRALLANA NATURAL S.L.
Chairman: María Moreno Rojo
+34 925 56 43 15
Yearly Turnover: 3.000.000 €
Main Product: Garlic.

PATATAS HIJOLUSA
+34 987 21 56 34
LA VEGUILLA

(Cuenca, Spain) +34 967 16 03 51
Yearly Turnover: 62.000.000 €
Main Product: Garlic.
GRUPO LOMAR
Polígono 13, parcela 42. 16470 Zarza de Tajo (Cuenca, Spain)
+34 918 93 72 21
Yearly Turnover: 40.000.000 €
Main Product: Garlic and onions.
COOPAMAN S.C.L.
+34 967 16 05 36
Yearly Turnover: 32.000.000 €
Main Product: Garlic.
SAN ISIDRO EL SANTO SDAD. COOP. C-LM
Manager: María José Arellano García
+34 967 16 01 11
Yearly Turnover: 15.831.440 €
Main Product: Purple and white garlic and spring garlic (white and purple).
BUSINESS INTERNATIONAL GARLIC S.L

Manager: Juan Carlos Navarro
+34 965 43 31 27
Yearly Turnover: 12.900.000 €
Main Product: Garlic.

HORTOFRUTÍCOLA AGROCAMAN S.L.
Yearly Turnover: 91.000.000 €
Main Product: Potato and sweet potato.
CASTAÑAS CAMPELO EXPORTACIÓN S.A.
+34 987 54 00 64
Yearly Turnover: 8.000.000 €
Main Product: Garlic, chestnut, onion and nuts.
CMR LEÓN
+34 987 20 52 00
FORJADOS SANITARIOS CAVITI, S.L.
Manager: Antonio Sanz Avda. Manuel Rivera 3. 34002 Palencia (Spain) +34 979 693 889
TABUENCA S.A.
Manager: Bernardo Tabuenca Luengo
+34 921 14 18 56
Yearly Turnover: 19.727.000 €
Main Product: Vegetables, mainly carrots and leeks.

HIJOS DE TEODORO MUÑOZ, S.L.
+34 921 16 00 26
elcampo@precocinadoselcampo.com
Yearly Turnover: 8.397.972 €
VIVEROS RÍO ERESMA S.L.
+34 921 57 51 95
Yearly Turnover: 4.179.065 €
Main Product: Strawberry plants.
VIVEROS CARBONERO S.L.
Travesía Segovia, 2. 40270 Carbonero El Mayor (Segovia, Spain)
+34 921 56 01 20
Yearly Turnover: 2.962.599 €
Main Product: Strawberry plants.
VIVEROS NAVALFRESA S.L.
Manager: Víctor Sanz
Camino de Carbonero. 40280 Navalmanzano (Segovia, Spain)
+34 921 57 52 11
Yearly Turnover: 2.072.417 €
Main Product: Strawberry plants.
PLANTBERRYS
Chairman: Frutos Herranz Pascual
+34 667 76 23 02 viveplant@yahoo.es
Yearly Turnover: 2.000.000 €
Main Product: Strawberry and raspberry plants.
ECOMANJAR
Manager: María Jesús Vinent Florit
+34 921 16 92 38
Main Product: Ecological agriculture.

FERMAQ MAQUINARIA HORTÍCOLA
Chairman: Fernando Martín
+34 921 57 74 50
MARTÍN MAQ (Segovia, Spain)
+34 921 12 21 22
PLANTAS DE SEGOVIA S.L.
HUERCASA


CEO: Félix Moracho
+34 921 16 00 06
Yearly Turnover: 50.000.000 €
Main Product: Cooked sweet corn cob in vacuum and cooked beetroot.
Yearly Turnover: 5.000.000 €
Main Product: Onion and garlic.
SDAD. COOP. DEL CAMPO GLUS I
Manager: Jesús Esteban Alonso
+34 921 14 22 33
Yearly Turnover: 22.140.090 €
Main Product: Onions, potatoes and carrots.
+34 659 91 44 61
Main Product: Strawberry and raspberry plants.
S.A.T. LA MODESTA
+34 605 08 48 18 agromodesta@gmail.com
Main Product: Bunch carrot and strawberry plants.

VIVEROS CAMPIÑAS S.C.A.
Manager: Mario Luis Herranz Pedriza
+34 921 15 55 06
Main Product: Strawberry plants, asparagus and other berries.
CULTIVAR S.A.U.
Manager: Pedro Sitjar
Mercabarna. Longitudinal 9, 39. 08040 Barcelona (Spain) +34 932 61 87 00
Yearly Turnover: 214.000.000 €
Main Product: Wholesalers and importers.
INTERMÁS NETS S.A.
Manager: Francois Moucheet
08450 Llinars del Vallés (Barcelona, Spain)
+34 938 42 57 00
Yearly Turnover: 77.990.857 €
Main Product: Plastic packaging.
GV EL ZAMORANO S.A.
Manager: Miguel García Vacas
(Barcelona, Spain) +34 933 35 40 40
Yearly Turnover: 63.000.000 €
Main Product: Potato.
VIVEROS SECUEDUCTOS S.L.

+34 653 08 32 39 www.viverossecueductos.com
Main Product: Potatoes, garlic, leeks, chickpeas, beans and
CMR GROUP

CEO: Carles Martí Sousa (Barcelona, Spain)
+34 932 62 66 00
Yearly Turnover: 185.000.000 €
DU PONT IBÉRICA S.L.
+34 985 124 000 www.dupont.com
Yearly Turnover: 173.506.000 €
Main Product: Crop protection.
BARGOSA S.A.
Manager: Santiago Torres Benedicto
GRUPO LORENZO CARRASCO
Chairman: Lorenzo Carrasco
Calle Longitudinal 7, nº 65. Mercabarna.
08040 Barcelona (Spain) +34 935 56 16 29
Yearly Turnover: 60.000.000 €
Main Product: Fruits and vegetables.
JUNGHEINRICH DE Spain SAU
08630 Abrera (Barcelona, Spain)
+34 937 73 82 00 www.jungheinrich.es

Yearly Turnover: 59.943.340 €
VERIPACK EMBALAJES
Campo (Valladolid, Spain)
+34 983 81 29 20 www.patatasmelendez.com melendez@patatasmelendez.com

Yearly Turnover: 110.000.000 €
Main Product: Potato.
FITOTRANS S.A.
Manager: Carlos M. de la Fuente de Prado
+34 983 30 42 99
Yearly Turnover: 7.400.000 €
Main Product: Agrochemicals logistics and transportation.








BASF AGRO ESPAÑA
Manager: Patricio Fitz Simon
Yearly Turnover: 8.200.000.000 €
Main Product: Crop protection.
08040 Barcelona (Spain)
+34 932 62 85 85
Yearly Turnover: 170.000.000 €
GIRO GH S.A.
Manager: Antonio Santamans Oliver
+34 933 84 10 11
Yearly Turnover: 135.000.000 €
Main Product: Net packaging systems.
+34 937 29 20 10
Yearly Turnover: 50.815.000 €
Main Product: Plastic packaging.
KNAUF INDUSTRIES ESPAÑA
Food Market Spain: José Ángel Verdial (Barcelona, Spain)
+34 938 90 69 05
Yearly Turnover: 50.000.000 €
RIEGOS IBERIA REGABER S.A.
Manager: Candi Cervera
08150 Parets del Vallés (Barcelona, Spain) +34 935 73 74 00

Yearly Turnover: 50.000.000 €
MORALES E HIJOS S.A.
SQM IBERIAN S.A.

+34 934 87 78 06
Yearly Turnover: 130.000.000 €
Main Product: Crop production.
08040 Barcelona (Spain)
+34 932 626 450
www.moralesehijos.com
Yearly Turnover: 49.441.407 €
Main Product: Wholesaler.
MAPEI SPAIN, S.A.
Manager: Francesc Busquets
08130 Santa Perpetua de Mogoda (Barcelona, Spain)
+34 933 43 50 50 mapei@mapei.es
Yearly Turnover: 45.700.000 €
Main Product: Planitop HPC Floor.
HNOS. FERNÁNDEZ LÓPEZ - BIOMARKET

08040 Barcelona (Spain)
+34 935 56 85 65
Yearly Turnover: 295.000.000 €
Main Product: Wide bio range with more than





GRUPO DIEGO MARTÍNEZ

Longitudinal 9, nº 114, Mercabarna. 08040 Barcelona (Spain)
+34 932 62 01 21
Yearly Turnover: 86.000.000 €
FRUIT RÀFOLS, S.L
Longitudinal 9, nº 141, Mercabarna. 08040 Barcelona (Spain)
+34 935 56 28 30
Yearly Turnover: 33.100.000 €
Main Product: Fragaria (berries), Mantiana (apples), Paso Lagarto
CHECKPOINT SYSTEMS Spain
Manager: Mariano Tudela Arcas
+34 937 45 48 00
Yearly Turnover: 29.539.000 €
Main Product: Manual labelling.
IBERFLUID INSTRUMENTS S.A.

Manager: Aleix Bargans Masana (Barcelona, Spain)
+34 933 33 36 00
Yearly Turnover: 24.750.481 €
Main Product: Measuring systems.
TALLERES DAUMAR S.L.

Manager: José Peralta
+34 937 53 76 25
Yearly Turnover: 21.975.637 €
Main Product: Packaging machinery
FRUTAS ESCANDELL S.A.

Manager: Vicente Escandell Lucas
4011, 4012, 4013. 08040 Barcelona (Spain)
+34 933 35 31 91
Yearly Turnover: 15.736.758 €
Main Product: Wholesaler.
GRANERO CATALUÑA S.L.
Manager: Eugenio Valera
08040 Barcelona (Spain) +34 935 56 24 58
Yearly Turnover: 13.193.040 €
PROGRESMAMI S. L
Manager: Jordi Valle Carrer de Lluís Puigjaner, 81. Planta 2, puerta 1. 08640 Olesa de Montserrat (Barcelona, Spain)
+34 930 25 01 02
Yearly Turnover: 8.500.000 €
CALVET FRUITS S.L.

Manager: Narcís Calvet
08040 Barcelona (Spain)
+34 933 36 34 09
Yearly Turnover: 8.000.000 €
Main Product: Fruits and vegetables.
FRUITS SOLANAS S.L.
Manager: Baltasar Javier Solanas Gelonch
08040 Barcelona (Spain)
+34 933 35 28 90
Yearly Turnover: 7.800.000 €
Main Product: Grape, pomegranate, tomato and artichoke.
SERVIFRUIT GOMAB S.L


+34 932 62 63 54
Yearly Turnover: 7.310.000 €
Main Product: Fruits and vegetables.
KENOGARD, S.A.
Manager: José María Santorio
+34 934 88 12 70
Yearly Turnover: 6.136.028 €


















Main Product: Crop protection products (phytosanitaries).
ACUAFRUIT S.L.
+34 935 56 25 78
Yearly Turnover: 6.000.000 €
MOSCA DIRECT SPAIN S.L.
(Barcelona, Spain)
+34 934 69 01 23
EXPLATEC S.L.
+34 937 29 12 12
Yearly Turnover: 4.047.982 €
DANMIX S.L.
08440 Cardedeu (Barcelona, Spain)
+34 938 71 11 77
www.danmix.es
Yearly Turnover: 999.517 €
GANDUXER FLORIACH S.A.
Manager: Javier Barulls Bussoms
+34 933 19 66 50
Yearly Turnover: 934.572 €
Main Product: Consume potato and sowing potato.
TASIAS S.A.
Manager: Jaume Guilella Balsells
08787 La Pobla de Claramunt (Barcelona, Spain)
+34 938 08 77 57
Yearly Turnover: 619.984 €
Main Product: Stone picker.
BAYER CROPSCIENCE IBERIA
Manager: Protasio Rodríguez (Barcelona, Spain)
+34 932 28 40 00
www.bayercropscience.es














Main Product: Phytosanitary.

ESTIRIATEAM-KROPFL
Manager: Raúl Roca
na. 08040 Barcelona (Spain)
+34 669 00 68 64
raul@estiriateam.com

Yearly Turnover: 10.000.000 €
Main Product: Apple.
Yearly Turnover: 5.404.780 €
BIOCONSERVACIÓN S.A.
Manager: Gino Ansaldi
+34 936 62 32 54
Yearly Turnover: 5.400.000 €
ZOBERBAC S.L.
08812 Sant Pere de Ribes (Barcelona, Spain)
+34 938 11 54 00
Yearly Turnover: 5.000.000 €
Main Product: Crop protection and crop nutrition.
08040 Barcelona (Spain)
+34 933 36 14 11
Yearly Turnover: 10.000.000 €
BIALCA SOLUTIONS SL
CEO: Guillermo Alcover
Vallés (Barcelona, Spain)
+34 937 459 341 administracion@bialca.com
Main Product: Optical selection machines, weighing machi
CBC IBERIA SAU
Manager: Motosayu Kunitomi
+34 934 44 75 97 www.biogard.es
based on microorganisms and plant substances. COMERCIAL QUÍMICA MASSÓ, S.A.
+34 934 95 25 00 agro@cqm.es
Main Product: Fungicides, insecticides, herbicides and
GENERAL DE ETIQUETAJE, S.A.
+34 935 40 75 40 gesa@generaletiquetaje.com
Main Product: Printers and labels.
GLOBAL QUALITY IBERIA (SABOR DEL AÑO)











Manager: Lluïsa Madrid
+34 934 94 83 80
www.saboresyconsumidores.com

Main Product: Marketing and sales.
HOLLAND INNOVATIONS
Chairman: Ed Westerweele
+34 622 94 39 80
LINDE MATERIAL HANDLING IBÉRICA S.A.
Manager: Jaime Gener Bover
08780 Palleja (Barcelona)
+34 936 63 32 32
repair, automation, intralogistics, consulting, energy systems and

MANVERT
Manager: Enric Bonet
PLANTTAPE
Manager: Bram Stroot
+34 936 37 98 92
Main Product: Transplanting system.
SCHOELLER ALLIBERT, S.A.U.
Manager: Anselmo García Aguarod
+34 938 64 00 80
Main Product: Reusable plastic containers and packaging manu
TORRIBAS S.A.
Manager: Francisco Casamitjana
Longitudinal 5, nº 141. Mercabarna. 08040 Barcelona (Spain)
+34 932 62 69 90
Main Product: Potato.
ENPLATER
Manager: JR Garganta
+34 972 76 15 70
Yearly Turnover: 56.000.000 €
Main Product: Flexible packaging printing.
GIROPOMA COSTA BRAVA S.L.
Manager: Alex Creixell (Girona, Spain)
+34 972 75 50 25
SEMILLAS FITÓ

Main Product: Vegetable seeds.
Yearly Turnover: 29.170.000 €

Main Product: Apples.

PORTES BISBAL S.L.- ÁNGEL MIR
Manager: Ángel Mir
+34 972 64 06 20
Yearly Turnover: 23.000.000
dock shelters, leveling ramps, security systems...)
FRUITS S.C.C.L.
Manager: José María Cornell Pascual
+34 972 49 00 02
Yearly Turnover: 21.000.000 €
Main Product: Apples.
FRUCTÍCOLA EMPORDá S.L.
Manager: Miquel Roig i Heras
17470 Sant Pere Pescador (Girona, Spain)
+34 972 52 00 00
Yearly Turnover: 8.928.335 €
Main Product: Apples.
GRUPALIA 4.0 S.L.
+34 972 83 19 19
Yearly Turnover: 5.000.000 €
BLAUFRUIT / ANELA FRUITS
Manager: Josep María Bosch Farre
Camí de Fornells, 4. 17459 Campllong (Girona, Spain)
+34 972 46 44 24
Yearly Turnover: 806.739 €
Main Product: Pear.
DINOX S.L.
Chairman: Luis Masanas
+34 972 59 40 77
A.T. TROTA S.A.
Manager: Josetxo Martínez
+34 902 20 54 00
Yearly Turnover: 70.000.000 €
GRUPO COOPERATIVO FRUITS DE PONENT

Manager: Josep Presseguer Gené
+34 973 79 57 77
Yearly Turnover: 60.000.000 € and extra virgin oil.
FRUITS SANT MIQUEL S.L.
Manager: Carlos Lozano Jiménez
+34 973 79 74 92
Yearly Turnover: 45.000.000 €
Main Product: Peach and nectarine.
COPA FRESH S.A.
Manager: Antonio María Mas Berenguer
+34 973 60 39 15
Yearly Turnover: 11.058.300 €
Main Product: Pear, peach, nectarine, apple, kaki.
TRECOOP FRUITES SCCL
+34 973 25 82 00
Yearly Turnover: 9.500.000 €
Main Product: Pear, peach and nectarine.
FRUILAR S.A.T. 197
+34 973 76 00 18
Yearly Turnover: 1.504.561 €
Main Product: Peach and nectarine.
AGROQUIMICS LES BORGES S.L.
Joan Maragall, 38.
25400 Les Borges Blanques (Lleida, Spain)
+34 973 14 28 01
www.agroborges.com
agroborges@agroborges.com
Yearly Turnover: 1.450.892 €
Main Product: Agrochemicals.
S.A.T. 4301 EDOA
Chairman: Arcadi Caldero
+34 687 80 40 21
Yearly Turnover: 780.000 €
Main Product: Cherries.
AGRÍCOLA D´ALBATARREC i S.C. S.C.C.L.
Chairman: Juan Carlos Biosca Pastor
+34 973 72 03 01
Main Product: Pears.
MOLNAR FRUITS
Chairman: Eduardo Bruzau Cullere (Lleida, Spain)
+34 973 60 06 69
Main Product: Apples, pears, peaches and nectarines.
SEFRUITS
+34 902 02 68 28
CITRICS TERRES DE L´EBRE SAT
+34 977 10 56 05 www.citricsterresdelebre.com
Yearly Turnover: 12.000.000 €
NUFRI
President: Francisco Argiles Felip
Ctra. Palau, km 1. 25230 Mollerussa (Lleida, Spain)
+34 973 60 02 29
Yearly Turnover: 400.000.000 €
and dates.
ACTELGRUP
Manager: Teresa Teixiné Gené
Ctra. Vall d’Aran, km 3. 25196 Lleida (Spain)
+34 973 70 08 00
Yearly Turnover: 233.549.000 €
supplies and insurance.
GRUPO DOMINGO CATALÀ S.L.
+34 973 18 61 81
Yearly Turnover: 82.000.000 €
Main Product: Apple, pear, cherry, nectarine, peach, plum, kaki,
Manager: Juan Serentín Rubio
Enginyer Pau Agustí, 302. 25191 Lleida (Spain)
+34 973 20 02 50
Yearly Turnover: 8.008.187 €
Main Product: Pears, apples and plums.
LÉRIDA UNIÓN QUÍMICA S.A.
Manager: Jaime Pinyol Farre
+34 973 25 82 56
Yearly Turnover: 6.042.196 €
Main Product: Fertilizers.
ARITMOS
+34 973 18 83 00
Yearly Turnover: 4.500.000 €
CERTIPLANT S.L.

Manager: Francisco Argiles Felip
+34 973 71 14 00
Yearly Turnover: 3.778.991 €
Main Product: Fruit trees (apple, pear, peach and nectarine).
RAMÓN DALFÓ S.A.
Main Product: Citrus.
BIOERA
Manager: Alessandro Marini
43120 Tarragona (Spain) +34 977 52 56 30
Yearly Turnover: 1.500.000 € and rhizobacteria.

VIVEROS GREGAL S.L.
Manager: Miguel Queralt Llagostera
+34 977 73 09 37 plantas@viverosgregal.com
Yearly Turnover: 668.254 €
Main Product: Nursery.
BONNYSA AGROALIMENTARIA
Manager: Jorge Francisco Brotons Campillo
+34 965 65 37 00
Yearly Turnover: 80.000.000 €
SMURFIT KAPPA IBEROAMERICANA S.A.
Ctra. Agost, km 1, Ptda. Canastell B, 393. 03690 Sant Vicent del Raspeig (Alicante, Spain)
+34 965 66 02 00
Yearly Turnover: 79.329.000 €
Main Product: Packaging.
PERALES Y FERRER
Manager: Joaquín Perales Pérez
+34 965 35 01 00
Yearly Turnover: 75.000.000 €
Main Product: Lemon.
SURINVER EL GRUPO S.COOP.

03190 Pilar de la Horadada (Alicante, Spain)
+34 966 76 60 68
Yearly Turnover: 69.702.600 €
Main Product: Pepper, watermelon, corn, butternut, lettuce and celery.
ITC PACKAGING
+34 966 55 40 56
Yearly Turnover: 66.200.000 €
Main Product: Packaging.
VEGABAJA PACKAGING S.L.
Manager: Manuel Peral
+34 966 71 11 42
Yearly Turnover: 55.000.000 €
Main Product: Packaging.
PATATAS BELTRÁN
Ctra. Rojales a San Fulgencio km 7,1.
+34 966 71 33 97
Yearly Turnover: 40.000.000 €
Main Product: Potato.
S.A.T. 9888 IMPERIO
Manager: Francisco Vicente Mira Costa
+34 965 35 66 21
Yearly Turnover: 30.000.000 €
Main Product: Garlic and onions.
A. TERESA HERMANOS S.A.
Chairman: Renan de Teresa
+34 902 47 27 27
Yearly Turnover: 26.000.000 €
S.A.T. Nº 9890 OLÉ


+34 965 36 70 00
Yearly Turnover: 10.300.000 €
Main Product: Artichoke.
ALICHAMPI
Commercial Manager: Juan Bonet

03006 Alicante (Spain)
+34 965 10 49 77
alichampi.com
Yearly Turnover: 10.195.284 €
Main Product: Fruits and vegetables wholesaler.


ECO-LLEVANT SL
UVASDOCE S.L. (Alicante, Spain)

+34 965 62 01 25
Yearly Turnover: 20.000.000 €
Main Product: Grapes.
FRANCISCO OLIVA S.L.
Manager: Francisco Oliva Clemente
03290 Elche (Alicante, Spain)
+34 965 45 32 76
Yearly Turnover: 16.589.067 €
Main Product: Squash, pepper, pomegranate, aubergine, citrus
VILMORIN-MIKADO IBÉRICA S.A.
+34 965 92 76 48
Yearly Turnover: 14.178.000 €
Main Product: Vegetable seeds (carrot, lettuce, pepper, tomato,

+34 965 89 58 15
administracion@ecollevant.es


Yearly Turnover: 8.340.288 €
ATLÁNTICA AGRÍCOLA S.A.
03400 Villena (Alicante, Spain)
+34 965 80 03 58
Yearly Turnover: 38.265.047 €
Main Product: Biostimulants, botanical extracts and microorganisms.


AMEFRUITS, S.L.

Bigastro (Alicante, Spain)
+34 966 74 03 93
Yearly Turnover: 35.000.000 €
Main Product: Garlic, black garlic, peeled garlic, garlic paste and citrus.
CAMBAYAS COOP. V.
Manager: Susi Bonet
Pda. Baya Baja, 2, nº 40. 03292 Elche (Alicante, Spain)
+34 966 63 74 88
Yearly Turnover: 14.000.000 €
Main Product: Pomegranates.
CATA FRESH, S.L.
Manager: Emilio Teresa Almenara
(Alicante, Spain) +34 966 74 79 02
Yearly Turnover: 14.000.000 €
CATMAN FRESH, S.A.
Manager: Sergio Orobal Juanes
+34 966 74 79 02
Yearly Turnover: 13.000.000 €
MULTISCAN TECHNOLOGIES S.L.
Marketing & Sales Manager: Jordi Molines
+34 965 33 18 31
Yearly Turnover: 12.000.000 €
INDESLA PACKAGING, S.L.

Manager: Alessandro Putin
+34 965 81 11 36
Yearly Turnover: 7.000.000 €
ANTONIO BERNÁ E HIJOS, S.L.
+34 965 62 01 61
Yearly Turnover: 4.885.000 €
Main Product: Grapes.
POLIEX S.L.
+34 966 56 05 04
www.poliex.es

Yearly Turnover: 4.526.236 €
GRUPO BETISAN
+34 965 60 18 20
Yearly Turnover: 1.825.947 €
Main Product: Grapes.
J.M. LOS FRUTALES S.A.
03400 Villena (Alicante, Spain)
+34 965 34 60 81
Yearly Turnover: 763.664 €
Main Product: Apple and pear.
CERTIS BELCHIM BV


Country Manager: Francisco Torres (Alicante, Spain)
Main Product: Phytosanitary.
SAT Nº 3502 NOALY

Chairman: Luis Alted Álvarez
+34 965 60 12 80
Main Product: Grape.
GRUPO LLUSAR-TORRES
Manager: Xavi Nolla
+34 962 61 00 16
Yearly Turnover: 123.510.000 €
Main Product: Orange and tangerine.
FRUTÍNTER S.L
+34 964 50 63 10
Yearly Turnover: 113.947.901 €
Main Product: Tangerine, orange, melon, watermelon,
GARCÍA BALLESTER, S.L.
Manager: Jorge García Vicent
+34 964 57 10 25
Yearly Turnover: 80.000.000 €
Main Product: Citrus.
SERIFRUIT SAT Nº 138 CV


Manager: Vicente José Serisuelo Torres
+34 964 62 30 18
Yearly Turnover: 60.000.000 €
MARTÍNAVARRO S.A.
Chairman: Joaquín Ballester Agut
+34 961 74 27 00
Yearly Turnover: 14.236.744 €
CAMPOS DE ALCALÁ S.L. +34
Yearly Turnover: 9.000.000 €
Product: Citrus.
BLASCO FRUIT
Yearly Turnover: 4.495.186 € Main Product: Kaki.

AGROQUÍMICA CODIAGRO, S.L. +34 964 28 01 26
Yearly Turnover: 123.433.000 €
Main Product: Packaging.
VERDIFRESH, S.L.U.
46394 Ribaroja de Túria (Valencia, Spain)
+34 961 66 70 34
Yearly Turnover: 106.100.000 € vegetables.
BOLLO INTERNATIONAL FRUITS S.L.

Manager: José Vercher (Valencia, Spain)
+34 962 81 04 76
Yearly Turnover: 89.364.682 €
Main Product: Citrus and melon.
NUNHEMS SPAIN SAU
46980 Paterna (Valencia, Spain) www.nunhems.es

Yearly Turnover: 58.849.918 €
Main Product: Vegetable seeds (artichoke, carrot, cucumber, leek, lettuce, melon, onion, pepper, spinach, industrial tomato and watermelon).
ANECOOP S.COOP

Sales Manager: Miguel Abril

+34 963 93 85 00
Yearly Turnover: 790.296.000 €
granate, grapes and pumpkin) and vegetables.
SIPCAM IBERIA, S.L.



46009 Valencia (Spain)
+34 963 48 35 00
Yearly Turnover: 57.000.000 €
Main Product: Crop protection and bioestimulants.





ALBENFRUIT S.L.U.
Manager: Ricardo L. Camarasa Blasco
+34 962 48 12 63
Yearly Turnover: 52.000.000 €
Main Product: Tangerine and orange.
COOP. AGRÍCOLA SAN ISIDRO DE BENICARLÓ (BENIHORT)
Manager: Guillermo Edo Barreda
+34 964 47 04 50
Yearly Turnover: 49.905.646 €
+34 964 57 71 30
Yearly Turnover: 16.097.561 €




Main Product: Citrus, orange juice and vegetables.
SANLUCAR
Owner and Founder: Stephan Rötzer
+34 961 42 40 40
Yearly Turnover: 681.000.000 €
Main Product: Berries, strawberries, citrus, grapes, tomato
HINOJOSA
+34 962 28 91 70
www.grupohinojosa.com
Yearly Turnover: 430.000.000 €
Main Product: Containers and packaging.
FONTESTAD S.A.
Manager: Batiste Eixarch Castillo
+34 961 45 06 55
Yearly Turnover: 155.000.000 €
CARTONAJES UNIÓN S.L.
Manager: Gerardo Piris
+34 962 84 03 50
COOP. AGRÍCOLA SANT BERNAT COOP.V
Ctra. Cruz Negra 27. 46240 Carlet (Valencia, Spain)
+34 962 53 90 00
Yearly Turnover: 44.500.000 €
COOPERATIVA AGRÍCOLA NTRA. SRA. DEL ORETO (CANSO)
(Valencia, Spain)
+34 962 54 05 66
Yearly Turnover: 41.000.000 €
46340 Requena (Valencia, Spain)
+34 962 32 36 08
Yearly Turnover: 40.000.000 € Main Product: Onion and garlic.
PROJAR
+34 961 59 74 80
Yearly Turnover: 40.000.000 €
SEIPASA
Manager: Pedro Peleato (Valencia, Spain)
+34 962 54 11 63
Yearly Turnover: 33.000.000 €
dient, guarantees its conservation capacity and provides very high
CEBOLLAS CONSUAY S.L.
Manager: José Manuel Cervera Belenguer
46185 La Pobla de Vallbona (Valencia, Spain)
Yearly Turnover: 32.000.000 €
Main Product: Onion.
RAMAFRUT S.L.
Manager: Gonzalo Trenor
Yearly Turnover: 32.000.000 € and vegetables.
AGROQUÍMICOS DEL LEVANTE S.A.

Manager: Antonio Carrera Arenas
+34 962 51 10 00
Yearly Turnover: 30.000.000 €
PATATAS AGUILAR
Manager: Vicente Aguilar Montoro
+34 961 66 70 28
Yearly Turnover: 27.008.148 € Main Product: Potato. PRODUCTOS
Yearly Turnover: 26.000.000 € technology, etc.).
ENRIQUE ROMAY
Manager: Enrique Romay
+34 961 78 83 20
Yearly Turnover: 24.000.000 €
Main Product: Onions and citrus.
HNOS. APARICI ROSA S.L.
Manager: Fernando Aparici Rosa
+34 961 78 10 86
Yearly Turnover: 23.500.000 €
Main Product: Yellow, red, white and sweet onions.
SERVALESA
CEO: Frédéric Moreau (Valencia, Spain)

+34 962 69 10 90
Yearly Turnover: 18.792.000 €
GRUPO TOLLUPOL
Manager: Alberto Bruna Pérez
+34 962 61 03 00
Yearly Turnover: 18.456.346 € Main Product: Citrus.

HISPALCO S.A.
(Valencia, Spain)
+34 963 40 44 22
Yearly Turnover: 18.000.000 € lon, avocado, kakis, cherimoyas, pomegranates, mangoes, pinea
IBEROCEBOLLAS, S.L.
Manager: Vicente Martí Fontestad
Yearly Turnover: 12.000.000 €
LIDA PLANT RESEARCH S.L. Manager: Ricardo Villuendas

+34 961 76 70 33
Yearly Turnover: 12.000.000 € Main Product: Bioestimulants and phytovaccines.
OBEIKAN MDF Spain S.L.U. Manager: Salvador Martínez
+34 962 66 91 92
Yearly Turnover: 12.000.000 € added value).
GREEN BOX S.L.
QUID PRO QUO FRUITS S.L.
Manager: Jordi Xavier Motilla Vercher
Passeig República de Malta 3, baix 7. 46760 Tavernes de la Valldigna (Valencia, Spain)
+34 962 04 26 66
Yearly Turnover: 17.326.204 €
Main Product: Citrus, kaki, vegetables, exotics.
IDAI NATURE S.L.
Manager: Carlos Alberto Ledo Orriach
(Valencia, Spain)
+34 964 10 48 58
Yearly Turnover: 16.800.000 €
AGRIOS SELECTOS S.L.
Avenida de Xativa, 38. 46727 Real de Gandía (Valencia, Spain)
+34 962 86 80 00
Yearly Turnover: 14.036.235 €
Main Product: Clementines, oranges, lemon and cherry.
PEIRÓ CAMARÓ S.L.
+34 962 44 83 26
Yearly Turnover: 14.000.000 €
Main Product: Orange and tangerine.
VICENTE PERIS S.A
+34 961 49 11 06
Yearly Turnover: 13.000.000 €
Main Product: Melon, watermelon, pumpkin, green onions,
AJOS MASALMAR S.L.
Manager: Salvador Castellano Ros
+34 962 92 21 69 masalmar@masalmar.com
Yearly Turnover: 12.994.000 €
Main Product: Garlic and onion.
EXQUISITE FRUITS S.L.
Plaza del Prado, 21 Gandía (Valencia, Spain)
+34 960 65 39 09
Yearly Turnover: 12.000.000 €
+34 961 24 01 18
Yearly Turnover: 11.125.733 € Main Product: Packaging.
ETIQUETAS Y GRÁFICAS S.L. (ETYGRAF)

Manager: Jorge Baldoví Arnau de Villanova, 4. 46410 Sueca (Valencia, Spain)
+34 961 70 17 60
Yearly Turnover: 9.000.000 € Main Product: Label converter.
CONVITE S.A.
Manager: Guillermo Pérez Bernabéu
+34 962 85 01 62 ventas@convite.com
Yearly Turnover: 8.036.573 € Main Product: Orange, clementine and tangerine.
AGRO MARKETING COOL FRESH Spain S.L.

46015 Valencia (Spain)
+34 963 49 57 28
Yearly Turnover: 7.800.000 €
SANSAN PRODESING S.L. (Valencia, Spain)
+34 963 90 05 51
Yearly Turnover: 6.300.000 € Main Product: Plant pot, mosquito net, boxes.
JUAN OLASO S.A.
+34 902 20 20 19
Yearly Turnover: 5.396.746 €
ROVIRA AGRÍCOLA S.L.
Manager: Arcadio Rovira Andreu
+34 961 78 00 00
Yearly Turnover: 5.348.891 €
Main Product: Onion.
RICARDO PERALES E HIJOS S.L.
Manager: Ricardo Perales Garrigos
+34 962 22 41 92
Yearly Turnover: 5.245.371 €

Main Product: Onions.
INTERSEMILLAS S.A.
Manager: Santiago Pérez Giner
46393 Loriguilla (Valencia, Spain)
+34 961 64 01 01
Yearly Turnover: 5.000.000 €
Main Product: Watermelon, melon, pepper, tomato, cucum ber, onion, courgette and eggplants.
IBERO VERDURAS S.L.
(Valencia, Spain) administracion@iberoverduras.com




Yearly Turnover: 4.526.110 €
Main Product: Vegetables.
GREGAL SOLUCIONES INFORMÁTICAS SL
+34 963 05 23 08
Yearly Turnover: 3.000.000 €
VisionAgency, VisionCrop, VisionSeed, VisionLabor, VisionCredit

SANIFRUIT
Manager: Javier Biel
(Valencia, Spain)
+34 962 52 18 14
Yearly Turnover: 3.000.000 €
GRUPOTEC INSPECCIÓN Y MEDIOAMBIENTE S.L.
Manager: Juan Cardona Esbri
+34 963 39 18 90
Yearly Turnover: 2.921.860 €
BIOESTIMULANTES AGRÍCOLAS S.L.
Manager: Ana Cristina Morales Melian
+34 961 41 70 69
Yearly Turnover: 2.342.325 €
Main Product: Agricultural biostimulants.
CEBOLLAS ILUSTRA S.L.
Manager: Francisco Javier Pellicer
+34 963 78 08 59 javier@cebollasilustra.com
Yearly Turnover: 2.101.687 €
Main Product: Onion.
ISAGRI
+34 902 17 05 70
Yearly Turnover: 1.898.610 €
LASER FOOD 2007 S.L.
+34 961 11 85 90
Yearly Turnover: 900.000 €
FRUTEXA S.L.
+34 962 45 31 30
Yearly Turnover: 889.708 €
Main Product: Onions, citrus, vegetables and potatoes.
TERRA SANA COOP. V.
Chairman: Carles García Pons
Ronda Nord 5. 46540 El Puig (Valencia, Spain)
+34 961 47 92 87
Yearly Turnover: 500.000 €
Main Product: Ecological.
PATATAS HZPC Spain S.L.
Manager: Hermanus Verveld
Avda. Santa Apolonia, 39. 46901 Torrent (Valencia, Spain)
+34 961 58 95 51 espana@hzpc.com
Yearly Turnover: 355.665 €




Main Product: Potato varieties.
COMPAÑÍA DE VARIEDADES VEGETALES PROTEGIDAS A.I.E.
Center. 46015 Valencia (Spain)
+34 960 61 93 35
DECCO IBÉRICA Post Cosecha, S.A.U
Manager: Miguel Sanchís Alcami (Valencia, Spain)
+34 961 34 40 11
des, zero residue products, coatings, edible coatings, application equipment and all the service and support needed: mechanical and technical assistance.
EDYPRO
CEO: Vicente Puchol
+34 961 49 60 85
FEDEMCO / GROW
Chairman: Enrique Soler Segrelles
+34 963 49 57 13
Main Product: Wooden crates and packaging.
GESVATEC SISTEMAS S.L.
ZERYA PRODUCCIONES SIN RESIDUOS S.L.

Manager: Javier Arizmendi Ruiz
46007 Valencia (Spain) +34 960 09 87 92
Yearly Turnover: 150.000 €
Río Pisuerga, 6. 46011 Valencia (Spain)
+34 963 39 18 90
GESVATEC©.
AGRISEEDS IBÉRICA S.L.
Avda. Cortes Valencianas, 28, 1ºB. 46015 Valencia (Spain)
+34 961 20 43 42
Main Product: Hybrid onion seeds.

AGROFRESH EXPORT CONSORTIUM

46025 Valencia (Spain) +34 963 91 15 91
AGROFRESH FRUIT PROTECTION, S.A.

46988 Paterna (Valencia, Spain)
+34 961 32 34 15
AGROFRESH SPAIN S.L.U.

+34 961 32 34 15
Main Product: SmartFresh, Freshcloud technologies, VitaFresh
GRUPO CAÑAMAS
Sales Manager: Ángel Verdú Pellicer
+34 962 85 20 00
Main Product: Citrus and kaki.
HORFRUMED S.L.
+34 962 66 63 85
Main Product: Agricultural machinery.
IBERIANA FRUCHT S.A.
Manager: Enrique Clavel Rubio, Carmen Folgado, Nicolas Groot (Valencia, Spain)
+34 961 45 20 30
Main Product: Fruits and vegetables.
IFCO SYSTEM SPAIN S.L.


CEO: Lucía Aragonés
46220 Picassent (Valencia, Spain)
+34 961 24 18 00
Main Product: Reusable Plastic Containers (RPC).
MAF RODA, S.L.
Manager: Christophe Blanc Avda. de la Llibertat, 53. 46600 Alzira (Valencia, Spain)
+34 962 40 30 11
MEDITERRANEAN SHIPPING COMPANY ESPAÑA S.L.U.
Main Product: Shipping and logistics services.
ORRI RUNNING COMMITTEE
Manager: Guillermo Soler Fayos
Avda. Cortes Valencianas, 26, bloque 5, escalera 2, piso 2º, +34 961 24 97 80 orc@orcspain.es



Main Product: Orri mandarine.
PACKCO, BRAND AND PACKAGING, S.L.


Manager: José Navarro
Puebla de Farnals (Valencia, Spain)
+34 629 66 02 52
packaging and brands.
SAKATA IBÉRICA
Manager: Javier Bernabéu Pl. Poeta Vicente Gaos, 6 bajo. 46021 Valencia (Spain)
+34 963 56 34 27
Main Product: Vegetable seeds.
SUTERRA EUROPE BIOCONTROL SL Plaza América 2, 9º. 46004 Valencia (Spain)


+34 96 395 67 43
VALGENETICS S.L.

Manager: Maria R. Albiach Martí
Agustín Escardino, 9. 46980 Paterna (Valencia, Spain)
+34 960 05 91 46
diagnosis, plant microbiology, in vitro culture, plant genetics
VIVEROS HERNANDORENA S.L.
Manager: Fernando Hernandorena Ribes
+34 962 53 26 81
and karob.
YUMMY FRESH S.L.
Avda. Cortes Valencianas 28, 1ºB. 46015 Valencia (Spain)
+34 961 20 43 40
Main Product: Sweet onion, winter squash and melons.
ACOPAEX SDAD.COOP

Manager: Juan Francisco Blanco Cortés
+34 924 37 24 11
Yearly Turnover: 90.000.000 €
TANY NATURE

CEO: Atanasio Naranjo Hidalgo
General Manager: Pedro Serrano Palacios
+34 924 85 60 96
Yearly Turnover: 82.000.000 €
SOL DE BADAJOZ / FARM FRUIT


Ctra. Nacional 430, km 116. 06720 Valdivia (Badajoz, Spain)
+34 924 83 30 08
www.gruposolbadajoz.com
soldebadajoz@solbadajoz.com
Yearly Turnover: 50.000.000 € and pomegranate.
LAND FRUIT

+34 924 80 06 00
Yearly Turnover: 32.000.000 € cucumber.



COOP.
06207 Aceuchal (Badajoz, Spain)
+34 628 71 70 99
www.coajosaceuchal.com
gerencia@coajosaceuchal.es
Yearly Turnover: 8.500.000 €
Main Product: Fresh garlic, garlic paste and peeled garlic clove.


FARM FRUIT S.L.
Manager: Manuel Rosa Meda
(Badajoz, Spain)
+34 924 84 96 56
Yearly Turnover: 7.352.545 €
Main Product: Cherry, plum, peach, nectarine, paraguayas.
FRUVAYGO S.L.
Apdo. 20075. 06080 Badajoz (Spain)
+34 924 43 03 06
Yearly Turnover: 5.544.659 €
Main Product: Peach, pear, plum, nectarine.
EXPLUM SDAD. COOP.
Manager: José Aurelio García Cuevas
+34 924 44 63 38
Yearly Turnover: 5.372.161 €



PIDUVAL IBERPACKING S.L.
Avda. Extremadura, 114. 06140 Talavera La Real (Badajoz, Spain) +34 924 44 02 79

Yearly Turnover: 4.101.441 €
Main Product: Packaging.
FRUMAEX S.L.
Yearly Turnover: 3.000.000 €
SEYCROS S.L.
+34 924 14 51 45
Yearly Turnover: 2.382.195 € Main Product: Summer Fruits (Nectarine, plum, peach...).

EXVEAL S.L.
Manager: Pedro Mansilla Parra
+34 924 82 28 56 exveal@gmail.com
Yearly Turnover: 1.963.412 € Main Product: Peach, nectarine, plum and pear.



NOVAFRUTA DEL GUADIANA S.A.
+34 924 80 80 42
Yearly Turnover: 1.574.812 €
SOC. COOP. FRUTAS DEL GUADIANA


Chairman: Miguel Romero Burgos
+34 924 45 75 15
Yearly Turnover: 1.214.151 €
Main Product: Peach, nectarine, plum, pear.
HACIENDASBIO
CEO: Jordi Faine
06800 Mérida (Badajoz, Spain)
+34 924 09 70 00
AGRUPACIÓN DE COOPERATIVAS DEL VALLE JERTE
+34 927 47 10 70
Yearly Turnover: 65.000.000 €
Main Product: Cherries.
CAMPO Y TIERRA DEL JERTE
+34 927 40 43 83
Yearly Turnover: 20.000.000 €
Main Product: Cherries, organic asparagus, plums, chesnuts, apri
GRUPO ALBA INT.
+34 927 42 70 54
Yearly Turnover: 12.520.850 €
Main Product: Picota del Jerte, cherry and chesnut.
SOCIEDAD COOPERATIVA DEL CAMPO DE NAVACONCEJO
+34 927 17 31 68 www.cerezasdenavaconcejo.es gerente@cerezasdenavaconcejo.es
Yearly Turnover: 6.000.000 €
Main Product: Cherry and chestnut.
ONE NATURE FRUITS S.L.

Manager: Raúl Cuadrado
+34 652 82 95 58
Yearly Turnover: 5.000.000 €
REGADHIGOS, S.C.L.
Manager: Manuel Collado
+34 927 38 63 77
Yearly Turnover: 3.000.000 €
Main Product: Figs, tomato, corn and olives.
DELEITE GRANA S.L.
Manager: Jesús Martín Fraile
+34 927 47 25 64
Yearly Turnover: 1.291.612 €
Main Product: Cherry.
S.A.T. BIOSPHERA
+34 924 34 27 42
CUBICAJE S.L.
Manager: Vicente Torres Pastoriza
Pol. Ind. Bergondo. Parroquia Guisamo, Parc. A9-1. 1 5165 Bergondo (La Coruña, Spain) +34 902 10 64 45
www.cubicaje.com / info@cubicaje.com
Yearly Turnover: 3.087.718 €
Main Product: Packaging.
KIWIS DEL BARBANZA S.A.
Manager: José Ramón González Boo
Punta Saleira, 25. 15940 A Pobra do Caramiñal (La Coruña, Spain) +34 981 83 01 74 comercial@ramonfranco.com
Main Product: Kiwi.
HORTÍCOLAS GALEGAS S.L.
Manager: José Domingo Rivero Salgado Campo de Couso s/n. Xinzo de Lima (Orense, Spain) +34 988 46 24 51 www.horticolasgalegas.es / horticolas@horticolasgalegas.es
Yearly Turnover: 10.141.574 €
Main Product: Vegetables and fruits.
PATATAS CONDE S.L.
Manager: Diego Conde
Ctra. Nacional 525, km 200. 32630 Xinzo de Limia (Orense, Spain) +34 988 46 24 77
www.patatasconde.com / calidad@patatasconde.com

Yearly Turnover: 9.928.211 €
Main Product: Potato.
KIWI ATLÁNTICO S.A.
Manager: José Carlos Vila
Costas Lois - Portaris s/n. 36635 Ribadumia (Pontevedra, Spain) +34 986 71 52 86
www.kiwiatlantico.com / comunicacion@kiwiatlantico.com
Yearly Turnover: 26.587.078 €
Main Product: Kiwi.
HORSAL, SCG
Manager: Fernando Veiga
LG O Pardiño, 10B - Vilariño. 36633 Cambados (Pontevedra, Spain) +34 986 54 21 95
www.horsalscg.com / horsal@horsalscg.com
Yearly Turnover: 5.000.000 €
Main Product: Vegetables.
FRUTAS SERAFÍN
Manager: Serafín Álvarez Casal
Parque Empresarial de Areas, Parcela 22. 36711 Tui (Pontevedra, Spain)
+34 986 60 72 32
www.frutasserafin.com / correo@frutasserafin.com
Yearly Turnover: 1.334.914 €
Main Product: Kiwi, strawberry, lettuce, tomato, cucumber, zucchini, eggplant...
H2HYDROPONICS, SPAIN
Manager: Rafa Pereira
Rua das Pontes, 4. OFF 225. 36350 Nigran (Pontevedra, Spain)
+34 986 36 40 62 info@h2hydroponics.com
Main Product: H2HYBRID (proprietary).
TC GROUP ATLÁNTICO S.L.
Manager: Cristóbal Monteagudo
Pol. Ind. Outeda - Curro Par. A-02. 36692 Barro (Pontevedra, Spain)
+34 902 00 69 75
www.tcfruits.com / comercial@tcfruits.com

Main Product: Fruits (citrus, stone fruits, strawberry, watermelon, mango, melon and cherry) and vegetables.
AGROILLA S.A.T.
Manager: José Mestre
C/ Cardenal Rossell, s/n. Mercapalma. 07007 Palma (Baleares, Spain)
+34 971 26 40 15 www.agroilla.com / jmestre@agroilla.com
Yearly Turnover: 11.887.431 €
Main Product: Tomato, strawberries of Manacor.
VIUDA DE ANTONIO SERRA, S.A.
Manager: Juan Serra Serra
Pol. Ind. ‘Sa Vileta’. Ctra. Sa Pobla - Muro, Km 1,2. 07420 Sa Pobla (Palma, Spain) +34 971 54 01 00 www.viudaserra.com / comercial@viudaserra.com
Yearly Turnover: 7.007.729 €
Main Product: Potato.
S.A.T. Nº 429/06 PLATANEROS DE CANARIAS
Manager: Juan Carlos Santiago Cubas Lomo de Guillén, 3. Residencial Las Huertas, 2º piso. 35450 Santa María de Guía (Las Palmas, Spain) +34 928 88 15 50 contacto@platanerosdecanarias.com
Yearly Turnover: 49.199.520 €
Main Product: Plátano.
SAT JULIANO BONNY GÓMEZ Nº 9592
Manager: Antonio Bonny Miranda
C/ La Naval (Cl Juan Rejon, 89 - Apdo 2145), 138. 35008 Las Palmas de Gran Canaria (Las Palmas, Spain) +34 928 30 32 00 www.bonny.es / exportacion@bonny.es
Yearly Turnover: 44.125.073 €
Main Product: Cucumber, tomato and blueberries.
AGRICOLA DEL NORTE DE GRAN CANARIA S.C.L
Manager: Ricardo Díaz Suárez Camino de la Batería, 23. 35414 Arucas (Las Palmas, Spain) +34 928 62 69 44 www.agricoladelnorte.es / nortegc@infonegocio.com
Yearly Turnover: 13.000.000 €
Main Product: Plátano.
CANARIHORTA, S.L.
Manager: Antonio Carmelo Dominguez Navarro C/ Trasera de Ángel Guimerá s/n. 35200 Telde (Las Palmas, Spain) +34 928 71 07 17 canarihorta@telefonica.net
Yearly Turnover: 4.000.000 €
Main Product: Convenience food.
FRESH TOM EXPORT, S.L.
Manager: Ismael López Falcón
C/ Ángel Guimera, 3. 35259 Ingenio (Las Palmas, Spain) ilopezfalcon@gmail.com
Yearly Turnover: 3.000.000 €
Main Product: Cherry pear tomato, Kumato cherry pear tomato, yellow cherry pear tomato, cherry tomato on the vine, round tomato.
COPLACA
Manager: Javier González Palenzuela Avda. Anaga, 11, planta 04. 38001 Santa Cruz de Tenerife (Spain) +34 922 28 63 00 www.coplaca.org / info@coplaca.org
Yearly Turnover: 140.000.000 €
Main Product: Plátano.
GRUPO EUROPLÁTANO
Manager: Antonio Javier Luis Brito Camino Palomares, 118. 38760 Los Llanos de Aridane. La Palma (Santa Cruz de Tenerife, Spain) +34 922 40 10 83 www.europlatano.es / info@europlatano.net
Yearly Turnover: 68.938.799 €
Main Product: Plátano, avocado, pineapple and papaya.
COOPERATIVA UNIDA DE LA PALMA
Chairman: Raúl Martín Urb. Urbal, Los Guinchos, nº 64. 38712 Breña Baja. La Palma (Santa Cruz de Tenerife, Spain)
+34 922 43 48 81 www.cupalma.com / administracion@cupalma.com
Yearly Turnover: 60.000.000 €
Main Product: Plátano.
S.A.T. AGRITEN
Chairman: María Del Carmen González Avda. Francisco de la Roche, 31, 2º. 38001 Santa Cruz de Tenerife (Spain) +34 922 53 22 20 oficina@satagriten.com
Yearly Turnover: 36.000.000 €
Main Product: Plátano.
SOCIEDAD AGRARIA DE TRANSFORMACIÓN FAST (S.A.T. FAST)
Chairman: Melchor Bravo de Laguna Ctra. General Las Arenas, 2 (La Vera). 38300 Villa de la Orotava (Tenerife, Spain) +34 922 38 15 74 www.lafast.org / gerente@lafast.org
Yearly Turnover: 34.000.000 €
Main Product: Plátano and avocado.
ALMACENES RUBIO S.A
Manager: Eduardo Rubio Olarte Avda. Torrecilla, 40 Apdo. 13. 26250 Santo Domingo de la Calzada (La Rioja, Spain) +34 941 34 10 91 www.almacenesrubio.com / rubio@almacenesrubio.com
Yearly Turnover: 23.892.531 €
Main Product: Potato.
COOP. FRUTOS DEL CAMPO
Chairman: José Antonio Jiménez Breton Avda. Gonzalo de Ver, CEO, 81. 26559 Aldeanueva del Ebro (La Rioja, Spain) +34 941 14 23 26
www.kumix.es / comercial@frutosdelcampo.es
Yearly Turnover: 4.494.860 €
Main Product: Pear and stone fruits, bio pear, bio apples, artichokes.
FRUTAS PISÓN S.L.
Manager: Pelayo Pisón Campo
Camino Tanerias s/n. 26143 Murillo de Río Leza (La Rioja, Spain) +34 941 43 21 04
www.frutaspison.com / frutas.pison@fer.es
Yearly Turnover: 1.942.292 €
Main Product: Pear.
FRUTAS ESCALADA S.L.
Manager: Roberto Escalada Sáenz Camporredondo Avda. de la Rioja, 70. 26550 Rincón de Soto (La Rioja, Spain) +34 941 16 01 80
www.frutasescalada.com / info@frutasescalada.com
Yearly Turnover: 1.694.874 €
Main Product: Pear and apple.
VIVEROS PROVEDO S.A.
Manager: Francisco Javier Provedo Eguia
Barrio Varea s/n. Finca el Raso. 26006 Logroño (La Rioja, Spain) +34 941 27 27 77 www.provedo.com / provedo@provedo.com
Main Product: Stone fruit breeding - New fruits varieties.
SYNGENTA ESPAÑA S.A.U.
+34 913 87 64 10
www.syngenta.es


Yearly Turnover: $ 14,3 bn
Main Product: Crop Protection, seeds.
FERTIBERIA S.A.
28036 Madrid (Spain)
+34 915 86 62 00
Yearly Turnover: 1.500.000.000 €
Main Product: Sustainable specialty crop nutrition solutions and



AM FRESH GROUP
+34 961 80 14 02
Yearly Turnover: 1.400.000.000 €
Main Product: Applied biotechnology, varietal development,

EUROBANAN, S.L.
(Spain)
+34 917 79 66 00 www.eurobanan.com madrid@eurobanan.com


Yearly Turnover: 507.000.000 €
and exotics.
CHEP
planta 5. 28033 Madrid (Spain)
+34 915 57 94 00
Yearly Turnover: 207.572.000 €
FRUTAS E. SÁNCHEZ S.L.
Ctra. Toledo km 17,200. 28946 Fuenlabrada (Madrid, Spain)
+34 917 86 65 76
Yearly Turnover: 130.000.000 €
COMPAGNIE FRUITIÈRE ESPAÑA CORPORACIÓN S.A

Manager: Juan Rodríguez
Mercamadrid. Parc. H.2.9. 28053 Madrid (Spain)
+34 915 07 62 00
Yearly Turnover: 107.590.813 €
HAIFA IBERIA S.L.
Manager: Erik Siemens
+34 915 91 21 38
Yearly Turnover: 85.030.959 €
Main Product: Fertilizers.

ALFALAND S.L.
+34 691 83 93 92
Yearly Turnover: 55.000.000 €
IBÉRICA DE PATATAS SELECTAS, S.L.
Manager: Pablo Jiménez
Ctra. Villaverde a Vallecas, km 3,800. Mercamadrid.
+34 917 85 43 12
www.ibericadepatatas.com
ibericadepatatas@ibericadepatatas.es
Yearly Turnover: 50.000.000 €
Main Product: Potato.
+34 915 079 557
Yearly Turnover: 13.000.000 €
dishes, vegetable drinks and snacks.
S.A.T. HNOS. AGUDO CONTRERAS ‘EL MELONERO’
Manager: Antonio Agudo Contreras
Ctra. Titulcia, 37. 28360 Villaconejos (Madrid, Spain)
+34 918 93 80 81
Yearly Turnover: 12.580.000 €
Main Product: Melon and watermelon.
FRUTAS HERMANOS MONTES S.A.
FRUTAS NIQUI MADRIMPORT S.L.
Ctra. Villaverde a Vallecas, km 3,800. Mercamadrid.

+34 915 07 33 00
Yearly Turnover: 24.000.000 €
Main Product: Apple, orange, asparagus, lemon, kiwi, avoca do, mango and pear.
Beta 8, Mod 29. 28053 Madrid (Spain)
+34 917 85 01 01 www.hermanosmontes.com
montes@hermanosmontes.com
Yearly Turnover: 11.755.000 €
COMERCIO DE PATATAS Y CEBOLLAS S.L.

CENTRIMERCA S.A.
Manager: Raquel Paradela Portillo Ctra. Villaverde a Vallecas. Mercamadrid.
+34 917 85 49 02
Yearly Turnover: 20.000.000 € Main Product: Wholesaler.

RIEGO S.A.
Ctra. Villaverde a Vallecas km 3,800. Mercamadrid. Almacén 5.
+34 917 86 13 14
Yearly Turnover: 15.468.752 €
GARCÍA MATEO & SINOVA S.L.
Manager: Sergio Sinova
+34 913 02 63 01
Yearly Turnover: 14.100.000 €
Main Product: Green asparagus and strawberry.
TRILLA INDUSPLAST IBÉRICA, S.L.U.
Manager: Javier Vicente
+34 918 89 07 00
Yearly Turnover: 14.000.000 €
Main Product: Packaging.
COMFRESH IBERIAN S.L.
Mercamadrid. 28053 Madrid (Spain)
Manager: Vicente Martín Moreno Ctra. Villaverde a Vallecas, km 3,800. Mercamadrid.
Yearly Turnover: 8.361.880 €
Main Product: Potato.
FRUTAS HERMANOS RUIZ GÓMEZ S.L.
Ctra. Villaverde a Vallecas km 3,8. Mercamadrid. Nave F, puestos 38, 40, 42, 44. 28053 Madrid (Spain)
+34 917 86 34 13
Yearly Turnover: 7.537.736 €
Main Product: Wholesaler.
LORENZO IZQUIERDO S.L.
Ctra. Villaverde a Vallecas km 3,800. Mercamadrid. Nave A, puestos 4 y 6. 28053 Madrid (Spain) +34 917 85 28 02
Yearly Turnover: 7.306.646 €
Main Product: Potato.
EUROMERCA S.A. M
18. 28053 Madrid (Spain) grupoeuromerca@grupoeuromerca.com
Yearly Turnover: 5.806.775 €
Main Product: Wholesaler.
VERDURAS MARCAFRUIT S.L.
Manager: Carmen Rodríguez Pérez
Mercamadrid. 28053 Madrid (Spain)
+34 915 07 01 82
Yearly Turnover: 5.679.434 €
Main Product: Runner beans and Padron pepper.
FRUTAS ELOY RUANO S.L.
Manager: Eloy Ruano Gamella
Ctra. Villaverde a Vallecas km 3,800. Mercamadrid. Par. B 9, Plata
+34 917 86 64 90
Yearly Turnover: 5.551.888 €
Main Product: Wholesaler.
GUERRERO MADRID S.L.
Ctra. Villaverde a Vallecas km 3,800. Mercamadrid. Nave 1, puestos
33, 35 y 54. 28053 Madrid (Spain)
+34 917 85 46 00
Yearly Turnover: 4.564.990 €
Main Product: Wholesaler.
FRUTAS JAVIER MARTÍN S.L.

Manager: Javier Martín Pérez
+34 917 85 52 95
Yearly Turnover: 3.420.483 €
Main Product: Fruits and vegetables. EL JARDÍN DE ALMAYATE
+34 917 45 46 20
Yearly Turnover: 3.353.033 €
CAPESPAN IBÉRICA S.A.
Manager: Ángel Rey Rodríguez
Ctra. Villaverde a Vallecas km 3,800. Mercamadrid. Parc. B 3.3.
+34 902 48 50 00 www.eurobanan.com
Yearly Turnover: 2.403.847 €
Main Product: Wholesaler.
CMR INFINITA, S.A.
+34 915 24 50 00
ALGAENERGY S.A.

Avda. de Europa, 19. 28108 Alcobendas (Madrid, Spain)
+34 914 90 20 20
soil health.
FRUTAS OLIVAR S.A.
Manager: Andrés Álvarez
Nave B, puestos 19 al 27. 28053 Madrid (Spain)
+34 917 85 76 85
Main Product: Wholesaler.
GESCOAGRO, S.A.
+34 915 78 21 80
BEJO IBÉRICA, S.L.
Manager: Christiaan Reynders
Calle del Hervidero, 15. 28750 San Agustín del Guadalix (Madrid, Spain)
+34 916 58 70 72
www.bejo.es


Main Product: Vegetable seeds.
Main Product: Pepper, cucumber, aubergine, tomato, berries, sum

NOVAKOR EUROPA, S.L.
+34 918 71 96 35
Main Product: Polyester rope. Low elongation and hight resistance
OXYION EUROPA S.L. Manager: Felipe Jobet Eluchans
28232 Las Rozas (Madrid, Spain)
+34 916 54 58 45
PERDINE S.A.
+34 617 28 86 96 agarces@perdine.com
Main Product: Citrus.
TOSCA (TOSCA NETHERLANDS BV SUCURSAL EN ESPAÑA)
+34 915 07 94 67
Main Product: Folding returnable boxes.
VALGREN S.L. Manager: Noelia Álvarez
+34 927 47 27 26
Main Product: Cherry.

VIVEROS NIHARRA S.L.
+34 915 28 14 75
Main Product: Strawberry plants.
YARA
+34 914 263 500
www.yara.es









Main Product: Fertilizer products in solid, liquid and microelement the most balanced nutrition.


ZESPRI INTERNACIONAL IBÉRICA, S.L.
Madrid (Spain)
+34 915 07 93 68
GRUPO PRIMAFRÍO
Manager: Juan Conesa y José Esteban Conesa (Murcia, Spain)
+34 968 30 91 87
Yearly Turnover: 458.000.000 €
Main Product: Temperature controlled logistics. Specialised in value products.

THE NATURAL FRUIT COMPANY
+34 968 82 01 47
Yearly Turnover: 250.000.000 €
Main Product: Lemon, Sanguinelli orange and melon.
AGRITECHMURCIA


Manager: Sergio Montesinos Fuster
30100 Murcia, Spain
+34 619 260 159
Yearly Turnover: 217.000.000 €
Main Product: Advanced agricultural technology.
GRUPO EL CIRUELO (AGRONATIVA, S.L.
cia, Spain)
+34 968 63 06 45
Yearly Turnover: 205.000.000 € paraguayans, platerinas, plums, apricots, cherries).






AGROMARK

Casa Lugar Nuevo, 65. 30739 Torre Pacheco (Murcia, Spain)
+34 968 17 32 01
Yearly Turnover: 80.000.000 €
CAMPO DE LORCA
+34 968 46 59 60
Yearly Turnover: 80.000.000 € cabbage and Bimi.
FRUTAS ESTHER S.A.
+34 968 77 00 00
Yearly Turnover: 70.000.000 €
PROCOMEL S.L.
Manager: Celedonio Buendía
Paraje Los Ruices, 115.
30156 Los Martínez del Puerto (Murcia, Spain)
+34 968 38 33 39
Yearly Turnover: 67.135.443 €

Main Product: Melon.
G´S SPAIN / PASCUAL MARKETING S.L.


Manager: Guy W. Shropshire Ctra. de El Jimenado, km 1. 30700 Torre Pacheco (Murcia, Spain)



+34 968 18 86 00
Yearly Turnover: 185.000.000 €
radish, spring onions, courgette, watermelon, melon, ready to eat range and organic range.
SOLPLAST S.A.
Apdo. de correos 323. 30817 Lorca (Murcia, Spain)
+34 968 46 13 11 www.solplast.com


Yearly Turnover: 127.862.308 €
AGROMEDITERRÁNEA HORTOFRUTÍCOLA, S.L. (Sun&Vegs)
+34 968 17 30 01
Yearly Turnover: 100.600.000 € (green, white, round), broccoli, sweet corn, radish and pepper. sweet corn and radish).
GRUPO HORTOFRUTÍCOLA PALOMA, S.A.
+34 968 590 001 www.gpaloma.com
Yearly Turnover: 97.635.010 €
JIMBOFRESH

Manager: Miguel Ángel Jiménez Bosque
+34 968 97 23 90
Yearly Turnover: 67.000.000 €
Main Product: Galia Okashi, yellow melon, Lililup, Jimbee melon, Cantaloupe, Charentais, Waikiki, Maui, Jimbee Snack, seedless watermelon, miniwatermelon, Kisy, ice romanesco, pointed cabagge, lollo rosso, lollo biondo, Romaine lettuce.
SOLTIR
Manager: Ángel García
(Murcia, Spain)
+34 968 33 48 00
Yearly Turnover: 62.000.000 € cantaloupe and broccoli.

CÍTRICOS LA PAZ
CEO: Jaime Ortega Navarro
+34 968 43 21 59
Yearly Turnover: 60.000.000 €
GREGAL S. COOP.
+34 968 58 55 56
Yearly Turnover: 60.000.000 €
UNEXPORT, S. COOP

30816 La Hoya de Lorca (Murcia, Spain)
+34 968 48 67 04
Yearly Turnover: 59.000.000 € melons (organic and conventional).


POZO SUR
Apdo. de correos 67. 30880 Águilas (Murcia, Spain)




+34 968 49 32 13
Yearly Turnover: 55.000.000 €
Main Product: Watermelon, iceberg lettuce, mini romaine, baby, pak choi, cucumber, eggplant and pumpkin.
HORTAMIRA S.C.L.
+34 968 17 41 92
Yearly Turnover: 40.000.000 €
Main Product: Pepper, lemon and ecological products.
SAT 97 BLANCASOL
Chairman: Antonio Bernal Martínez
Ctra. Jumilla, km 36. 30540 Blanca (Murcia, Spain)

+34 968 77 61 09
Yearly Turnover: 40.000.000 €
KERNEL EXPORT S.L.
Avda. 13 de Octubre. P.O. Box 88.
+34 968 57 40 25
Yearly Turnover: 38.721.274 €

Main Product: Lettuce, spinach, brassica, baby leaves, convenience
EL LIMONAR DE SANTOMERA SOC. COOP.
Manager: Antonio José Moreno García Ctra. de Abanilla km 2, nº 35. 30140 Santomera (Murcia, Spain)
+34 968 86 00 01
Yearly Turnover: 37.000.000 €
Main Product: Lemon and ecologic citrus.

HOYAMAR S.COOP.
Manager: Antonio Marín Garre
30816 Lorca (Murcia, Spain) +34 968 48 19 19

AGROCAZALLA S.L.
Manager: Juan Marín Bravo
Camino Cartagena, 215. 30815 Lorca (Murcia, Spain)

+34 968 40 66 37
Yearly Turnover: 30.000.000 €
Main Product: Artichoke and broccoli.
DEILOR S.C.A
30850 Totana (Murcia, Spain)
+34 968 41 81 17
Yearly Turnover: 30.000.000 €
kohlrabi, melon (Galia, Cantaloup, Mini Piel de Sapo), watermelon, seedless grapes, little gem, mini romana and celery.
EL DULZE GROWERS, S.L.



+34 968 17 48 04
Yearly Turnover: 50.000.000 €
Main Product: Lettuce, celery, sweet corn and aromatic herbs.
CALICHE
30730 San Javier (Murcia, Spain)
+34 968 32 60 00 administracion@caliche.es
Yearly Turnover: 45.000.000 €
Main Product: Business services (transport).


NOVEDADES AGRÍCOLAS, S.A. (NOVAGRIC)





Avda. de las Naciones, P.7.
30840 Alhama de Murcia (Murcia, Spain)
+34 968 333 088
Yearly Turnover: 44.000.000 €
Main Product: Complete greenhouse and outdoor irrigation projects control, automation, water treatment with support and technical and agronomic advice.
S.A.T. Nº 2.457 SAN CAYETANO
30730 San Javier (Murcia, Spain)
+34 968 58 01 11
Yearly Turnover: 43.000.000 €
Yearly Turnover: 36.000.000 €
Main Product: Broccoli, iceberg lettuce, little gem, romaine lettuce, cabbages, leek, watermelon, curly kale, lollo biondo, lollo rosso,

KETTLE PRODUCE ESPAÑA


Autovía A7, km 605, Las Flotas. 30840 Alhama de Murcia (Murcia, Spain)
+34 968 68 40 18
Yearly Turnover: 30.000.000 €
Main Product: Broccoli, beaked cabbage, kale and green
S.A.T. Nº 1936 AGROTER
Manager: Juan Antonio García (Murcia, Spain)
+34 968 46 57 63
Yearly Turnover: 26.000.000 €
Main Product: Watermelon, artichoke, broccoli, butternut, cauli
S.A.T. Nº 9994 CAMPOSEVEN
Ctra. Lo Romero, 33. 30740 San Pedro del Pinatar (Murcia, Spain)
+34 968 17 81 65
comercial@camposeven.com

Yearly Turnover: 35.000.000 € products.

THADER CIEZA S.C.L.
Ctra. Madrid – Cartagena km 342.
30530 Cieza (Murcia, Spain)

+34 968 76 16 50
Yearly Turnover: 25.000.000 €
Main Product: Paraguayas & nectarine.
AGRÍCOLA SANTA EULALIA S.L.
Manager: Francisco Mula Alcaraz
+34 968 42 51 31
Yearly Turnover: 30.000.000 €
LA VEGA DE CIEZA
Chairman: Pascual Hortelano
+34 968 45 57 79
Yearly Turnover: 24.500.000 €
ADHESIVOS DEL SEGURA S.A.
Manager: José Pablo Carrasco García
Apdo. de correos nº 6. 30500 Molina de Segura (Murcia, Spain)
+34 968 38 95 95
Yearly Turnover: 22.487.445 €
Main Product: Tags.
FRUTAS APEMAR S.L.
(Murcia, Spain)
+34 968 37 94 90
Yearly Turnover: 22.208.874 €
SUBASTA DEL SURESTE S.L.
Manager: Francisco García Herrero
(Murcia, Spain)
+34 968 58 08 80
Yearly Turnover: 18.293.826 €
Main Product: Artichoke, broccoli, peppers and melon.
AGROLITO
Manager: Emmanuel Leconte
30708 El Jimenado (Murcia, Spain)
+34 968 587 587
Yearly Turnover: 18.000.000 €
Main Product: Lettuce and baby leaves.
O.P. LOOIJE S.L.
Manager: Jacqueline Looije
30880 Águilas (Murcia, Spain)
+34 968 43 92 87
www.looije.es
Yearly Turnover: 18.000.000 €
Main Product: Cherry tomato, baby plum and black cherry.
MOLINENSE PRODUCCIONES NATURALES S.L.
Ctra. Venta del Olivo – Calasparra km 33,5. 30420 Calasparra (Murcia, Spain)
Yearly Turnover: 10.000.000 €
HACIENDA DEL MOLINO S.L.
Manager: Jesús Zapata
+34 968 19 00 48
Yearly Turnover: 9.795.115 €
Main Product: Lemon and orange.
AGRIDEMUR MARKETING S.L.

(Murcia, Spain)
+34 968 58 75 87
GRUPO HORTOFRUTÍCOLA MURCIANA DE VEGETALES, S.L.
Fuente Álamo (Murcia, Spain)
+34 968 15 12 22
www.ghmurcianadevegetales.com
correo@ghmurcianadevegetales.com

Yearly Turnover: 22.000.000 €
Main Product: Romaine lettuce, mini romaine, little gem,
FRUVEG S.COOP.


(Murcia, Spain)
+34 968 58 55 95
Yearly Turnover: 17.000.000 €
EXPLOTACIONES AGRARIAS PUERTO EXPORT S.A.
30890 Puerto Lumbreras (Murcia, Spain)
+34 968 40 08 48
Yearly Turnover: 15.781.477 €
Main Product: Lettuce and broccoli.
AGRÍCOLA EL REGAOR S.L.
Molina de Segura (Murcia, Spain)
+34 968 69 43 83
GRUPO HORTIBERIA S.A
Manager: José María Morote Marco
Beaza. 30353 Cartagena (Murcia, Spain)
+34 968 32 16 20
Yearly Turnover: 20.000.000 €
Main Product: Fruits and vegetables.
HORTOFRUTÍCOLA TOPI S.A.
Manager: Antonio Caballero
+34 968 45 15 36
Yearly Turnover: 20.000.000 €
Yearly Turnover: 15.000.000 €
Main Product: Garlic, onion and lemon.
COOP. HORTOFRUTÍCOLA CAMPOS DE JUMILLA SCL
Manager: Juan José Arenas García
+34 968 78 01 14
www.camposdejumilla.com
Yearly Turnover: 15.000.000 €
AGRIOS EL CARRIL S.L.
Camino Almazara, 3. 30140 Santomera (Murcia, Spain)
+34 968 27 70 71
Yearly Turnover: 14.000.000 €
Main Product: Citrus.
FRUTAS LA CARRICHOSA S.C.L.
Chairman: Antonio Bernal Barba
HISPA GROUP Manager: Ginés García Benzal

+34 968 35 58 18
Yearly Turnover: 19.600.000 €
+34 968 43 42 48
Yearly Turnover: 14.000.000 €
Main Product: Apricot and seedless grapes.
HORTOFORTINI ESPAÑA SLU
Manager: Fabio Fortini
+34 968 55 91 95
Yearly Turnover: 12.000.000 €
Yearly Turnover: 9.000.000 €
RITEC - RIEGOS Y TECNOLOGÍAS S.L.
Manager: Luis Miguel Peregrín
30880 Águilas (Murcia, Spain)
+34 968 44 60 00
Yearly Turnover: 6.000.000 €
greenhouses.
HORTALIZAS SAN LUIS S.COOP
Manager: Luis Jiménez Moya
Ctra. Nueva, 22. 30800 Lorca (Murcia, Spain)
+34 968 48 15 59
www.luisjimenezsl.es
luis@luisjimenezsl.es
Yearly Turnover: 5.917.830 €
Main Product: Vegetables.
S.A.T. CAMPOTEJAR DEL SEGURA
Manager: Manuel Pay Ponce
Ctra. Fortuna km 7.
+34 968 62 96 70
satcampotejar@satcampotejar.com
Yearly Turnover: 5.315.318 €
Main Product: Lemon, nectarine, peach, orange, tangerine, plus apricots and plums.






FRUTAS TORERO S.A.
Manager: Antonio Caballero
+34 968 77 07 91
Yearly Turnover: 5.308.142 €
POLIEXMUR S.L.
30169 San Ginés (Murcia, Spain)
+34 968 88 03 97
www.poliex.es
Yearly Turnover: 5.190.071 €
EARMUR, S.L.
Consultant: José Luis Albacete Viudes
30833 Sangonera La Verde (Murcia, Spain) +34 968 86 91 42 www.earmur.com
Yearly Turnover: 5.000.000 €
Star Ruby.
SEMILLEROS DEITANA, S.L.
Manager: José Luis Galera
+34 968 42 35 05
Yearly Turnover: 4.500.000 €
FRUTAS CAMPO DE BLANCA, S.C.A.
President: Elisa Martínez Torres
Commercial Manager: Felicia Pascalau (Murcia, Spain)
+34 968 77 60 63
Yearly Turnover: 4.000.000 €
JOSÉ GUILLÉN E HIJOS, S.L.
Manager: Francisco José Guillén
+34 968 62 23 11
Yearly Turnover: 3.108.024 €
Main Product: Logistics.
UP FRESH
Ctra. Cayetano km 1. 30739 El Mirador San Javier (Murcia, Spain)
+34 968 17 45 10
Yearly Turnover: 2.850.155 €
Main Product: Vegetables.
GUIVER FRUITS, S.L.
+34 617 43 77 29
Yearly Turnover: 2.792.080 €
Main Product: Aromatic herbs, oriental vegs, vegetables, tropical,
TALLERES BELANDO OLMOS, S.L.
Manager: José Belando Olmos
30011 Murcia (Spain)
+34 968 87 44 22
Yearly Turnover: 1.030.155 €
Main Product: Transport.
CIAGRI, S.C.L.
MULTIGESTION EN AGRO SERVICIOS, S.L.
+34 968 22 38 33 lazaro@cayserpatatas.com
Main Product: Potato.
MUNDOSOL QUALITY, S.L.
Manager: Antonio Pujante Marcos
+34 966 77 97 99
SAT MOYCA N 9857 (Murcia, Spain)
+34 968 42 38 38
SEMILLEROS PLANTIAGRO S.L.
Manager: Florentina García García Ctra. Granada, 110. Apdo. de correos 89. 30890 Puerto Lumbreras (Murcia, Spain)
+34 968 40 14 56
Main Product: Seedbed.
SYMBORG
Chairman: Jesús Juarez
30100 Murcia (Spain)
+34 968 89 92 50
VEGETALES LÍNEA VERDE NAVARRA, S.A.
Manager: Lorenzo Pileri Ctra. Corella, km 3. 31500 Tudela (Navarra, Spain)


+34 948 84 74 08
Yearly Turnover: 200.000.000 €
meals.
FLORETTE IBÉRICA
Yearly Turnover: 192.000.000 €
JESÚS AGORRETA BAIGORRI, S.L.
Manager: Jesús Agorreta Baigorri
+34 948 82 79 72
Yearly Turnover: 2.699.818 €
BERLIN EXPORT INTERNATIONAL S.L.
Manager: José Miguel Ortiz Oses
+34 948 41 38 17
Yearly Turnover: 1.051.482 €
Main Product: Fertilizers.
ROSARIO MARÍN BARASOAIN, S.L.
Manager: José Charral Ruiz La Cerradilla, nº 11. 31589 Sartaguda (Navarra, Spain)
+34 948 66 20 00 verdunat@verdunat.com
Yearly Turnover: 600.000 €
Main Product: Borage.
IMPROFORT, S.L.
+34 948 23 46 86
Main Product: Tubes and protective meses.
ULMA AGRÍCOLA
Manager: Aitor Ayestury
+34 943 10 71 07
Yearly Turnover: 88.839.000 €
UDAPA S.COOP (Álava, Spain)
+34 945 29 03 95
Yearly Turnover: 51.850.000 €
Main Product: Potato.
GRUPO CELULOSAS MOLDEADAS, S.L.
Manager: Erlantz Abaitua
Autonomía 2. 48291 Atxondo (Vizcaya, Spain) +34946231717
Yearly Turnover: 50.000.000 €
COMPENSA
Manager: Pedro Pablo Madrid Pérez
Avda. de Murcia, 76. 30591 Balsicas (Murcia, Spain)
+34 868 18 26 95
Main Product: Fruit quality control and cost control.

FRUTAS ANABELLA
Chairman: Fausto Carrillo
+34 968 77 04 75
Main Product: Peach, nectarine, plum and pear.
KEEP COOL
Ctra. del Llano 6, nave 2 (La Serreta). 30509 Molina de Segura (Murcia, Spain)
+34 868 86 35 26
PLANASA

CEO: Michael Brinkmann
+34 948 86 77 00
Yearly Turnover: 150.000.000 €
Main Product: Strawberry, raspberry, blueberry and blac kberry plants, asparagus and garlic seeds, and endive, blackberry.
VIDECART, S.A.
Manager: Jorge Beschinsky
+34 948 16 83 46
Yearly Turnover: 32.268.000 €
Main Product: Packaging.
GUMENDI (GUMIEL Y MENDIA, S.L.
Yearly Turnover: 18.000.000 €
ALAVESA DE PATATAS, S.A.
Manager: Jesús Andrés Lecuona Armentía
+34 945 40 04 29 alavesadepatatas@alavesadepatatas.com
Yearly Turnover: 1.911.103 €
Main Product: Potato.
NUESTRA SEÑORA DE OCÓN S.COOP.
Ctra. Santa Cruz, 34. 01118 Bernedo (Álava, Spain)
+34 945 37 80 12
Main Product: Potato.
URBASO, S.L.
Chairman: Manuel Martínez
Paseo del Arenal, 5. 48005 Bilbao (Vizcaya, Spain)
+34 944 79 48 89
A.P.R.O.C.O.A
Chairman: Miguel del Pino Nieto
+34 607 55 55 82
Main Product: Garlic.
AFRUCAT
+34 973 22 01 49
AFRUEX
+34 924 30 42 00
AILIMPO
+34 968 21 66 19
ALCACHOFA VEGA BAJA DEL SEGURA (MARCA)
Manager: Antonio Ángel Hurtado
+34 639 693 828
Main Product: Artichoke (second producers and main exporters
ANAPE. ASOCIACIÓN NACIONAL DE POLIESTIRENO EXPANDIDO
+34 913 14 08 07
APOEXPA
+34 968 20 49 49
AREFLH
General Secretary: Pauline Panegos Min de Brienne. 110 Quai de Paludate, BP 26. 33800 Bordeaux (France)
+33 (0) 5 33 89
ASOC. CITRICULTORES DE LA PROVINCIA DE HUELVA
Chairman: Lorenzo Reyes Rubiales
+34 959 39 07 52
Main Product: Citrus.
ASOC. DE PRODUCTORES DE PATATA DE SIEMBRA DE ESPAÑA
+34 947 04 02 66
Main Product: Potato seeds.
ASOC. ESPAÑOLA DE COSECHEROS EXPORTADORES DE CEBOLLA (ACEC)


Pl. Conde de Carlet, 3. 46003 Valencia (Spain)
+34 963 51 74 09
Main Product: Onion.
ASOC. ESPAÑOLA DEL KAKI
ASOC. PARA LA PROMOCIÓN DEL CONSUMO DE FRUTAS Y HORTALIZAS '5 AL DÍA'

Manager: Nuria Martínez Barea
Madrid (Spain)
Main Service: Fruit and vegetables promotion.
ASOC. PARA LA PROMOCION Y DEFENSA DE LA PATATA DE LA PROVINCIA DE BURGOS
+34 947 04 02 66
Main Product: Consumer potato.
ASOC. PROMOCIÓN DE LA PERA DE RINCÓN DE SOTO
Chairman: Eduardo Pérez Malo
consejo@perasderincondesoto.com
Yearly Turnover: 8.000.000 €
ASOC. PROFESIONAL CITRÍCOLA PALMANARANJA
Chairman: Antonio Carmona
+34 957 64 40 34
Main Product: Citrus.
ASOC. + BRÓCOLI
+34 627 84 15 14
Main Product: Broccoli.
ASOCIAFRUIT


Chairman: Luis Marín
+34 954 42 42 98 and plants, etc.
ASOMAFRUT
Norte. 28053 Madrid (Spain)
+34 917 85 32 11
Main Product: Fruits and vegetables association.
C.R.D.E. ESPÁRRAGO DE HUÉTOR TÁJAR
+34 958 33 34 43 www.esparragodehuetortajar.com esparragodehuetortajar@andaluciajunta.es Yearly Turnover: 600.000 € and canned.
C.R.D.O.P. ALCACHOFA DE BENICARLÓ
origin. Fresh product.
C.R.D.O. CEREZA DEL JERTE
Chairman: Clara Vanessa Prieto Prieto
+34 927 47 11 01
Main Product: Picota del Jerte. Cherry.
C.R.D.O. KAKI RIBERA DEL XÚQUER
Chairman: Cirilo Arnandis
+34 962 99 77 02
Yearly Turnover: 100.000.000 €
C.R.D.O. MANZANA REINETA DEL BIERZO
+34 987 56 27 13 www.manzanareinetadelbierzo.es
Main Product: Reineta del Bierzo apple.
C.R.D.O. MELOCOTÓN DE CALANDA
Chairman: Samuel Sancho (Teruel, Spain)
+34 978 83 56 93 www.melocotondecalanda.com
C.R.D.O. UVA DE MESA EMBOLSADA VINALOPÓ
Main Product: Grapes.
C.R.I.G.P. CEREZAS DE LA MONTAÑA DE ALICANTE
Chairman: Marcos Simon García (Alicante, Spain)
+34 966 40 66 40
Main Product: Cherry.
C.R.I.G.P. ESPÁRRAGO DE NAVARRA
Chairman: Marcelino Etayo Andueza Avda. Serapio Huici, 22. 31610 Villava (Navarra, Spain) +34 948 01 30 45 www.reynogourmet.com
Main Product: White asparagus.
C.R.I.G.P. DEL MELÓN DE TORRE PACHECO
30700 Torre Pacheco (Murcia, Spain) +34 968 576 634 igp.melon@torrepacheco.es
Main Product: Melon.
C.R.I.G.P. TOMATE LA CAÑADA
Ctra. de Ronda, nº 11, bajo. 04004 Almería (Spain) +34 637 71 08 01 www.elprimertomate.com igp@elprimertomate.com
Main Product: Tomato.
C.R.I.G.P. PATACA DE GALICIA
+34 988 46 26 50
COEXPHAL
Ctra. Ronda, 11, 1º. 04004 Almería (Spain) +34 950 62 11 62

Main Product: Fruits and vegetables.

COMITÉ DE GESTIÓN DE CÍTRICOS
Monjas de Santa Catalina 8, 4º. 46002 Valencia (Spain)
+34 963 52 11 02 comite@citricos.org
Main Product: Citrus.
CONSELL REGULADOR I.G.P. PATATES DE PRADES
Chairman: Carme Mestrich
+34 977 86 81 78
Main Product: Potato de Prades.
D.O.P GRANADA MOLLAR DE ELCHE
Chairman: Francisco Oliva
03290 Elche (Alicante, Spain)
+34 633 11 12 28
seed variety).
D.O.P. PERA DE JUMILLA
30520 Jumilla (Murcia, Spain)
+34 968 71 62 67 peradejumilla@gmail.com
Main Product: Pear.
ECOHAL GRANADA (Asociación Empresarios Comercializadores Hortofrutícolas de Granada)
+34 958 83 41 93
ECOVALIA
Chairman: Álvaro Barrera
+34 955 01 89 61
Main Product: Ecological agriculture services.
EXCOFRUT. Asoc. Profesional de Frutas y Hortalizas de Huesca
Chairman: Jordi Mora Badía
+34 974 47 17 00
Main Product: Peach, nectarine, paraguaya, pear, apple, apricot,
FRESHUELVA
21001 Huelva (Spain) +34 959 24 88 22
Main Product: Berries.
HORTIESPAÑA (Spanish Inter-Branch Association of Fruits and Vegetables)
+34 662 38 80 55
Main Product: Tomato, pepper, cucumber, courgette, aubergine, melon and watermelon grown in greenhouses.
I.G.P. AJO MORADO DE LAS PEDROÑERAS
Chairman: María José Arellano García
+34 967 13 93 33
I.G.P. CÍTRICOS VALENCIANOS
Manager: José Enrique Sanz
+34 963 15 40 52
+34 972 78 08 16 de Girona
INTERCITRUS. Interprofesional Citrícola Española
Chairman: Enrique Bellés Llopis
www.intercitrus.org direccion@intercitrus.org intercitrus@intercitrus.org
Main Product: Citrus.
MARCA DE GARANTÍA PERA CONFERENCIA DEL BIERZO
+34 987 56 27 13
NEIKER (INSTITUTO VASCO DE INVESTIGACIÓN Y DESARROLLO AGRARIO)
Arkaute (Álava, Spain)
+34 945 12 13 13
PROEXPORT
Ronda Levante, 1. Entlo. 30008 Murcia (Spain) +34 968 27 17 79
Main Product: Fruits and vegetables.
RED ANDALUZA DE SEMILLAS CULTIVANDO BIODIVERSIDAD-RAS
Manager: Alonso Navarro Chaves
41015 Sevilla (Spain)
+34 954 40 64 23 www.redandaluzadesemillas.org
Main Product: Seeds.
SERVICIO CERTIFICACIÓN CAAE SLU
41013 Sevilla (Spain)
+34 955 01 89 68
UNIQ
+34 670 76 19 92
Main Product: Corrugated cardboard, packaging and quality seal.
LANDGARD Obst & Gemüse Holding Gmbh


Managers: Oliver Mans (CEO), Carsten Böhnig, Michael
+49 785 1870 116
Yearly Turnover: 900.000.000 €
tomatoes, vegetables, lettuces, cabbages, berries, aspara

VOG COOP. SOC. AGR General
Manager: Walter Pardatscher
+39 0471 256 700
Yearly Turnover: 442.521.000 €
Main Product: Apples.
BLUE WHALE SAS

Chairman: Christophe Belloc
Cedex (France)
+33 563 21 56 56
Yearly Turnover: 310.000.000 €
Main Product: Apple, pear, kiwi and plum.
CONSORZIO MELINDA SCA
Chairman: Ernesto Seppi
+39 0463 67 11 11 melinda@melinda.it
Yearly Turnover: 250.000.000 €
Main Product: Apples.
ILIP
Chairman: Riccardo Pianesani
Yearly Turnover: 200.000.000 €
Main Product: Fresh produce packaging.
SORMA GROUP
CEO: Andrea Mercadini
+39 0547 31 20 55
Yearly Turnover: 180.000.000 €
SPECIAL FRUIT
Manager: Bert Barmans
+32 331 706 60
Europastraat, 36. 2321 Meer (Belgium)
Yearly Turnover: 168.000.000 €
Main Product: Berries, asparagus, exotics and avocados.
UNION DES GROUPEMENTS DE PRODUCTEURS DE BANANES DE GUADELOUPE ET MARTÍNIQUE
1 rue de la Corderie, Centra 365. 94596 Rungis Cedex (France)
+33 1 56 70 69 00 www.bananeguadeloupemartinique.com service.commercial@ugpban.com
Yearly Turnover: 127.000.000 €
RK GROWERS
Manager: Carlo Lingua y Paolo Carissimo
+39 0175 21 86 35
Yearly Turnover: 75.000.000 €
Main Product: Grapes, apples, berries, kiwis, cherries and citrus.
ALEXPORT
Chairman: Alexander Visser
Nieuwland Parc 121 AE. 2952 Alblasserdam (Holland)
+31 180 69 79 79
Yearly Turnover: 69.000.000 €
ne, watermelon, yellow melon, tangerine, orange, etc.
I.G.P. POMA DE GIRONA
Manager: Jaume Armengol Bosch
FERREIRA DA SILVA, S.A.
Chairman: Vitor Fonseca
+35 1 261 980 350
Yearly Turnover: 40.000.000 €
Main Product: Rocha Pear.
COOPERATIVA LA TRENTINA, S.C.A
+39 0461 1756000
Yearly Turnover: 35.000.000 €
Main Product: Apple brands La Trentina.
PRIMLAND
45, Chemin de Peyrelongue. 40300 Labatut (France)
+33 558 90 09 95
Yearly Turnover: 35.000.000 €
Main Product: Kiwi, baby kiwi and apple.
ULMER GmbH & Co.KG
+49 7851 93980
ladny@ulmerdirekt.de
Yearly Turnover: 30.000.000 €
Main Product: Vegetables.

S.A. VERACRUZ
Yearly Turnover: 20.000.000 $
Main Product: Fresh lemons, concentraded lemon juice, cold pres sed lemon oils and other by products.
JINGOLD SPA
Chairman: Patrizio Neri
+39 0547317476
Yearly Turnover: 12.000.000 €
Main Product: Kiwi.
AVI srl
Manager: Carlo Lingua y Paolo Carissimo
+39 0803 96 31 92
Yearly Turnover: 2.000.000 €
Main Product: Seedless grapes.
HORTAIBERICA, IDA
Chairman: Paulo Martins
+351 25 26 45 253
www.hortaiberica.com
Yearly Turnover: 2.000.000 €
Main Product: Lettuce, tomato.
AGROFRESH DEUTSCHLAND GmbH
Main Product: SmartFresh, Freshcloud technologies, VitaFresh
AGROFRESH ITALIA S.r.l
+39 051 70 13 98
Main Product: SmartFresh, Freshcloud technologies, VitaFresh
AGROFRESH POLSKA Sp. Z o.o. Al
Main Product: SmartFresh, Freshcloud technologies, VitaFresh
Lamouthe 47, 290 Cancon (France)
+33 5 53 01 45 00
Main Product: Hazelnuts and walnuts.
CORA SEEDS SRL
CEO: Maurizio Bacchi
+39 0547 38 51 66
Main Product: Vegetable seeds.
DIXELL Srl (EMERSON CARGO SOLUTIONS in EUROPE)
+39 0437 9833
me monitoring with temperature shipment data insights and real time alerts. Monitoring.
DRISCOLL’S OF EUROPE, MIDDLE EAST AND AFRICA
Bijster 26. 4817 HX Breda (The Netherlands)
+31 (0) 85 0217 457
Main Product: Berries.
ASF EDITION

Executive Manager: Aurélie Ferrieux
+33 468 37 88 80
Regal’in, Ondine).
ASOCIACIÓN PINK LADY EUROPA
436, Avenue Charles de Gaulle. 84100 Orange (France) +33 490 119180 contact@pinkladyeurope.com
Main Product: Pink Lady Apples.
BAYARD DISTRIBUTION
12, Rue de la Justice. 80700 Laucourt (France)
+33 (0) 3 22 87 00 34
Main Product: Potatoes.
CHILEAN FRESH FRUIT ASSOCIATION
Chairman: Ronald Bown Cruz del Sur, 133. Piso 2 Las Condes. Santiago (Chile)
+56 2 472 4734
CMR FRANCE (PERPIGNAN)
66033 Perpignan (France)
+33 0468 68 00 00
CMR FRANCE (RUNGIS)
94626 Rungis Cedex (París, France)
+33 787 698 552
CMR HOLLAND
+31 88 055 10 00
45, Michalakopoulou str115 28. Athens (Greece)
Main Product: SmartFresh, Freshcloud technologies, VitaFresh
AGROFRESH HOLDING FRANCE SASU
+33 1 85 78 77 8
Main Product: SmartFresh, Freshcloud technologies, VitaFresh
CMR MAROC Bd. Zerktouni et Massira. 20100 Casablanca (Morocco)
CMR PORTUGAL Estrada da Quinta dos Conegos, 2580 465 Carregado (Portugal) +351 968 702 421
COOPERATIVE UNICOQUE
DYNAPLAST
BP 128, rue Just Meisonasse. 89600 Saint Florentin (France)
+33 386 43 81 00
www.dynaplast.com
Main Product: Plastic packaging.
EKLAND MARKETING CO. OF CALIFORNIA (EMCO CAL)
Chairman: Patrick H. Ballew, Gabriela Paiva
+1 813 756 6604
Main Product: Strawberry, blackberry, raspberry, blueberry and citrus varieties.
ENZA ZADEN
Manager: Jaap Mazereeuw
+31 228 35 01 00
www.enzazaden.com
Main Product: Horticultural seeds, tomato, pepper, cucumber,
ESCANDE PLANTS
Manager: Benoît Escande
France
+33 553 71 22 13
pears and plums.
FRESH FORWARD BREEDING & MARKETING
Hoge Woerd 1c. 6851 ET Huissen (Netherlands)
+31 (0) 263 886 448
Main Product: Strawberry breeding.
GEORGES HELFER S.A.
+41 22 999 99 99
GLOBALG.A.P. c/o FoodPLUS GmbH
ORTOMEC srl
Main Product: Vegetable seeds.
TOZER SEEDS
INTER PORTUGAL
Pct. Eng. José Herculano Brito de Carvalho, nº 5.
+351 913 894 820
Main Product: Potato.
ISI SEMENTI SPA
+39 0524 52 84 39
endive, squash, pepper, melon and watermelon.
MCAIRLAID´S VLIESSTOFFE GMBH www.mcairlaids.com




MILLER CHEMICAL & FERTILIZERS, LLC








+1 717 632 89 21
Millerplex, Vapor Gard.
PERFOTEC B.V.
Chairman: Bas Groeneweg Klompenmakersweg 16, 3449JB Woerden (Holland)
+34 968 596 309
Main Product: Leeks, celery, parsnips, salad onions.
UNITEC S.P.A. General
Manager: Angelo Benedetti
+39 0545 288 884
VI.P VAL VENOSTA Coop. Soc. Agrícola
CEO: Martin Pinzger
Main Product: Apples.
WILKOFRUIT B.V. IABC
+31 765 24 4 55
PRINCE DE BRETAGNE 8, Rue Marcelin Berthelot.
+33 298 62 11 55
leek, endives, salads, organic vegetables.
REV PACKAGING SOLUTIONS
Chairman: Fabrizio Fiumana
+39 0547 384 435
MULDER ONIONS BV

Manager: Gerard Hoekman
Hagenroderstraat, 32. 6464 CP Kerkrade (Netherlands)
+31 455 67 87 00
goo), potatoes, carrots, garlic and cabbage.
NESPAK INBALLAGGI
+39 545 97 97 97
Main Product: Plastic packaging.
NOVA SIRI GENETICS S.R.L.
Manager: Carmela Suriano
+39 342 843 7577
Main Product: Strawberries varieties.
Main Product: Packaging solutions.
SAINT-CHARLES EXPORT
+33 298 62 11 55 www.public.saintcharlesinternational.com and vegetables.






SER.MAC
+39 0547 415193 getables.
TOKITA SEEDS S.R.L
+39 0543 75 61 43











AGUACATES Y MANGOS CON EL MEJOR SABOR









